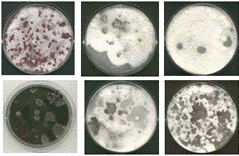
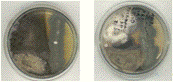

Почвенные микроорганизмы-антагонисты, активные в отношении фитопатогенных грибов р. Fusarium и р. Bipolaris
Введение
Защита растений от вредных организмов является
исключительно актуальной проблемой повышения урожайности сельскохозяйственных
культур. Среди методов и средств защиты растений преобладающим остается
химический, так как обладает быстротой и наглядностью действия, надежностью и
эффективностью в широком диапазоне внешних факторов. Однако не лишен он и ряда
недостатков, основными из которых являются нарушение биологического равновесия
в природе, накопление остаточных количеств химических средств защиты в
сельскохозяйственной продукции и прогрессирующей к ним устойчивости патогенных
организмов, высокая стоимость фунгицидов и катастрофическое загрязнение
окружающей среды. Для создания альтернативных химическим методам защиты
растений от болезней проводится интенсивный поиск бактерий и грибов, способных
служить агентами биологического контроля развития болезней. Микроорганизмы
представляют продукт живой природы; размноженные в искусственных условиях для
защиты растений, они легко вписываются в экологическую систему, практически не
нарушая ее целостности. Продукция, обработанная биологическими средствами,
безопасна для здоровья человека, пчел и теплокровных животных.
Все вышесказанное как нельзя лучше обуславливает
актуальность выбранной темы магистерской диссертации.
Цель работы: выделить почвенные
микроорганизмы-антагонисты, активные в отношении фитопатогенных грибов р. Fusarium
и р. Bipolaris.
Для достижения поставленной цели решаются
следующие задачи:
. Провести скрининг почвенных грибов,
проявляющих антагонистическую активность в отношении фитопатогенных грибов р. Fusarium
и р. Bipolaris.
. Провести скрининг почвенных бактерий,
проявляющих антагонистическую активность в отношении фитопатогенных грибов р. Fusarium
и р. Bipolaris.
. Провести количественную оценку антибиотической
активности выделенных микроорганизмов-антагонистов.
. Провести сравнительный анализ антибиотической
активности выделенных изолятов в отношении грибов р. Bipolaris
и различных штаммов р. Fusarium.
. Провести сравнительный анализ антибиотической
активности изолятов, выделенных из различных почв, отобранных в разных местах.
почвенный
гриб бактерия фитопатогенный
1. Обзор литературы
.1 История развития биологической защиты
растений
Первым шагом в развитии практического биометода
было применение американскими энтамологами в конце XIX
века в Калифорнии хищного жука Rodolia
cardinalis
Muls. для борьбы с
австралийским желобчатым червецом Iceria
purchasi
Mask., ставшим угрозой
процветающей цитрусовой промышленности США. Успешные опыты с родолией
стимулировали исследования в области биологической защиты как в США, так и в
других странах, в том числе России.
Микробиометод первоночально был разработан для
борьбы с вредными насекомыми [40]. Это было обусловлено, в частности, тем, что
длительная эпизоотия шелковичного червя разорила многих шелководов и нанесла
миллиардные убытки стране. В 1865 году Пастер выявил, что причиной болезни
шелкопряда являются микробы, и они поражают организм на всех стадиях развития
[120].
Впервые явление антагонизма было отмечено в 1877
году Л. Пастером, когда в одном из опытов в питательную среду, где выращивалась
культура возбудителя сибирской язвы, из воздуха попали микробы и быстро
размножились, а культура бацилл исчезла. Единственным объяснением могло быть
предположение, что сибиреязвенные бациллы были уничтожены микробами из воздуха.
Врагами палочки сибирской язвы, как показали последующие опыты, оказались
гнилостные бактерии - синегнойные палочки. Л. Пастер охаректиризовал это
явление как «борьбу за существование между сибиреязвенным организмом и его
сородичами» [90, 120].
Работы Пастера вызвали большой интерес у
российского ученого И. И. Мечникова в начальный период его деятельности [15]. В
1879 году Мечников впервые обосновал перспективы использования микроорганизмов
для борьбы с вредными насекомыми на примере энтомопатогенного гриба Metarrihizium
anisopliae
Metsch. [40].
Исследования в области биологической защиты
растений приняли систематический характер после организации в 1927 г. в
Ленинграде (Санкт-Петербурге) Всесоюзного научно-исследовательского института
защиты растений (ВИЗР).
В СССР систематическое изучение антагонизма как
природного явления и создание научной основы его теории начались в 50-х годах
нашего столетия советскими учеными (Н. А. Красильников, М. И. Нахимовская, А.
И. Кореняко и др.) [90].
Изучение физиологических функций
микробов-антагонистов Н. А. Красильников начал уже в 30-40-е годы; с 50-х годов
он сосредоточил свое внимание на разработке принципов и методов использования
антибиотиков в растениеводстве.
До начала работ Н. А. Красильникова уже был
накоплен определенный запас знаний о явлении микробного антагонизма [29]. О
первых успешных результатах в этом направлении сообщил в 1924 г. Ч. Портер
[156], затем Р. Бамберг [130] и Кисслинг [146], которые использовали
таксономически неидентифицированные бактериальные культуры для борьбы с
заболеваниями сельскохозяйственных культур.
Первые успешные результаты по практическому
применению идентифицированных микробов-антагонистов в нашей стране были достигнуты
уже в 30-е годы в отделе почвенной микробиологии Института микробиологии,
которым в те годы руководил Д. М. Новогрудский. Инициатором этих исследований
был Я. П. Худяков, работами которого была создана теоретическая основа нового
направления. Важное значение имели его опыты по инфицированию семян пшеницы
бактериями рода Pseudomonas,
оказавшимися способными лизировать патогенные грибы [29]. Эти бактерии Худяков
назвал «миколитическими» [111].
Идеи Я. П. Худякова получили подтверждение в
работах Е. Ф. Березовой и А. Н. Наумовой [8], а Д. М. Новогрудский провел серию
экспериментальных работ, в которых названые идеи получили широкое развитие. В
1936 г. Новогрудский впервые ввел термин «бактерии-антагонисты» [80].
Первые указания на наличие антагонистических
свойств у актиномицетов появились в работе Р. Грейг-Смита, опубликованной в
1918 году. Автор описывал угнетение актиномицетами роста грибов и бактерий.
Этот эффект он приписал конкуренции микроорганизмов за источники питания [140].
Более конкретные данные о способности актиномицетов лизировать живые и мертвые
клетки бактерий привел Д. Лиске [148].
Первые в нашей стране систематические
исследования антагонистических свойств актиномицетов провела М. И. Нахимовская
под руководством Д. М. Новогрудского. В 1937 она опубликовала работу, в которой
представила обширный список тестобактерий, при воздействии на которые
проявилось угнетающее действии актиномицетов, описала методы тестирования и т.
д. [75]. Эти исследования осуществлялись под руководством Н. А. Красильникова.
В 1939 г. М. И. Нахимовская уже представила обширную классификацию форм
антагонистических взаимодействий микробов, выявленных ею [76].
В связи с этим следует сказать, что к началу
40-х годов уже имелся определенный запас знаний об антагонистических
взаимодействиях микробов, используемых в практических целях. Но работы в этой
области носили преимущественно эмпирический характер [29]. Н. А. Красильников
характеризовал достигнутый уровень работ в этом направлении лишь как
«Заманчивую перспективу в борьбе с грибковыми поражениями растений» [54].
К середине 40-х годов Н. А. Красильников
разработал новую концепцию дальнейших исследований данной проблемы [29]. Н. А.
Красильников обосновал возможность использования жизнедеятельных культур
микробов-антагонистов для борьбы с возбудителями заболеваний растений, который
сводился к отрицании внутривидового и утверждению существования лишь
межвидового антагонизма [56]. Внедряя в растениеводство бактериологический
способ защиты растений, тем самым он предлагал до минимума свести обработку
полей ядохимикатами. Однако пропаганда Красильниковым этого метода совпала с
началом широкого распространения химического метода защиты растений,
последствия которого вскоре оказались очень серьезными [29].
В 1939 г. швейцарским ученым Паулем Мюллером
были открыты инсектицидные свойства ДДТ. Когда этот препарат и созданные позже
другие стойкие хлорорганические инсектициды получили в 40-60-е годы широкое
распространение, методы биологического контроля стали считаться бесперспективными
или малоэффективными. Тем не менее и в это время они продолжали развиваться.
Однако вскоре восторги по использованию ДДТ и других стойких хлорорганических
инсектицидов сменились глубоким разочарованием, поскольку последствия их
применения оказались очень серьезными. После опубликования в США книги Рейчел
Карсон «Безмолвная весна» (1962 г.), внимание широкой общественности
по-настоящему было привлечено к вопросам охраны окружающей среды. Острейшие
проблемы, возникшие в результате применения стойких хлорорганических
пестицидов, дали новый стимул исследованиям по созданию альтернативных методов
регулирования численности вредных организмов, как за рубежом, так и в нашей
стране [16, 40].
Большой вклад в развитие микробиологического
метода защиты растений внесли сибирские ученые. В 1950 г. при Иркутском
государственном университете организована лаборатория под руководством Е. В.
Талалаева. Здесь разработан препарат дендробациллин на основе энтомопатогенной
бациллы Bacillus
dendrolimus, впоследствии
отнесенной к Bacillus
thuringiensis
subsp. dendrolimus.
В 1959 г. в Биологическом институте СО АН СССР (ныне Институт систематики и
экологии животных, Новосибирск) была создана лаборатория по изучению болезней
насекомых, в которой работали известные ученые - доктора наук В. И. Полтев, А.
Б. Гукасян, В. В. Гулий. Здесь разработаны вирусные препараты против ряда
вредителей леса.
В 1962 г. в Красноярском крае в очагах
размножения сибирского шелкопряда А. Б. Гукасян выделил бациллу B.
Insectus, впоследствии
отнесенную к B. thuringiensis
subsp. thuringiensis
[15, 28]. На основе выделенного штамма был создан препарат инсектин.
Впоследствии и дендробациллин, и инсектин начали использовать на
сельскохозяйственных культурах. В Красноярском государственном университете в
70-е годы ХХ в. были начаты работы по изучению энтомопатогенов и
микробов-антагонистов возбудителей болезней растений [15].
Естественных врагов возбудителей болезней
растений стали использовать значительно позже, чем регуляторов численности
вредителей. Первый отечественный биопрепарат против корневых гнилей триходермин
разработан в конце 60-х гг. в ВИЗР под руководством Н. С. Федоринчика на основе
Т. viride (lignorum)
(Fr.) Реrs.
Фунгицидным действием обладает антибиотик трихотецин, метаболизируемый грибом Тrichothecim
roseum Link.
Этот препарат разработан во ВНИИбакпрепарат (Москва) под руководством М. Т.
Петрухиной. Только в 80-е годы XX в. разработка биопрепаратов против болезней
растений стала более интенсивной благодаря использованию такихантагонистических
микроорганизмов как, бактерии рода Рseudomonas
(Р. fluorescens
Mig, Р. auerofaciens
Kluyver), Bacillus
subtilis
Ehrenberg и др. Это
препараты ризоплан (впоследствии планриз), бацифит (впоследствии бактофит) и
др. [15, 40].
Для координации работ в области биологической
защиты растений в 1970 г. был создан Всесоюзный научно-исследовательский
институт биологических методов защиты растений в Кишиневе (ныне Молдавский НИИ
биометодов). После распада СССР в 90-е годы ХХ в. организован Всероссийский НИИ
биологической защиты растений в Краснодаре.
Необходимость объединения усилий ученых всего
мира по разработке биологических методов подавления вредных видов привела к
созданию в 1971 г. Международной организации по биологической борьбе с вредными
организмами (МОББ). Цель этой организации - способствовать международному
сотрудничеству в области развития биологических средств защиты растений,
проведения научных исследований, пропаганды биологических методов защиты
растений на национальном и международном уровнях. В состав организации и ее
региональных секций входит более 70 стран [15, 19].
Начавшийся в 90-е годы прошлого века общий
кризис экономики и аграрного сектора негативно сказался и на биологической
защите растений. Тем не менее, вскоре снова наметилась тенденция возрастания
роли биологических методов в общей системе интегрированной защиты растений,
возникла новая идеология биологической защиты, адаптированная к региональным
условиям, основанная на использовании расширяющегося ассортимента биологических
средств защиты растений и сохранении природных регуляторов численности вредных
видов. Особенность современного этапа развития биологической защиты растений -
расширение сети региональных государственных биолабораторий и коммерческих
фирм, которые обеспечивают и производство, и применение биологических средств
защиты растений, объединяя специалистов, развивающих и производственные, и
исследовательские аспекты биологической защиты растений [16].
.2 Характеристика возбудителей корневых гнилей
зерновых
Возбудители корневых гнилей злаков относятся к
классам высших грибов и характеризуются различными паразитическими свойствами.
В Сибири главная роль принадлежит грибам р. Bipolaris
и р. Fusarium,
которые относятся к классу несовершенных грибов (Fungi
imperfecti или Deuteromycetec),
порядка Hyphomycetales.
[49, 50, 81, 110, 115, 118].
Наибольшее распространение корневые гнили
приобрели в Сибири, где наиболее благоприятные условия для их жизнедеятельности
[98, 99, 118]. В Красноярском крае главная роль принадлежит грибам Bipolaris
sorokiniana (Sacc.)
Shoemaker. и видам рода Fusarium
[112].
Грибы р. Bipolaris
преобладают в Сибири - в зонах степи, южной лесостепи, в северной лесостепи
(засушливые годы), в Казахстане, Зауралье, Поволжье, где расположены основные
массивы посевов яровой пшеницы и ячменя [116]. Ежегодные потери от обыкновенной
корневой гнили в данных регионах составляют 15-20%, а в засушливые годы - до
50% урожая [22, 51, 118].
Виды рода Fusarium
широко распространены в Сибири - зонах тайги, подтайги, северной лесостепи
(увлажненные годы), в Прибалтике, Белоруссии, Нечерноземной зоне,
Ставропольском крае [116].
В Красноярском крае наиболее частая
встречаемость заболевания отмечается в районах, расположенных в зоне тайги и
подтайги равнины (Большемуртинский, Бирилюсский, Большеулуйский, Козульский,
Пировский, Тюхтетский). В условиях резких температурных колебаний весеннего
периода, а также влажной осени, фузариоз усиливается в районах Каннской, Чулымо
- Енисейской, Красноярской лесостепей [112].
Фитоэкспертиза семян (1996-2004 гг.)
свидетельствует, что в основных районах производства зерна в России
инфицированность зерновых культур грибами р. Fusarium
link составила 5-25 %
(в ряде проб 30-60%), р. Bipolaris
sp. - 11-37 % (в ряде
проб 50-60 %) [1].
Отмечено, что на пшенице паразитируют 28 видов
рода Fusarium.
В условиях Сибири их 11 видов. К наиболее распространенным относятся: F.
gibbosum
Appel et
Wr. Emend.
Bilai, F. oxysporum Schlecht., F. sambucinum
Fckl., F. avenaceum (Fr.) Sacc., F. sporotrichiella Wr. Emend. Bilai, F. solani
(Mart.) Appel et Wr., F. graminearum Schwabe [20, 118, 121]. Исследования
Чулкиой В. А. (1985) свидетельствуют о некоторой приуроченности F.
oxysporum и F.
graminearum к теплым районам
(степь), а F. avenaceum
- к холодным (подтайга).
На искусственных питательных средах грибы р. Bipolaris
образуют многоклеточный субстратный и воздушный мицелий от белого до
оливково-черного цвета. Размножение осуществляется с помощью веретеновидных
многоядерных конидий размером 40-120 х 15-30 мкм [34, 149], которые образуются
на обособленных ответвлениях гиф - конидиеносцах апикально. Конидии имеют
толстую оболочку, от светло-коричневого до темно-бурого цвета, большей частью
удлиненно-яйцевидные, правильной или неправильной формы, без перегородок или,
чаще, имеют их от 8 до 13 [116, 118, 166].
Гриб развивается в диапазоне температуры от 0 до
плюс 40ºС.
Интенсивный рост мицелия и спорообразование происходят при температуре от плюс
22 до плюс 28ºС и влажности
воздуха 90%, отчленение конидий - при низкой относительной влажности воздуха
(22%) и замедляется при высокой. Такие условия являются обычными в период
вегетации яровых зерновых культур, что благоприятствует накоплению конидий и
распространению их воздушными течениями. В случае попадания на листья или
другие надземные органы растения они прорастают при наличии капельно-жидкой
влаги или при относительной влажности воздуха выше 80%. Оптимальная температура
для их прорастания от плюс 24 до плюс 28ºС,
минимальная плюс 6ºС,
максимальная плюс 36ºС [51, 82,
101, 116, 164]. Конидии Bipolaris
sorokiniana не теряют
жизнеспособности в течении нескольких месяцев при температуре от минус 32 до
минус 43ºС
и даже минус 50ºС, поэтому
они хорошо переносят суровые сибирские зимы [102, 127].
Грибы рода Fusarium
размножаются микро- и макроконидиями Микроконидии большей частью одноклеточные,
образуются на воздушном мицелии в ложных головках или цепочках [116].
Микроконидии иногда образуются путем почкования макроконидий [12].
Макроконидии многоклеточные,
веретеновидно-серповидной формы [116]. Они образуются в воздушном мицелии на
простых или разветвленных конидиеносцах, иногда на коротких отростках или
выступах гиф, в спородохиях и пионнотах. Спородохии представляют собой
скопление разветвленных или простых конидиеосцев на сплетении гиф, образующих в
виде слизи макроконидии. У пионнотов слизистый слой макроконидий образуется на
таких же конидиеносцах, отходящих более или менее сплошным слоем от
субстратного мицелия или в виде слизистых, в последствии сливающихся бугорков
на воздушном мицелии.
Хламидоспоры являются наименее
дифференцированными органами вегетативного размножения грибов рода Fusarium.
Хламидоспоры отличаются от остальных клеток мицелия более толстой оболочкой,
иногда двойной, гладкой, шиповатой или мелкобугорчатой, большим диаметром по сравнению
с остальными клетками гиф мицелия и большей частью круглой формой. Хламидоспоры
могут образовываться в гифах мицелия (промежуточные) в виде различной длины
цепочек или клубочков, а также на концах гиф (верхушечные) одиночно, в виде
коротких цепочек или собранные в клубочки (узлы). Они играют роль в биологии
видов, их выживаемости, способствующие длительному сохранению их семенах, почве
или на растительных остатках [12].
Мицелий фузариев разнообразен, его
дифференциация проявляется у разных видов в зависимости от условий
культивирования и возраста культуры, чаще белый, бело-розовый, розово-сиреневый
или бурый. Воздушный и субстратный мицелий различаются толщиной, длиной клеток,
степенью вакуолизации и образования хламидоспорного типа клеток. Клетки гиф
субстратного мицелия обычно более широкие, чем воздушного. Диморфизм -
превращение мицелиального типа роста в дрожжеподобный, и наоборот, -
свойственен многим видам Fusarium.
Эти изменения мицелия имеют приспособительный характер и являются реакцией на определенные
условия среды [12, 13].
Фузарии как и грибы р. Bipolaris
- мезофиллы, оптимум температуры для развития которых лежит в пределах от плюс
18 до плюс 28ºС [43], хотя
некоторые из них, особенно фитопатогенные виды, могут расти и развиваться в
пределах от 0 до плюс 35ºС [12]. При
этом рост мицелия в длину, прорастание конидий и образование спороношения
разных видов фузариев происходит при разных температурах. Так, исследования
показали, что рост мицелия четырех видов фузариумов (F.
nivale, F.
rubiginosum, F.
metachroum, F.
subulatum) отмечен при
температуре от плюс22 до плюс 26ºС.
Установлено значительное влияние температуры на морфологию гиф гриба F.
graminearum. У F.
avenaceum при температуре
плюс 15ºС
и выше отмечено образование анастомозов. А для гриба F.
solanum, у которого
максимум накопления биомассы отмечен при температуре от плюс 20 до плюс 28ºС,
а минимум от плюс 12 до плюс 14ºС.
Накопление биомассы у гриба F.
oxysporum, наоборот,
наиболее высокое при пониженных положительных температурах от плюс 12 и плюс
20ºС
[43].
Влажность почвы оказывает большое влияние на
выживаемость в ней патогенов. Виды рода Fusarium
лучше сохраняли жизнеспособность в почве при влажности 15-25% от полной
влагоемкости (ПВ) и погибали в случае превышения этой величины. В условиях
контролируемой влажности почвы самое слабое развитие болезни было при
увлажнении ее в пределах 60% от ПВ [118].
Границы кислотности и щелочности для видов
фузариум колеблются в широких пределах. Большинство видов фузариум способны
расти и развиваться в довольно широкой амплитуде значений рН среды от 2 до 9 с
оптимумом в пределах рН 3,5-5,0 [43, 105].
Существенным фактором в экологии, особенно
фитопатогенных видов фузариев, является углекислота. Кислород и углекислота
необходимы им для вегетативного роста, спорообразования, прорастания конидий и
направленности биохимических процессов. При этом разные виды по-разному
реагируют на эти факторы. Например, F.
oxysporum высоко резистентен
к пониженному содержанию кислорода в атмосфере и в таких условиях может
выживать очень долго. Эта особенность вида имеет значение для выживания гриба и
распространении его в почве. Отдельные виды фузариум проявляют значительную
устойчивость к давлению кислорода [43]. Например, вид F.
solani выдерживал
давление кислорода до 10 атмосфер [12].
При определении зон локализации патогенов
обнаружено, что растения ярового ячменя поражаются корневыми гнилями постоянно,
зоны патогенного влияния на которых поделены между грибами: зерновка и
первичные корни поражены в основном грибами р. Bipolaris;
вторичные корни и междоузлия инфицированы грибами р. Fusarium.
Видимо, это связано с тем, что данные возбудители болезней занимают разные
экологические ниши в окружающей среде, поэтому не происходит конфронтации между
ними, в связи с чем корневые гнили являются комплексным заболеванием [97].
По способу питания возбудители обыкновенной
корневой гнили являются необлигатными паразитами с широким кругом хозяев. Так,
грибы р. Bipolaris
способны паразитировать более чем на 100 видах растений, как однодольных, так и
двудольных, однако основными хозяевами являются дикорастущие и культурные злаки
[25, 31, 116]. Хорошо усваивают как органические, так и минеральные формы
азота, способны к длительному росту и споруляции на растительных остатках.
Благодаря большому запасу питательных веществ
конидии могут прорастать и формировать мицелий в отсутствии экзогенных
источников питания [6, 31]. Способность грибов р. Bipolaris
к свободному существованию ограничена из-за конкуренции с почвенной
микрофлорой. По некоторым сведениям, вытеснение патогена из пораженных органов
происходит еще в период вегетации растения [53]. Тем не менее, в благоприятных
условиях гриб сохраняется в почве в виде конидий и хламидоспор, а также в форме
мицелия на растительных остатках в течение многих месяцев и даже лет [7].
Болезнь на растениях различными симптомами
проявляется в течении всей вегетации - от всходов до уборки. Симптомы
заболевания очень разнообразны и зависят от способа и места внедрения патогена,
а также от условий протекания инфекционного процесса и устойчивости растения к
заболеванию. Наиболее часто грибы р. Bipolaris
поражает надземные и подземные органы растения в месте контакта воздух-земля.
Источником инфекции служат находящиеся в почве конидии, а также мицелий, сохраняющийся
на растительных остатках. В первую очередь происходит заражение первичных
корней, колеоптиля и прикорневых листьев, после чего инфекция может
распространиться на эпикотиль, вторичные корни, стебель и узел кущения.
Впоследствии наблюдается побурение и отмирание пораженных органов. В результате
инфекции происходит нарушение связи в системе корень-стебель, что ведет к
снижению оттока питательных веществ к зерну и как следствие - уменьшению
скорости созревания и потерям урожая.
В течение вегетационного периода при наличии
достаточной влажности происходит споруляция гриба на пораженных органах
растения. Попадая на листья, конидии во влажных условиях прорастают и вызывают
заболевание, называемое пятнистостью листьев. Характер повреждения зависит от
внешних условий и чувствительности растения к заболеванию. При благоприятных
для возбудителя условиях - высокой влажности и температуре - болезнь
проявляется в виде некрозов, окруженных обширными хлорозами. При
неблагоприятных для развития инфекции условиях наблюдаются мелкие компактные
некрозы в местах внедрения патогена, хлорозы отсутствуют [24, 51, 53, 86, 100,
103, 117, 133, 143, 136].
При попадании конидий патогена на колос
происходит заражение семян, что приводит к появлению семенной инфекции и
развитию заболевания, известного как "черный зародыш" зерновых [24,
84, 119]. Такой путь передачи возбудителя считается наиболее вредоносным,
поскольку ведет к наибольшим потерям урожая. Семенная инфекция вызывает
снижение полевой всхожести на 14-66% за счет гибели проростков на ранних этапах
вегетации, а также значительное уменьшение скорости роста и продуктивности
выживших растений [116]. В связи с этим посев нужно проводить семенами высокого
класса [93].
Заболевания, вызываемые различными видами
фузарий, включают поражение наземной и корневой части растения. В наземной
части растения фузарии вызывают главным образом гнили стебля, поражения
репродуктивных органов растения, зерна. Из заболеваний корневой системы
наиболее вредоносны фузариозы всходов, корневые гнили. Проявление характерных
симптомов заболевания при разных типах фузариозов растений зависит от
физиологического состояния растения, степени его устойчивости, величины
инфекционной нагрузки, специфической физиологической активности возбудителя
(быстроты роста, образования токсинов, ферментов и т. д.). [12].
Цепь поражения состоит из следующих звеньев:
фузариозное зерно + инфицированные пожнивные остатки + падалица - фузариозная
корневая гниль - гибель проростков - фронтальная колонизация растений +
аэрогенная инфекция - фузариоз колоса - фузариозное ядовитое зерно [106].
Существует два основных пути инфицирования
растений. При семенной инфекции во время прорастания зараженных зерен начинает
расти и находящаяся в них грибница, которая быстро переходит в корешки и проростки,
в результате развивается корневая гниль всходов.
Когда фактором передачи возбудителя являются
почва и растительные остатки, конидии грибов прорастают под влиянием корневых
выделений растений - экссудатов, которые служат источниками питательных веществ
и энергии, необходимой для проникновения гриба в растение [43].
Было выяснено, что под влиянием корневых
выделений растений-хозяев прорастает только часть покоящихся пропагул гриба.
При повторной волне прорастания пропагул шанс попадания их в экологическую нишу
- ткани растений-хозяев возрастает. Благодаря этому, популяция избегает гибели
значительной части своих особей при неблагоприятных условиях в период
прорастания, данная способность возбудителя является ценным эволюционным
признаком, повышающим выживаемость его в природе [93].
Таким образом, обыкновенная корневая гниль
зерновых поражает практически все органы растения. Наибольшие потери урожая от
заболевания наблюдаются в засушливые годы. При этом отмечают взаимное усиление
повреждающего действия засухи и возбудителя обыкновенной корневой гнили. Можно
предположить, что ослабление растения за счет осмотического и теплового стресса
облегчает его колонизацию патогеном. Высказываются также предположения о
сходном механизме действия засухи и патогена на растительный организм. Так,
отмечено сходство физиологических и биохимических изменений в растениях при
засухе и при поражении обыкновенной корневой гнилью [45, 87, 88].
Патогенность грибов р. Bipolaris
и р. Fusarium
тесно связана с их способностью продуцировать фитотоксины. Фитотоксины - это
продукты метаболизма патогенных микроорганизмов, которые могут вызывать
повреждения тканей растений и играть значительную роль в патогенезе [78].
Микотоксины оказывают влияние на интенсивность
дыхания, снижают фотосинтетическою активность, нарушают азотный и углеводный
обмен, повреждают клеточные мембраны, ингибируют репликацию митохондриальной
ДНК, вызывают нарушение митотического цикла в меристемах, что служит причинами
задержки роста и развития пораженных растений или их гибели [10, 12, 37].
В настоящее время известно семь токсинов,
продуцируемых разными видами грибов р. Helminthosporium.
Из них четыре хозяин-специфические (продуцируются грибами, которые являются
строго специализированными или поражают узкий круг растений-хозяев, и токсичны
только для хозяев этих видов грибов): викторин, Т-, НС- и НS-токсины.
И три неспецифические (токсичны для многих растений, независимо от того,
является ли это растение хозяином продуцирующего токсин микроорганизма):
гельминтоспораль, офиоболины и карботоксин.
Викторин продуцируется грибом Н. victoriae
- возбудителем гельминтоспориоза овса, ячменя, ржи, риса и фасоли. Болезнь
поражает в первую очередь проростки и стебли. Кроме того, гриб вызывает
корневую гниль овса, ячменя и ржи [78]. Викторин - первый хорошо изученный
токсин, который выделен из культуральной жидкости гриба еще в 1957 г. [157].
Токсин повреждает ультраструктуру мембран хлоропластов, ядер, вакуолей,
эндоплазматического ретикулума [142]. Изолированный токсин, подобно Н. victoriae,
вызывает в организме растения-хозяина разнообразные изменения: быструю потерю
электролитов, нарушение дыхания и фиксации СО2 в темноте, подавление синтеза
белка и ингибирование роста, торможения процессов поглощения веществ [141].
Т-токсины продуцирует гриб Н. maydis,
вызывающий заболевание - южный гельминтоспориоз. Известны две расы:
высоковирулентная раса Т, продуцирующая токсин, и раса О, которая токсин не
продуцирует и не обладает высокой вирулентностью. Раса Т поражает только
гибриды кукурузы с техасской (Т) цитоплазматической мужской стерильностью. Она
вызывает некрозы листьев, листовых влагалищ, оберток початка и серо-черную
гниль початков [161]. Т-токсины специфически действуют на проницаемость мембран
клеток кукурузы с Т-цитоплазмой. Они индуцируют разнообразные реакции, такие
как утечка ионов, ингибирование роста и закрывание устьиц [150].
НС-токсин выделен из культурального фильтрата Н.
carbonum, возбудителя
гельминтоспориозной пятнистости листьев кукурузы. Выделенный токсин учеными R.
Pringle, R.
Scheffer (1967) в
концентрации 0,5 мкг/мл подавлял рост корней восприимчивых сортов кукурузы на
50%; на устойчивые сорта он оказывал подобное действие в концентрации 50
мкг/мл. При более низких концентрациях токсин стимулировал рост корней восприимчивых
сортов.
НS-токсин
(гельминтоспорозид). Возбудитель, продуцирующий данный токсин - Н. sacchari.
Вызывает глазковую пятнистость листьев сахарного тростника, вызывает
образование пятен в форме глаза, от которых распространяются длинные красно-коричневые
полосы [78].
Гельминтоспораль. Н. sativum
- один из возбудителей корневой гнили, пятнистости листьев, сажистого налета на
колосьях и «черного зародыша» семян пшеницы, ячменя и других злаков. Данный
токсин ингибирует электронный транспорт между флавопротеином и цитохромом
"С" в хлоропластах и митохондриях, нарушает проницаемость мембран,
ингибирует окислительное фосфорилирование, окисление сукцината и
а-кетоглутарата, подавляет синтез белков и нуклеиновых кислот, а также синтез
а-амилазы, снижает активность АТФ-азы. На макроуровне действие гельминтоспорала
и его производных проявляется в ингибировании прорастания семян, роста
проростков и каллусных культур восприимчивых растений. Токсичность очищенных
препаратов, выраженная в концентрации, снижающей на 50% рост центрального корня
у проростков пшеницы, колеблется от 4 мкг/мг для гельминтоспорала до 50-80
мкг/мг для его производных.
Из японского изолята гриба было выделено
вещество, несколько отличающееся от гельминтоспорала и получившее название
гельминтоспорол. Гельминтоспорол способен ускорять рост растений. На всходы
риса и огурца он действует подобно гибберелловой кислоте, но в высоких
концентрациях угнетает развитие корней и проростков пшеницы и салата [78, 89,
108, 109, 126, 132, 159, 160, 138].
Офиоболины (А-F)
представляют группу хозяин-специфичных токсинов, продуцируемых различными
видами рода Helminthosporium.
Офиоболин А продуцируется Н. oryzae,
H. turcicum,
H. leersii,
H. zizaniae,
H. heterostrophus
и др. Офиоболин В выделен из H.
zizaniae, H.
heterostrophus, Н. oryzae.
Предполагается, что токсины изменяют проницаемость мембран клеток растений:
через 10 мин. после обработки токсином наблюдалось увеличение вытекания
электролитов и растворов, содержащих углеводы, в листьях и корнях риса [78].
Карботоксин продуцируется грибом Н. carbonum.
Чистый токсин в концентрации 25 мкг/мл подавлял рост корней проростков кукурузы
и был одинаково токсичен как для восприимчивых, так и для устойчивых сортов
[158].
Из культур р. Fusarium
были выделены и всесторонне изучены многочисленные фитотоксины. Микотоксины
фузариев обычно не являются характерными для определенного вида [78].
Продуцентами фузариевой кислоты являются многие
штаммы видов: F. oxysporum,
F. solani,
F. moniliforme,
F. heterosporum,F.
subglutinans, F.
sambucinum, F.
napiforme, F.
crookwellense. Фузариевая
кислота образуется преимущественно в культуральной жидкости; проявляет
токсикоорганотропное действие различной степени в зависимости от дозы и вида
растения [11, 74, 129].
Микомаразмин - токсин, образующийся при
культивировании штаммов F.
oxysporum, а также in
vivo в пораженных
грибом растениях. Токсин обладает специфическим действием на ткань листьев
между жилками, вызывая некрозы, нарушает полупроницаемость плазматических
мембран и водный баланс растения.
Нафтазарины - производные нафтахинонов:
фузарубин, яваницин, мартицин, изомартицин, норяваницин и новарубин - являются
характерными метаболитами F.
javanicum, F.
solani, F.
martii var.
pisi. Токсины
образуются в ростовом субстрате и пораженных растениях; нарушают проницаемость
плазматических мембран и разрушают хлоропласты [155].
Монилиформин - продуцируется F.
moniliforme и F.
fusariudes. В концентрации 20
мкг/мл он подавляет рост колеоптилей пшеницы на 24 % [78].
Группу опасных токсинов представляют
трихотецины, особенно принадлежащие к типу А (Т-2 токсин, НТ-2 токсин,
неозоланиол (НЕО), диацетоксицирпенол), синтезируемые F.
sporotrichioides и F.
poae, а также к типу В
(деоксиниваленол (ДОН) и его производные - ниваленол, фузаринон-Х),
продуцируемые F. graminearum
и F. culmorum
[135]. Особую опасность вызывает нарастающее загрязнение зерна пшеницы новыми
для нашей страны опасными канцерогенными микотоксинами фумонизинами при
поражении растений F. moniliforme.
В России за последние 5 лет оно увеличилось с 10 до 75% [73].
Интоксикация сельскохозяйственных продуктов,
вызванная фузариозом, может стать причиной отравления людей и животных.
Фузариозные зерна пшеницы называются «пьяным хлебом», т. е. они на столько
ядовиты, что человек, поевший такой хлеб, под влиянием нервного расстройства не
может устоять на ногах, падая как пьяный. Основным источником инфекции «пьяный
хлеб» являются семена, в которые проникает возбудитель фузариоза, находящийся
на поверхности [9, 10, 14, 23, 30, 43]. Причина заболевания - гриб F.
graminearum и некоторые
близкие к нему виды (например, F.
avenaceum и F.
nival). Они развиваются
на хлебных злаках еще в поле. Заражение озимых происходит от инфекции,
находящейся в почве в мицелии или на остатках растений в виде мицелия, конидий
или сумкоспор в перитециях [37].
Обобщая изложенный материал, можно сказать, что
за последние годы накоплен обширный материал о возбудителях корневых гнилей
злаковых культур: изучены распространение, биология, вредоносность,
систематика, а также меры борьбы с этими болезнями. В последние годы, в связи с
возрастающими требованиями к защите окружающей среды и экологической чистоте
получаемой продукции, наиболее приемлем биологический метод в борьбе с
корневыми гнилями злаковых культур, основанный на поиске антагонистов,
подавляющих своих конкурентов.
1.3 Использование микробного антагонизма в
защите зерновых культур
Известно, что болезни растений, в том числе
зерновых культур, распространены широко и причиняют существенный вред сельскому
хозяйству. Для борьбы с ними используют химический метод [35]. Еще 20 лет назад
внимание уделяли преимущественно его положительным качествам: быстрота и
наглядность действия, надежность и эффективность в широком диапазоне внешних
факторов среды. В последующие годы стали видны и ощутимы отрицательные стороны
его применения [18, 19]. Борьба с фитопатогенами, и в первую очередь грибными,
в настоящее время осуществляется преимущественно с использованием фунгицидов
[26]. Появление на рынке новых химических фунгицидов принципиально не меняет
общую ситуацию в защите растений от болезней [79].
Для создания альтернативных химическим методам
защиты растений от болезней проводится интенсивный поиск бактерий,
актиномицетов и грибов, способных служить агентами биологического контроля
развития болезней, и применение их в виде концентрированных продуктов
метаболизма (антибиотиков) либо живых культур.
В настоящее время разработаны некоторые
биопрепараты, созданные на основе бактерий-антагонистов (алирин Б, бактофит,
фитоспорин, ризоплан и др.), актиномицетов (фитобактериомицин, гризин,
валидомицин, касугомицин и др.) и грибов - антагонистов (трихотецин,
триходермин-БЛ, деструксин, боверицин, микоафидин-Т, вертициллин-М и др.) [15,
16, 17, 47, 69, 94, 96,].
Микробиологические средства из года в год
находят все большее применение. При их разработке основной задачей является
выделение из различных почв наиболее выносливых и часто встречающихся
сапрофитных микроорганизмов, которые в состоянии вытеснить патогенные формы с
минимальным отрицательным воздействием на окружающую среду [44, 144].
Антагонисты - наиболее перспективные и надежные
помощники человека при использовании биологического метода борьбы. В настоящее
время их изучению уделяется большое внимание [16, 43]. Поскольку фитопатогенные
грибы из р. Fusarium
и р. Bipolaris
в основном связаны с почвой, именно в ней эти возбудители чаще всего и
подавляются антагонистами [42].
.3.1 Бактерии-антагонисты
Использование бактериальных антагонистов
основано главным образом на механизме антибиоза, регулирующем взаимоотношения
полезных и вредных (с точки зрения производителя сельскохозяйственной
продукции) микроорганизмов. Антибиоз играет наиболее важную роль в зоне
ризопланы (зона ризосферы, окружающая корни и корневые волоски растении в
пределах до 100 мкм). Использование регуляторных механизмов направлено не на
полное уничтожение популяции фитопатогена, а на существенное ограничение ее
развития и снижение вредоносности. Источником получения штаммов
бактерий-антагонистов служат супрессивные почвы, в которых фитопатогены либо
угнетены, либо элиминированы [16].
Высокая антагонистическая активность по
отношению к патогенам выявлена у более десятка различных родов бактерий [39].
Среди бактерий наиболее часто явление антагонизма встречается у спороносных
палочек, принадлежащих к роду Bacillus,
и неспоровых из рода Pseudomonas.
Бактерии рода Bacillus
являются перспективными агентами защиты растений от болезней, вызываемых
фитопатогенными грибами, благодаря своей высокой приспособляемости и
выживаемости в неблагоприятных условиях [60]. Род Bacillus
объединяет большое количество видов бактериальных организмов палочковидной
формы, которые в аэробных условиях образуют одну рефрактивную эндоспору.
Образование эндоспор после фазы интенсивного вегетативного роста и размножения
как бы завершает жизненный цикл клетки, переходящий в покоящуюся форму,
способную прорастать в благоприятных для развития бактерий условиях.
Биологическое значение образование спор, по-видимому, заключается в способности
переживать неблагоприятные экстремальные условия, что создает определенные
преимущества данным микроорганизмам [77].
Одним из весьма интересных является вопрос о
возможном участии в спорогенезе специфических полипептидных структур -
антибиотиков полипептидов. Эти вещества, синтезируемые бактериями рода Bacillus
и обладающие более или менее выраженной токсичностью против микроорганизмов,
составляют большую (описано свыше сотни веществ), известных под общим названием
антибиотиков. Ряд специалистов в области биосинтеза антибиотиков высказывает
мнение, что образование этих веществ может быть тесно связано с процессами
дифференциации образующих их организмов, а также оказывает существенное влияние
на физиологические и биохимические свойства последних [5, 32, 48, 77, 128].
Бактерии рода Bacillus
синтезируют, как правило, антибиотики полипептидной природы, причем один вид и
даже штамм образует семейство близких пептидов. Так, в культурах Bacillus
subtilis обнаружено до 66
различных антибиотических пептидов, B.
brevis - 23. Из одного
штамма B. subtilis
№ CIB 8872,
выращиваемого на определенной среде, выделено сразу 10 антимикробных веществ.
Различные штаммы B. polimyxa
синтезируют до 20 полимиксинов, а также пептиды, близкие, но отличающиеся от
полимиксинов по составу [77].
Результаты опытов подтверждают, что Bacillus
subtilis и ее метаболиты
могут быть использованы для создания экологически безвредного биопрепарата для
семян пшеницы против F.
oxysporum [91].
S. C.
Chambers, I.
R. Millington
(1974) в своих опытах исследовали бактерии B.
subtilis. В условиях чистой
культуры на жидкой и полутвердой среде Чапека с разным содержанием углерода и
азота одновременно высевали гриб F.
culmorum и различные
бактерии, встречающиеся в ризосфере пшеницы. Установлено, что бактерии угнетают
рост гриба.
Как правило, B.
subtilis образуют на
питательной среде выпуклые колонии ризоидной формы [85]. Хорошо растет на МПА,
пептонно-кукурузном агаре и других средах. Размер клеток 0,7...0,8х2...3 мкм. В
почве бациллы находятся в виде спор, или вегетативных клеток. При температурах
почвы, близких к О°С, большая часть бацилл образует споры. Чем выше рН
(щелочные почвы), тем больше процент спор B.
subtilis. Бациллы хорошо
развиваются в ризосфере пшеницы, ячменя, кукурузы [16]. Л. Ю. Кузьмина, А. И.
Мелентьев (2003) установили, что на численность интродуцированных
бацилл-антагонистов в ризосфере пшеницы оказывают температурные условия
развития растений. Так, результаты А. И. Мелентьева (2000) показывают, что
плотность клеток B. subtilis
ИБ-15 в ризосфере пшеницы, выращиваемой при всех трех температурных режимах,
практически не изменялась на протяжении 2-3 недель, вегетации. Лишь на 16-е
сутки при температурах плюс 21 и плюс 30°С и на 21-е сутки при плюс 13ºС
отмечен достоверное увеличение плотности интродуцированных бактерий [60, 69].
Водные режимы почв оказывают большое влияние на
формирование микробного ценоза почвы и ризосферы [41]. Очевидно, при изменении
температурно-влажностных режимов почвы в ризосфере растений могут создаваться
условия как благоприятные, так и не благоприятные для активной колонизации
ризосферы интродуцируемыми культурами. Исследования Меленьева показывают, что
при недостаточном влогообеспечении (37% ПВ) плотность клеток B.
subtilis ИБ-15 в ризосфере
пшеницы поддерживалась на высоком уровне - порядка 107 КОЕ/г - и практически не
изменялась на протяжении всего эксперемента. При благоприятном влагообеспечении
растений (67% ПВ) отмечена тенденция к медленному снижению плотности клеток,
тогда как при переувлажнении почвы (100% ПВ), наоборот, происходило непрерывное
увеличение численности клеток [16].
Таким образом, для практического использования
бацилл в защите злаковых культур от болезней необходимо детальное изучение их
способности приживаться и распространяться в прикорневой зоне растений при
постоянно изменяющихся гидротермических режимах.
Среди ризосферных бактерий особое место занимают
бактерии рода Pseudomonas, проявляющих высокую антагонистическую активность по
отношению к фитопатогенным микроорганизмам [131], а также способность к
стимуляции роста сельскохозяйственных культур. Так, исследования Минаевой
(2007) показали, что обработка семян бактериями Pseudomonas sp. B-6798 и смесью
с другими ризобактериями снижает общую пораженность возбудителями семенных
инфекций на 12-36 % за счет значимого (р<0,01) уменьшения количества семян
пораженных гельминтоспориозно-фузариозными возбудителями корневых гнилей.
Показано, что под действием бактерий Pseudomonas sp. B-6798 в лабораторных
тестах происходит увеличение длины проростка в зоне бактериального концентрационного
оптимума в 1,5-3,5 раза, сухой биомассы - 1,5-5 раз, количества корней второго
порядка (для кукурузы) и суммарной длины корневой системы (для пшеницы и овса)
- 1,7-3,0 раза и 1,5-3,6 раза соответственно. В полевых экспериментах выявлена
стимуляция роста и развития растений под действием бактерий Pseudomonas sp.
B-6798 как в монокультуре, так в смешанной культуре с другими ризобактериями в
1,1-2,9 раз относительно контроля, которая наиболее отчетливо проявляется на
начальных этапах их развития.
В СССР исследования в этом направлении были
начаты Я. П. Худяковым (1935), который выделил бактерии рода Pseudomonas,
лизирующие F. graminearum,
F. lini
для предохранения льна и пшеницы от заболевания фузариозом [111] Эти
микроорганизмы с успехом были использованы в широких полевых опытах для борьбы
с фузариозом разных полевых культур [72, 95].
Из окрашенных веществ, синтезируемых бактериями
рода Pseudomonas,
были выделены химические вещества, обладающие антибиотическими свойствами, -
пиоцианин, хлорорафин, оксихлорорафин, феназин-1-карбоновая кислота и
эругинозин. Все перечисленные пигменты обладают антибиотической активностью
против фитопатогенных грибов [36, 152].
Важную роль в ограничении численности
фитопатогенных микроорганизмов играют синтезируемые псевдомонадами сидерофоры -
соединения, осуществляющие транспорт железа. Их отличительная способность -
образование стабильных комплексов с трехвалентным железом. Связывая ионы
трехвалентного железа в почве, сидерофоры лишают многие виды фитопатогенных
грибов необходимого элемента питания, что приводит к остановке развития
последних. К сидерофорам относится псевдобактин (пиовердин), полученный из
разных видов Pseudomonas.
Установлено, что подавление прорастания хламидоспор Fusarium
oxysporum сидерофорами
происходит при концентрации железа в почве 10‾²²...10-27М.
Препараты на основе сидерофоров (псевдобактин, агробактин и др.) не только
снижают численность популяции патогенов, но и стимулируют рост растений [95,
16, 125].
Кроме антибиотиков, бактерии рода Pseudomonas
синтезируют витамины. Советские и зарубежные исследователи еще в 30-х годах
нашего столетия отмечали, что в состав желто-зеленого флуоресцирующего
пигмента, синтезируемого псевдомонадами, входят рибофлавин, фолиевая кислота,
птерин [36].
В настоящее время имеются сведения об
антагонистической активности бактерий р. Mycobacterium. Так, в исследованиях
Н.В. Козловской, И.О. Обгольцевой, Е.П. Яковлевой (1998) обнаружено, что
бактерии р. Mycobacterium обладают антагонистической активностью в отношении
фитопатогенного гриба Fusarium solani, выделенного из стебля огурца [46]. Ю. М.
Возняковская и О. Г. Широков (1962) обнаружили антагонистическое действие M.
Mucosum и M.
Globiform на Botrytis
cinerea [2]. Сведения об
антагонистической активности этих бактерий в отношении фитопатогенов в
литературе крайне ограничены Учитывая высокую антагонистическую активность
различных видов микобактерий, при более тщательном изучении возможно
обнаружение среди них высокоактивных в отношении фитопатогенов штаммов,
синтезирующих антибиотики [46]. Кроме того, микобактерии прекрасно развиваются
в почве с минимальной влажностью, при температуре, которая задерживает рост
фитопатогенных грибов [36].
.3.2 Актиномицеты-антагонисты
Впервые о возможности применения актиномицетов и
продуцируемых ими антибиотиков в растениеводстве было заявлено рядом ученых на
конференции в г. Ереване в 1958 году. Принципы использования антагонистически
активных микроорганизмов были разработаны Н. А. Красильниковым [55, 57, 58,
59].
В настоящее время среди актиномицетов выделены
штаммы, антагонистически активные в отношении возбудителей различных болезней.
Так, в Турции для биологической борьбы с некоторыми видами почвенных патогенов
рекомендована раса С/2-9 актиномицета Streptomyces
ochraceiscieroticus,
ею обрабатывают семена, рассаду, почву в целях защиты сельскохозяйственных
культур. В Великобритании S.
griseus, встречающийся на
соломенных тюках и других субстратах с соломой, на которых выращивали огурцы в
теплицах, также подавлял корневые гнили [19]. Существуют штаммы актиномицетов,
антагонистически активные в отношении фузариоза. Исследованиями М. М.
Кулдыбаева, Г. Ш. Сейкетова получен спиртовой концентрат антибиотика
актиномицета штамма 23/791 с активностью 19000-65000 ед/мл по отношению к F.
oxysporum и F.
solani [61]. Имеются
штаммы актиномицетов-антагонистов бактериоза томатов, вертициллезного увядания
хлопчатника, антракноза цитрусовых, папайи и сахарного тростника [163],
мучнистой росы огурцов [165].
Большинство исследователей свидетельствует, что
высокой антагонистической активностью обладают преимущественно представители
рода Streptomyces.
Доказана высокая эффективность использования метаболитов актиномицетов в
качестве ингибиторов роста патогенных микроорганизмов, вызывающих заболевания
сельскохозяйственных растений [104, 114, 134, 153].
Актиномицеты в процессе своей жизнедеятельности,
помимо антибиотиков, способны синтезировать витамины, аминокислоты, ауксины,
которые также применяются в растениеводстве для повышения урожайности и
стимулирования прорастания семян [36, 58; 66, 67, 113].
Одна из характерных особенностей лучистых
грибков - большая изменчивость. При наблюдении в микроскопе культур
актиномицетов можно легко обнаружить разнообразие морфологии клеток. Одни
клетки имеют однородную плазму, другие - зернистую, вакуолистую. Гифы мицелия в
отдельных участках могут выглядеть раздутыми и не окрашиваются основными
красками. В других участках гифы могут покрываться почкообразными выростами.
Величина отдельных клеток может также сильно варьировать. Можно сказать, что в
культурах нет совершенно одинаковых двух-трех клеток. Такое явление называется
полиморфизм, или возрастной изменчивостью организма.
Благодаря разнообразию своих клеток актиномицеты
имеют большую возможность приспособиться к различным условиям среды. Кроме
того, они неразборчивы в выборе пищи. Благодаря таким свойствам они широко
распространены в природе, могут легко выращиваться в лабораторных условиях.
Большинство актиномицетов растет и развивается
при температуре в пределах от плюс 25 до плюс 30ºС
(мезофиллы). Встречаются термофильные организмы с температурным оптимумом роста
от плюс 45 до плюс 60ºС.
Термотолерантные актиномицеты выдерживают нагревание до плюс 60 и плюс 70ºС
в течении часа. Наблюдается повышенная устойчивость к нагреванию у спор
мезофильных актиномицетов. Оптимальная среда для нормального роста лучистых
грибков нейтральная или слабо щелочная (рН 7-7,2).
Актиномицеты хорошо переносят высушивание. Так,
некоторые культуры актиномицетов после девятилетнего пребывания в сухом виде, в
лабораторных условиях не потеряли своей жизнеспособности.
Лучистые грибки могут развиваться при низкой
влажности субстрата. Показано, что оптимальной влажностью для актиномицетов
является 60% от ПВ. При 23-30% - преобладают над прочими микроорганизмами, а
при 8-10% остаются единственными растущими представителями почвенной микрофлоры
[36].
Следует добавить, что актиномицеты по
количественному составу и разнообразию продуцируемых антибиотиков занимают
первое место среди микроорганизмов [83]. Они являются, очевидно, самой
экологически пластичной и эволюционно продвинутой группой грибов [110].
Таким образом, можно сказать, что благодаря
своим особенностям актиномицеты могут успешно конкурировать с фитопатогенными
микроорганизмами в почве. В некоторых почвах можно обнаружить сравнительно
небольшое количество актиномицетов, но почти все они оказываются антагонистами.
В литературных источниках активно изучается
возможность использования в защите растений синергического действия
бактериальных культур на ростостимуляцию и антагонистическую активность. Ряд
авторов изучали и продемонстрировали успешные сочетания соединений нескольких
бактериальных штаммов [137, 139, 145, 147, 154, 162]. В проведенных
исследованиях показано, что наиболее эффективно развитие заболеваний
контролирует смесь, включающая большинство бактериальных видов, обитающих в
ризосфере растения-хозяина. Однако, производство препарата, содержащего в себе
большое количество бактериальных видов коммерчески не выгодно (подбор среды и
оптимальных условий для каждого вида бактерий, стабилизация готового аппарата и
т. д.), поэтому авторы данных работ приходят к выводу о том, что наиболее
оптимальным является поиск и внедрение двухкомпонентных биофунгицидов [162].
.3.3 Грибы-антагонисты
Важную роль в подавлении развития болезней
растений играют грибы-антагонисты. Среди их представителей внимание
исследователей и практиков привлекают грибы р. Trichoderma
[15, 16]. Продуцируя антибиотические вещества, они угнетают многие фитопатогены
(преимущественно почвенные - грибов из р. Fusarium,
Pythium, Phoma,
Phytophthora, Alternaria
и др.) и одновременно являются стимуляторами роста растений [59, 65, 151, 92].
Приминение грибов р. Trichoderma
давало обнадеживающие результаты в борьбе с болезнями плодовых, овощных и зерновых
культур [4, 68]. Так, исследования показали, что внесение антагониста Т. harzianum
в почву снижает численность фитопатогенных микромицетов, стимулирует рост и
развитие растений [27].
Грибы р. Trichoderma
характеризуются бесцветным мицелием, образующим белые, желтые, чаще зеленые или
темно-зеленые колонии. Конидии одноклеточные, почти шаровидные (2,5-3,7 мкм),
собраны в головки по 10-20 штук на концах разветвленных конидиеносцев. Гриб
образует шаровидные хламидоспоры размером 7,5-15 мкм. Штаммы этих грибов
устойчивы к низким температурам (выдерживают температуру от минус 2 до минус
4ºС),
оптимальное значение рH
4 - 6 [15].
В работах многих исследователей приведены факты
успешного приминения грибов-антагонистов из р. Penicillium
для подавления развития возбудителей болезней сельскохозяйственных культур.
Так, обработка семян ячменя перед посевом культуральной жидкостью грибов Penicillium
verrucosum
var. cyclopium
S., S.
et. H.
(= P. martensii)
и P. bilai
снижала поражение растений каменной головней ячменя в 2-3 раза по сравнению с
контролем; обработка семян яровой пшеницы культуральной жидкостью P.
Multicolor - в 4 раза
уменьшала поражение растений пыльной головней, а в варианте с P.
Cyclopium болезнь совсем не
развивалась [19]. P. cyclpium
принадлежит к одним из самых сильных токсинообразователей в почве. P.
nigricans образует
антигрибной антибиотик гризеофульвин, который показал хорошие результаты в
борьбе с некоторыми болезнями растений [36]. Использование продуктов обмена
веществ пенициллов далеко не исчерпано, и дальнейшие изучение, без сомнения,
откроет новые возможности их применения в борьбе с болезнями
сельскохозяйственных культур.
В последние годы круг грибных антагонистов,
используемых в защите растений, значительно расширился. Показана высокая эффективность
использования гриба Gliocladium
virens Miller
et ai.,
а также грибов р. Chaetomium
против корневых гнилей [16]. Давно выделены и испытаны на антагонистическую
активность циклические олигопептиды из Metarrhizium
anisopliae и Beauveria
bassiana (деструксин и
боверицин) [124].
Имеющиеся данные позволяют считать перспективным
использование микробного антагонизма в защите злаковых культур. В ХХI
в. биологическая защита растений должна занять лидирующее положение, что не
означает отказ от других методов. Биологический метод в сочетании с другими
средствами и приемами являются компонентами интегрированной защиты растений,
способной решить задачу сохранения как урожая, так и природной среды.
2. Объекты и методы исследования
.1 Объекты исследования
В качестве тест-объектов исследования были
использованы пять штаммов фитопатогенных грибов р. Fusarium,
предоставленных д.б.н., проф. Т.И. Громовых (рисунок 2.1 - 2.7), а также штамм
р. Bipolaris (рисунок 2.8), выделенных из пахотных почв Красноярского края.

Рисунок 2.1 - р. Fusarium
штамм T2EC
(конидиеносец) (фото автора)

Рисунок 2.2 - р. Fusarium
штамм Y7ес (мицелий) (фото
автора)

Рисунок 2.3 - р. Fusarium
штамм T13M
(конидиеносцы) (фото автора)

Рисунок 2.4 - р. Fusarium
штамм T13M
(конидии) (фото автора)

Рисунок 2.5 - р. Fusarium
штамм Z2-04 (конидии)
(фото автора)

Рисунок 2.6 - р. Fusarium
штамм TIG6 (мицелий,
конидии) (фото автора)

Рисунок 2.7 - р. Fusarium
штамм Z2-04 (конидии)
(фото автора)

Рис. 2.8 - р. Bipolaris
(конидии) (фото автора)
В качестве объектов исследования были
использованы образцы почв, взятые в районе Ветлужанки, с поля, засеянного
пшеницей Тулунская-12, садово-огородной почвы Емельяновского района и из-под
комнатных растений.
2.2 Методы исследования
Культивирование фитопатогенных грибов р. Fusarium
и р. Bipolaris,а
также выделение почвенных микроорганизмов проводили на среде Чапека следующего
состава: сахароза - 30 г/л, NaNo3
- 2 г/л, K2HPO4
- 1 г/л, MgSO4 × 7 H2O
- 0,5 г/л, KCl - 0,5 г/л, FeSO4
× 7 H2O
- 0,01 г/л, агар - 20 г/л. [3, 33].
Первичный скрининг перспективных штаммов
антагонистов проводили методом совместного культивирования (рисунок 2.9).
Рисунок 2.9 - Первичный скрининг перспективных
штаммов микроорганизмов-антагонистов фитопатогенных грибов р. Bipolaris
и р. Fusarium
Высев из почвенной суспензии осуществляли на
поверхность агаризованной среды соответствующего состава, предварительно
засеянной конидиями определенного штамма грибов р. Fusarium
и р. Bipolaris.
Рассев проводили микробиологическим шпателем последовательно в четыре чашки
Петри. Культивирование проводили в термостате при температуре плюс 28°С в
течение двух недель. В процессе культивирования отмечали бактериальные колонии,
вокруг которых наблюдалась зона отсутствия роста гриба.
Проверку антагонистической активности выделенных
изолятов проводили методом перпендикулярных штрихов (рисунок 2.10).
Выделение чистых культур проводили на среде
исходного состава методом истощающего штриха.
Количественную оценку антибиотической активности
проводили по прорастанию конидий грибов р. Fusarium и р. Bipolaris в
культуральном фильтрате выделенных микроорганизмов-антагонистов.
Фотографирование чашек проводили методом прямого
сканирования на сканере Genius
ColorPage-HR6
V2 с разрешением 300
dpi.
Рисунок 2.10 - Проверка антагонистической
активности выделенных микроорганизмов-антагонистов методом перпендикулярного
штриха
Фотографирование микроорганизмов проводили с
помощью микрофотонасадки на фотопленку Kodak-100,
а также цифрового фотоаппарата с использованием объективов х40 и х90, с
использованием фазового контраста.
Обработку фотоизображений проводили с
использованием графических редакторов Microsoft Photo Editor 3.0.2.3 и Adobe
Photoshop 7.0.
Математическую обработку результатов
исследования проводили стандартными статистическими методами с использованием
пакета анализа MS
Excel, StatSoft
Statistica 6.0, а также
оригинального программного обеспечения, разработанного С.В. Хижняком.
3. Результаты исследования
В результате предварительного скрининга из
исследуемых культур почвенных грибов для дальнейшего исследования были отобраны
четыре изолята (А-1, А-1(1), А-2, А-5), проявившие антибиотическую активность в
отношении фитопатогенных грибов как р. Fusarium
так и р. Bipolaris.
Изучение влияния культурального фильтрата
выделенных антагонистов на прорастание конидий грибов р. Fusarium
(штамм Т2ес) (приложение А) показало, что метаболиты всех штаммов антагонистов
ингибируют прорастание конидий данного штамма. Наибольший токсический эффект
проявил антагонист А-2 и А-5, наименьший - антагонист А-1(1) и А-1 (рисунок
3.1, 3.2).

Рисунок 3.1 - Влияние культурального фильтрата
антагонистов на прорастание конидий грибов р. Fusarium
(штамм Т2ес)

Рисунок 3.2 - Влияние культурального фильтрата
антагонистов на прорастание конидий грибов р. Fusarium
(штамм Т2ес). (фото автора)
Дисперсионный анализ подтвердил достоверность
ингибирующего влияния культурального фильтрата на всхожесть конидий грибов р. Fusarium
(штамм Т2ес) на уровне значимости p<0,05.
Изучение влияния культурального фильтрата
выделенных антагонистов на прорастание конидий грибов р. Fusarium
(штамм TIG6) показало,
что метаболиты всех штаммов антагонистов, также как у штамма Т2ес, ингибируют
прорастание конидий у этого штамма (TIG6).
Наибольший токсический эффект проявил антагонист А-2, наименьший - антагонист
А-1(1) (рисунок 3.3).
Дисперсионный анализ подтвердил достоверность
ингибирующего влияния культурального фильтрата на всхожесть конидий грибов р. Fusarium
(штамм TIG6) на уровне
значимости p<0,05.
Изучение влияния культурального фильтрата
выделенных антагонистов на прорастание конидий грибов р. Fusarium
(штамм Т13m) показало, что
метаболиты всех штаммов антагонистов ингибируют прорастание конидий данного
штамма. Наибольший токсический эффект проявил антагонисты А-5 и А-2, наименьшие
- антагонисты А-1(1) и А-1 (рисунок 3.4).

Рисунок 3.3 - Влияние культурального фильтрата
антагонистов на прорастание конидий грибов р. Fusarium
(штамм TIG6)

Рисунок 3.4 - Влияние культурального фильтрата
антагонистов на прорастание конидий грибов р. Fusarium
(штамм T13m)
Дисперсионный анализ подтвердил достоверность
ингибирующего влияния культурального фильтрата на всхожесть конидий грибов р. Fusarium
(штамм T13m)
на уровне значимости p<0,05.
Изучение влияния культурального фильтрата
выделенных антагонистов на прорастание конидий грибов р. Fusarium
(штамм Z2-04) показало, что
метаболиты всех штаммов антагонистов ингибируют прорастание конидий данного
штамма. Наибольший токсический эффект проявил антагонисты А-2 и А-1, наименьший
- антагонист А-1(1) (рисунок 3.5, 3.6).

Рисунок 3.5- Влияние культурального фильтрата
антагонистов на прорастание конидий грибов р. Fusarium
(штамм Z2-04)

Рисунок 3.6 - Влияние культурального фильтрата
антагонистов на прорастание конидий грибов р. Fusarium
(штамм Z2-04) (фото автора)
Дисперсионный анализ подтвердил достоверность
ингибирующего влияния культурального фильтрата на всхожесть конидий грибов р. Fusarium
(штамм Z2-04) на уровне
значимости p<0,05.
Изучение влияния культурального фильтрата
выделенных антагонистов на прорастание конидий гриба р. Bipolaris
показало, что метаболиты всех штаммов антагонистов ингибируют прорастание
конидий данного штамма. Наибольший токсический эффект проявил антагонист А-2,
наименьший - антагонист А-1(1) (рисунок 3.7).
Дисперсионный анализ подтвердил достоверность
ингибирующего влияния культурального фильтрата на всхожесть конидий гриба р. Bipolaris
на уровне значимости p<0,05.
Анализ спектра действия изучаемых антагонистов
на тест-культуры по критерию хи-квадрат (приложение Б) показал, что
чувствительность различных тест-культур к отдельным штаммам антагонистов
различается на уровне значимости р<0,001. Так, штамм А-1 проявляет
повышенную антимикробную активность в отношении тест-культур Z2-04 и TIG6 и
пониженную - в отношении T13m и гриба р. Bipolaris. Штамм А-1(1) проявляет
повышенную антимикробную активность в отношении тест-культуры T2ec и пониженную
в отношении остальных (TIG6, T13m, Z2-04, гриба р. Bipolaris). Штамм А-5 -
наиблее повышенную в отношении T2ec, повышенную в отношении гриба р. Bipolaris,
T13m, TIG6, пониженную - Z2-04. Штамм А-2 проявляет практически ко всем
исследуемым тест-культурам повышенную антимикробную активность (TIG6, T2ec,
гриб р. Bipolaris, Z2-04), кроме T13m.

Рисунок 3.7 - Влияние культурального фильтрата
антагонистов на прорастание конидий гриба р. Bipolaris
Кластерный анализ показал, что по действию на
тест-культуры (TIG6,
T13m,
Z2-04, T2ес,
гриб р. Bipolaris)
выделенные нами антагонисты разделяются на две группы. В первую группу входят
штаммы A-1 и A-1(1)
(р. Aspergillus).
Во вторую группу входят штаммы А-2 и А-5 (р. Penicilium)
(рисунок 3.8).

Рисунок 3.8 - Группировка выделенных антагонистов
по токсическому действию на тест-культуры (TIG6,
T13m,
Z2-04, T2ес,
гриб р. Bipolaris)
В целом, штаммы А-2 и А-5 обладают существенно
более высокой токсичностью для всех изученных тест-культур.
Сравнительный анализ тест-культур по
чувствительности к культуральному фильтрату изучаемых антагонистов показал, что
минимальной чувствительностью обладает штамм T13m,
наибольшей - штаммы TIG6
и Z2-04 (рисунок 3.9).

Рисунок 3.9 - Группировка тест-культур по
чувствительности к токсическому действию культурального фильтрата антагонистов
Эксперимент с разведением культурального
фильтрата антагониста А-2 (приложение В) показал, что при уменьшении его
концентрации прорастание конидий гриба р. Bipolaris
заметно увеличилось. Это говорит о том, что токсический эффект антагониста А-2
теряется при разведении его культурального фильтрата (рисунок 3.10).


Рисунок 3.10 - Влияние концентрации
культурального фильтрата антагониста А-2 на прорастание конидий гриба р. Bipolaris
Влияние концентрации культурального фильтрата
антагониста А-1 на прорастание конидий гриба р. Bipolaris
показало, что при разведении 1 : 1 число проросших конидий уменьшилось, а при
разведении 1 : 3 и 1 : 7 - значительно увеличилось. Это говорит о том, что,
возможно, данный штамм помимо токсических веществ выделяет рост-стимулирующие
вещества, котроые способсбсвуют прорастанию конидий гриба р. Bipolaris
(Рисунок 3.11).


Рисунок 3.11 - Влияние концентрации
культурального фильтрата антагониста А-1 на прорастание конидий гриба р. Bipolaris
Разведение культурального фильтрата антагониста
А-5 показало, что при разведении 1 : 1 число проросших конидий уменьшилось, а
при разведении 1 : 3 и 1 : 7 повышенное прорастание конидий гриба р. Bipolaris
(рисунок 3.12, 3.13).

Рисунок 3.12 - Влияние концентрации
культурального фильтрата антагониста А-5 на прорастание конидий гриба р. Bipolaris

Рисунок 3.13 - Конидии гриба р. Bipolaris
(сверху - в контроле; снизу - в культуральном фильтрате выделенных
грибов-антагонистов) (фото автора)
Влияние концентрации культурального фильтрата антагониста
А-1(1) на прорастание гриба р. Bipolaris
показывает, что данный антагонист слабо оказывает токсический эффект. При
разведении 1 : 1 число проросших конидий практически сравнялось с контролем
(рисунок 3.14).

Рисунок 3.14 - Влияние концентрации
культурального фильтрата антагониста А-1(1) на прорастание конидий гриба р. Bipolaris
[62, 63].
С учетом того, что многие почвенные грибы при
промышленном применении могут представлять угрозу здоровью человека, основное
внимание в работе было уделено поиску бактериальных антагонистов.
Изучение влияния культурального фильтрата
выделенных бактерий- антагонистов на прорастание конидий грибов р. Fusarium
(штамм Т2ес, TIG6, Y7ес) и гриба
р. Bipolaris показало, что из 54 протестированных нами изолятов типичных
почвенных бактерий 26 достоверно проявляют антагонистическую активность по
отношению к Bipolaris, 27 по отношению к Fusarium (TIG6), 36 по отношению к
Fusarium (Y7ес), 40 по
отношению к Fusarium (Т2ес), что подтверждается результатами статистической
обработки полученных данных (приложение Г).
Предварительная идентификация почвенных
бактерий-антагонистов показала, что большинство из них являются предствителями
группы коринеформных бактерий, в том числе - р. Arthrobacter
и р. Micobacterium,
группы актиномицетов (р. Streptomyces). Обнаружены также представители р. Bacillus
и р. Pseudomonas.
Изучение влияния культурального фильтрата
бактерий-антагонистов, выделенных с поля засеянного пшеницей Тулунская 12, на
прорастание конидий гриба р. Bipolaris показало, что наибольшую активность
проявляют изоляты: Т2, Т4, Т11. Наименее активными оказались изоляты Т7, Т8,
Т6, Т5, Т3, Т1, Т15, Т10, Т9, Т12. (рисунок. 3.15).

Рисунок 3.15 - Изучение влияния культурального
фильтрата бактерий-антагонистов, выделенных с поля засеянного пшеницей
Тулунская 12, на прорастание конидий гриба р. Bipolaris
Различия между изолятами по антагонистической
активности подтверждаются результатами дисперсионного анализа на уровне
значимости p<0,01.
Изучение влияния культурального фильтрата
бактерий-антагонистов, выделенных из садово-огородных почв Емельяновского
района, на прорастание конидий грибов р. Bipolaris показало, что наибольший
токсический эффект проявили антагонисты: Д13, Д4, Д2, Д26, Д14, Д16, Д23.
Наименее активными оказались изоляты Д1, Д15, Д18, Д21, Д20, Д17, Д22, Д25,
Д11. Культуральный фильтрат изолятов Д24, Д19, Д16 оказал стимулирующее действие
на прорастание конидий возбудителя (рисунок 3.16).

Рисунок 3.16 - Изучение влияния культурального
фильтрата бактерий-антагонистов, выделенных с садово-огородных почв
Емельяновского района, на прорастание конидий гриба р. Bipolaris
Различия между изолятами по антагонистической
активности подтверждаются результатами дисперсионного анализа на уровне
значимости p<0,01.
Изучение влияния культурального фильтрата
бактерий-антагонистов, выделенных из почвы р. Ветлужанки, на прорастание
конидий гриба р. Bipolaris показало, что наибольшую активность проявляют
изоляты: В1, В11, В5, В10, В7. Наименее активными оказались изоляты В4, В6, В9,
В12. Культуральный фильтрат изолятов В8, В3, В2 оказал стимулирующее действие
на прорастание конидий возбудителя (рисунок 3.17).

Рисунок 3.17 - Изучение влияния культурального
фильтрата бактерий-антагонистов, выделенных из почвы р. Ветлужанки, на
прорастание конидий гриба р. Bipolaris
Различия между изолятами по антагонистической
активности подтверждаются результатами дисперсионного анализа на уровне
значимости p<0,01.
Изучение влияния культурального фильтрата
бактерий-антагонистов, выделенных из почвы под комнатными растениями, на
прорастание конидий грибов р. Bipolaris показало, что наибольший токсический
эффект проявили антагонисты: Ц2, Ц7, Ц1. Наименее активными оказались изоляты
Ц3, Ц6, Ц5, Ц4, Ц8. (рисунок 3.18).

Рисунок 3.18 - Изучение влияния культурального
фильтрата бактерий-антагонистов, выделенных из почвы под комнатными растениями,
на прорастание конидий гриба р. Bipolaris
Различия между изолятами по антагонистической
активности подтверждаются результатами дисперсионного анализа на уровне
значимости p<0,01.
Изучение влияния культурального фильтрата
бактерий-антагонистов, выделенных с поля засеянного пшеницей Тулунская 12, на
прорастание конидий гриба р. Fusarium (TIG6) показало, что наибольшую
активность проявляют изоляты: Т1, Т9, Т12. Наименее активными оказались изоляты
Т8, Т6, Т5, Т3, Т2, Т15, Т16, Т10, Т11. Культуральный фильтрат изолятов Т7, Т4
оказал стимулирующее действие на прорастание конидий возбудителя (рисунок
3.19).

Рисунок 3.19 - Изучение влияния культурального фильтрата
бактерий-антагонистов, выделенных с поля засеянного пшеницей Тулунская 12, на
прорастание конидий гриба р. Fusarium (TIG6)
Различия между изолятами по антагонистической
активности подтверждаются результатами дисперсионного анализа на уровне значимости
p<0,01.
Изучение влияния культурального фильтрата
бактерий-антагонистов, выделенных с садово-огородных почв Емельяновского
района, на прорастание конидий гриба р. Fusarium (TIG6) показало, что
наибольший токсический эффект проявили антагонисты: Д 24, Д14, Д15, Д20, Д16,
Д23, Д11. Наименее активными оказались изоляты Д13, Д1, Д19, Д18, Д21, Д23,
Д16. Культуральный фильтрат изолятов Д4, Д2, Д26, Д17, Д22, Д25 оказал
стимулирующее действие на прорастание конидий возбудителя (рисунок 3.20).

Рисунок 3.20 - Изучение влияния культурального
фильтрата бактерий-антагонистов, с садово-огородных почв Емельяновского района,
на прорастание конидий гриба р. Fusarium (TIG6)
Различия между изолятами по антагонистической
активности подтверждаются результатами дисперсионного анализа на уровне
значимости p<0,01.
Изучение влияния культурального фильтрата
бактерий-антагонистов, выделенных из почвы района Ветлужанки, на прорастание
конидий гриба р. Fusarium (TIG6) показало, что наибольший токсический эффект
проявили антагонисты: В2, В4, В7, В6, В12. Наименее активными оказались изоляты
В1, В11, В9. Культуральный фильтрат изолятов В8, В3, В5, В10 оказал
стимулирующее действие на прорастание конидий возбудителя (рисунок 3.21).

Рисунок 3.21 - Изучение влияния культурального
фильтрата бактерий-антагонистов, выделенных из почвы района Ветлужанки, на
прорастание конидий гриба р. Fusarium (TIG6).
Различия между изолятами по антагонистической
активности подтверждаются результатами дисперсионного анализа на уровне
значимости p<0,01.
Изучение влияния культурального фильтрата
бактерий-антагонистов, выделенных из почвы под комнатными растениями, на
прорастание конидий гриба р. Fusarium (TIG6) показало, что наибольшую
активность проявляют изоляты: Ц7, Ц4, Ц1, Ц8. Наименее активными оказались
изоляты Ц3, Ц2, Ц7, Ц5. Культуральный фильтрат изолята Ц6 оказал стимулирующее
действие на прорастание конидий возбудителя (рисунок 3.22).

Рисунок 3.22 - Влияние культурального фильтрата
антагонистов, выделенных из почвы под комнатными растениями, на прорастание
конидий гриба р. Fusarium (TIG6)
Различия между изолятами по антагонистической
активности подтверждаются результатами дисперсионного анализа на уровне
значимости p<0,01.
Изучение влияния культурального фильтрата
бактерий-антагонистов, выделенных с поля засеянного пшеницей Тулунская 12, на
прорастание конидий гриба р. Fusarium (Y7ес) показало, что наибольшую
активность проявляют изоляты: Т8, Т6, Т3, Т1, Т4, Т15, Т9. Наименее активными
оказались изоляты Т7, Т5, Т2, Т16, Т11. Культуральный фильтрат изолята Т10
оказал стимулирующее действие на прорастание конидий возбудителя (рисунок
3.23).

Рисунок 3.23 - Изучение влияния культурального
фильтрата бактерий-антагонистов, выделенных с поля засеянного пшеницей
Тулунская 12, на прорастание конидий гриба р. Fusarium (Y7ес)
Различия между изолятами по антагонистической
активности подтверждаются результатами дисперсионного анализа на уровне
значимости p<0,01.
Изучение влияния культурального фильтрата
бактерий-антагонистов, выделенных с садово-огородных почв Емельяновского
района, на прорастание конидий гриба р. Fusarium (Y7ес) показало, что
наибольший токсический эффект проявили антагонисты: Д1, Д14, Д15, Д19, Д18,
Д17, Д16. Наименее активными оказались изоляты Д13, Д4, Д2, Д26, Д24, Д21, Д20,
Д22, Д23, Д25, Д11, Д16 (рисунок 3.24).

Рисунок 3.24 - Изучение влияния культурального
фильтрата бактерий-антагонистов, выделенных с садово-огородных почв
Емельяновского района, на прорастание конидий гриба р. Fusarium (Y7ес)
Различия между изолятами по антагонистической
активности подтверждаются результатами дисперсионного анализа на уровне
значимости p<0,01.
Изучение влияния культурального фильтрата
бактерий-антагонистов, выделенных из почвы района Ветлужанки, на прорастание
конидий гриба р. Fusarium (Y7ес) показало, что наибольший токсический эффект
проявили антагонисты: В1, В8, В2, В11, В4. Наименее активными оказались изоляты
В3, В5, В10, В6, В9, В12. Культуральный фильтрат изолята В7 оказал
стимулирующее действие на прорастание конидий возбудителя (рисунок 3.25).

Рисунок 3.25 - Изучение влияния культурального
фильтрата бактерий-антагонистов, выделенных из почвы района Ветлужанки, на
прорастание конидий гриба р. Fusarium (Y7ес)
Различия между изолятами по антагонистической
активности подтверждаются результатами дисперсионного анализа на уровне
значимости p<0,01.
Изучение влияния культурального фильтрата
бактерий-антагонистов, выделенных из почвы под комнатными растениями, на
прорастание конидий гриба р. Fusarium (Y7ес) показало, что наибольшую
активность проявляют изоляты: Ц3, Ц2, Ц7, Ц5, Ц4, Ц8. Наименее активными
оказались изоляты Ц6, Ц1 (рисунок 3.26).

Рисунок 3.26 - Изучение влияния культурального
фильтрата бактерий-антагонистов, выделенных из почвы под комнатными растениями,
на прорастание конидий гриба р. Fusarium (Y7ес)
Различия между изолятами по антагонистической
активности подтверждаются результатами дисперсионного анализа на уровне
значимости p<0,01.
Изучение влияния культурального фильтрата
бактерий-антагонистов, выделенных с поля засеянного пшеницей Тулунская 12, на
прорастание конидий гриба р. Fusarium (Т2ес) показало, что наибольшую
активность проявляют изоляты: Т1, Т3, Т4, Т10, Т9. Наименее активными оказались
изоляты Т7, Т8, Т6, Т4, Т2, Т 15, Т16, Т11, Т12. Культуральный фильтрат изолята
Т5 оказал стимулирующее действие на прорастание конидий возбудителя (рисунок
3.27).

Рисунок 3.27 - Изучение влияния культурального
фильтрата бактерий-антагонистов, выделенных с поля засеянного пшеницей
Тулунская 12, на прорастание конидий гриба р. Fusarium (Т2ес)
Различия между изолятами по антагонистической
активности подтверждаются результатами дисперсионного анализа на уровне
значимости p<0,01.
Изучение влияния культурального фильтрата
бактерий-антагонистов, выделенных с садово-огородных почв Емельяновского
района, на прорастание конидий гриба р. Fusarium (Т2ес) показало, что
наибольший токсический эффект проявили антагонисты: Д2, Д26, Д24 , Д14, Д19,
Д18, Д20, Д17, Д16, Д23, Д11. Наименее активными оказались изоляты Д13, Д4,
Д15, Д21, Д22, Д25. Культуральный фильтрат изолята Д1 оказал стимулирующее
действие на прорастание конидий возбудителя (рисунок 3.28).

Рисунок 3.28 - Изучение влияния культурального
фильтрата бактерий-антагонистов, выделенных с садово-огородных почв
Емельяновского района, на прорастание конидий гриба р. Fusarium (Т2ес)
Различия между изолятами по антагонистической
активности подтверждаются результатами дисперсионного анализа на уровне
значимости p<0,01.
Изучение влияния культурального фильтрата
бактерий-антагонистов, выделенных из почвы района Ветлужанки, на прорастание
конидий гриба р. Fusarium (Т2ес) показало, что наибольший токсический эффект
проявили антагонисты: В8, В2, В11, В4, В10, В7, В6, В9. Наименее активными
оказались изоляты В1, В3, В5, В12 (рисунок 3.29).

Рисунок 3.29 - Изучение влияния культурального
фильтрата бактерий-антагонистов, выделенных из почвы района Ветлужанки, на
прорастание конидий гриба р. Fusarium (Т2ес)
Различия между изолятами по антагонистической
активности подтверждаются результатами дисперсионного анализа на уровне
значимости p<0,01.
Изучение влияния культурального фильтрата
бактерий-антагонистов, выделенных из почвы под комнатными растениями, на
прорастание конидий гриба р. Fusarium (Т2ес) показало, что наибольшую
активность проявляют изоляты: Ц6, Ц5, Ц1, Ц8. Наименее активными оказались
изоляты Ц3, Ц2, Ц7, Ц4 (рисунок 3.30).

Рисунок 3.30 - Изучение влияния культурального
фильтрата бактерий-антагонистов, выделенных из почвы под комнатными растениями,
на прорастание конидий гриба р. Fusarium (Т2ес)
Различия между изолятами по антагонистической
активности подтверждаются результатами дисперсионного анализа на уровне
значимости p<0,01.
Для выяснения влияния места отбора почвенных
образцов на антагонистическую активность в отношении изучаемых тест-культур
была проанализирована частота встречаемости антагонистов в различных почвенных
образцах. Как видно из представленных данных, наибольшее число антагонистов,
активных в отношении грибов р. Bipolaris
выделилось из почвы, взятой с поля, засеянного пшеницей Тулунская-12 (рисунок
3.31).

Рисунок 3.31 - Встречаемость бактерий, проявляющих
антагонистическую активность в отношении грибов р. Bipolaris,
в различных почвах (% от общего числа выделенных из данной почвы изолятов):
Тул.12 - почва, отобранная с поля, засеянного пшеницей Тулунская 12; Сад.-ог. -
садово-огородная почва Емельяновского района; Ветл. - почва из района
Ветлужанки; Ком. - почва под комнатными растениями

Рисунок 3.32 - Встречаемость бактерий,
проявляющих антагонистическую активность в отношении грибов р. Fusarium
штамм Y7ес, в различных
почвах (% от общего числа выделенных из данной почвы изолятов): Тул.12 - почва,
отобранная с поля, засеянного пшеницей Тулунская 12; Сад.-ог. -
садово-огородная почва Емельяновского района; Ветл. - почва из района
Ветлужанки; Ком. - почва под комнатными растениями
Наибольшее число антагонистов, активных в
отношении грибов р. Fusarium
штамм TIG6,
выделилось из почвы под комнатными растениями (рисунок 3.33).

Рисунок 3.33 - Встречаемость бактерий,
проявляющих антагонистическую активность в отношении грибов р. Fusarium
штамм TIG6, в
различных почвах (% от общего числа выделенных из данной почвы изолятов):
Тул.12 - почва, отобранная с поля, засеянного пшеницей Тулунская 12; Сад.-ог. -
садово-огородная почва Емельяновского района; Ветл. - почва из района
Ветлужанки; Ком. - почва под комнатными растениями
Наибольшее число антагонистов, активных в
отношении грибов р. Fusarium
штамм Т2ес, выделилось из почвы, взятой в районе Ветлужанки (рисунок 3.34).

Рисунок 3.34 - Встречаемость бактерий,
проявляющих антагонистическую активность в отношении грибов р. Fusarium
штамм Т2ес, в различных почвах (% от общего числа выделенных из данной почвы
изолятов): обозначения места взятия почвенных образцов смотри в рисунке 3.33
Тем не менее, дисперсионный анализ не выявил
статистически достоверных различий между различными почвами по частоте
встречаемости антагонистов в отношении использованных тест-культур.
Был также проведен сравнительный анализ биологической
активности антагонистов, выделенных из различных почв. В анализ были включены
только те штаммы, которые статистически достоверно подавляли прорастание
конидий соответствующих тест-культур (приложение Г).
Не обнаружено статистически достоверных различий
между средней активностью антагонистов, выделенных из различных почв, в
отношении гриба р. Bipolaris. (таблица 3.1, рисунок 3.35).
Таблица 3.1 - Результаты однофакторного
дисперсионного анализа влияния места отбора почвенных обрзцов на антагонистическую
активность в отношении гриба р. Bipolaris
|
Источник
вариации
|
SS
|
df
|
MS
|
F
|
P-Значение
|
F
критическое
|
|
Между
группами
|
3684,32
|
3
|
1228,10
|
1,77
|
0,1807964
|
3,04912362
|
|
Внутри
групп
|
15197,69
|
22
|
690,80
|
|
|
|
|
Итого
|
18882,01
|
25
|
|
|
|
|
|
|
|
|
|
|
|

Рисунок 3.35 - Средняя активность антагонистов,
выделенных из различных почв, в отношении гриба р. Bipolaris: обозначения места
взятия почвенных образцов см. в рисунке 3.33
Не обнаружено статистически достоверных различий
между средней активностью антагонистов, выделенных из различных почв, в
отношении гриба р. Fusarium
(TIG6) (таблица 3.2,
рисунок 3.36).
Таблица 3.2 - Результаты однофакторного
дисперсионного анализа влияния места отбора почвенных обрзцов на антагонистическую
активность в отношении гриба р. Fusarium
(TIG6)
|
Источник
вариации
|
SS
|
df
|
MS
|
F
|
P-Значение
|
F
критическое
|
|
Между
группами
|
1273,18
|
3
|
424,39
|
0,62584
|
0,6050223
|
2,9912428
|
|
Внутри
групп
|
16952,77
|
25
|
678,11
|
|
|
|
|
Итого
|
18225,96
|
28
|
|
|
|
|

Рисунок 3.36 - Средняя активность антагонистов,
выделенных из различных почв, в отношении гриба р. Fusarium (TIG6): обозначения
места взятия почвенных образцов см. в рисунке 3.33
Не обнаружено статистически достоверных различий
между средней активностью антагонистов, выделенных из различных почв, в
отношении гриба р. Fusarium
(Т2ес) (таблица 3.3, рисунок 3.37).
Таблица 3.3 - Результаты однофакторного
дисперсионного анализа влияния места отбора почвенных обрзцов на антагонистическую
активность в отношении гриба р. Fusarium
(Т2ес)
|
Источник
вариации
|
SS
|
df
|
MS
|
P-Значение
|
F
критическое
|
|
Между
группами
|
127,03
|
3
|
42,34623
|
0,050522
|
0,9847537
|
2,85879
|
|
Внутри
групп
|
31011,9
|
37
|
838,1605
|
|
|
|
|
Итого
|
31138,9
|
40
|
|
|
|
|

Рисунок 3.37 - Средняя активность антагонистов,
выделенных из различных почв, в отношении гриба р. Fusarium (Т2ес): обозначения
места взятия почвенных образцов см. в рисунке 3.33
Исключение составляют антагонисты, активные в
отношении штамма Y7ес.
Наибольшую активность проявили изоляты, выделенные из почвы из почвы под
комнатными растениями, что статистически достоверно на уровне значимости
р=0,001 (таблица 3.4, рисунок 3.38).
Таблица 3.4 - Результаты однофакторного дисперсионного
анализа влияния места отбора почвенных обрзцов на антагонистическую активность
в отношении гриба р. Fusarium
(Y7ес)
|
Источник
вариации
|
SS
|
df
|
MS
|
F
|
P-Значение
|
F
критическое
|
|
Между
группами
|
5349,27
|
3
|
1783,092
|
3,10066
|
0,039933978
|
2,891567874
|
|
Внутри
групп
|
18977,23
|
33
|
575,0675
|
|
|
|
|
Итого
|
24326,5
|
36
|
|
|
|
|

Рисунок 3.38 - Средняя активность антагонистов,
выделенных из различных почв, в отношении гриба р. Fusarium (Y7ес):
обозначения места взятия почвенных образцов см. в рисунке 3.33
В настоящее время коллекция выделенных антагонистов
передана на кафедру экологической генетики и биотехнологии для дальнейших
исследований.
Выводы
. В результате проведенных исследований выделено
49 штаммов микроорганизмов, проявляющих антагонистическую активность в
отношении фитопатогенных грибов р. Fusarium
и р. Bipolaris
. Среди грибов наибольшую антагонистическую
активность в отношении тест-культур проявили представители р. Penicillium (2
изолята) и р. Aspergillus (2 изолята). Среди бактерий-антагонистов преобладают
предствители коринеформных бактерий, в том числе - р. Arthrobacter
и р. Micobacterium,
и актиномицеты. Обнаружены также представители р. Bacillus
и р. Pseudomonas.
. Обнаружены статистически достоверные различия
между тест-культурами как по общей чувствительности к метаболитам выделенных
антагонистов, так и по индивидуальной чувствительности к метаболитам отдельных
штаммов антагонистов. Наибольшей чувствительностью к грибам-антагонистам
обладают штаммы р. Fusarium
TIG6, Z2-04,
наименьшей - р. Fusarium
T13m.
Наибольшей чувствительностью к бактериям-антагонистам обладают штаммы р. Fusarium
Y7ес и Т2ес,
наименьшей - р. Bipolaris.
. Среди грибов-антагонистов наибольший
практический интерес представляет изолят А-5, эффективно подавляющий
прорастание конидий всех тест-культур даже при разведении культурального
фильтрата 1:7. Среди бактерий-антагонистов наибольший практический интерес
представляют штаммы Т2, Т4, Т11, обладающие высокой активностью в отношении
грибов р. Bipolaris,
а также изоляты Т1 и Т9, высоко активные в отношении всех штаммов р. Fusarium.
. Не обнаружено статистически достоверных
различий между различными почвами по частоте встречаемости антагонистов в
отношении использованных тест-культур, а также статистически достоверных
различий между средней активностью антагонистов, выделенных из различных почв.
Исключение составляют антагонисты, активные в отношении штамма Y7ес.
Наибольшую активность в отношении данного штамма проявили изоляты, выделенные
из почвы под комнатными растениями, что статистически достоверно на уровне значимости
р=0,001.
Библиографический список
1. Абеленцев, В. И. Ассортимент
протравителей - спектр фунгицидного действия, биологическая эффективность,
проблемы, выбор препарата / В. И. Абеленцев // Достижения науки и техники АПК.
-2006. -№ 9. - С . 48.
. Айзенман, Б. Е. Антибиотичесике
свойства бактерий / Б. Е. Айзенман. - Киев : Наукова думка, 1973. - 183 с.
. Аникиев, В. В. Руководство к
практическим занятиям по микробиологии / В. В. Аникиев, К. А. Лукомская. - М. :
Просвещение, 1977. - 255 с.
. Барахтянская, Н. Г. Биологические
препараты для защиты зерновых / Н. Г. Барахтянская, Н. Г. Зубов // Защита
растений. - 1986. - № 3. - С. 13.
. Бартошевич, Ю. Э. Дифференциация
микроорганизмов и биосинтез антибиотиков / Ю. Э. Бартошевич, П. Л. Заславская
// Успехи микробиологии. - 1983. - Вып. 18. - С. 50-76.
. Бенкен, А. А. Упрощенный способ
диагностики гельминтоспориозной корневой гнили злаковых колосовых культур/ А.
А. Бенкен, С. Д. Гришечкина, Л. К. Хацкевич // Микология и фитопатология. -
1988. - Т. 22. - Вып. 2. - С. 153-156.
. Бенкен, А. А. Формирование
почвенной инфекции обыкновенной корневой гнили ячменя / А. А. Бенкен, С. Д.
Гришечкина, Л. К. Хацкевич // Микология и фитопатология. - 1990. - Т. 24. -
Вып. 4. - С. 336-343.
. Березова, Е. Ф. Миколитические бактерии
в корневой системе растений / Е. Ф. Березова, А. Н. Наумова // Микробиология. -
1939. - Т. 8. - С. 695.
. Билай, В. И. Ядовитые грибы на
зерне хлебных злаков / В. И. Билай. - Киев :АН УССР, 1953. - 90 с.
. Билай, В. И. Токсинообразующие
микроскопические грибы и вызываемые ими заболевания человека и животных / В. И.
Билай, Н. М. Пидопличко. - Киев : Наукова думка, 1970. - 298 с.
. Билай, В. И. Исследования по
физиологии фузариев / В. И. Билай, И. П. Брюхина, Л. А. Богомолова //
Метаболиты почвенных микромицетов : сб. науч. тр. / Ин-т микробиологии и
вирусологии им. акад. Д. К. Заболотного. - Киев, 1971. - С. 3-42.
. Билай, В. И. Фузарии / В. И.
Билай. - Киев : Наукова думка, 1977. -434 с.
. Билай, В. И. Методы
экспериментальной микологии / В. И. Билай. - Киев : Наукова думка, 1982. - 550
с.
. Билай, В. И. Основы общей
микологии / В. И. Билай. - Киев : Головное изд-во, 1986. - 392 с.
. Биологическая защита растений / И.
Т. Король, В. И. Сидляревич, Н. А. Таран. - Минск : Ураджай, 2000. - 414 с.
. Биологическая защита растений / М.
В. Штерншис, Ф. С. Джалилов. - М. : Колос, 2004. - 264 с.
. Биологические и биорациональные
средства защиты растений: Краткий справочник / В. Ф. Кобзарь. - Краснодар,
1995. - 42 с.
. Бондаренко, А. И. Биологический
метод защиты растений от заболеваний / А. И. Бондаренико, Л. Д. Буймистру, С.
И. Николаева // Приминение биологических методов защиты растений в
сельскохозяйственном производстве: Сборник научных трудов. - 1988. - С. 44-50.
. Бондаренко, Н. В. Биологическая
защита растений / Н. В. Бондаренко. - М. : Агропромиздат. 1986. - 276 с.
. Буга, С. Ф. Защита зерновых
культур от болезней в Белоруссии / С. Ф. Буга // Защита и карантин растений. -
2005. - № 2. - С. 18-20.
. Бучнева, Г. Н. Грибы рода Fusarium
на пшенице в Центрально-черноземном регионе России / Г. Н. Бучнева // Вестник
защиты растений. -2004. - Вып. 3. - С. 46-50.
. Ведров, Н. Г. Селекция и
семеноводство яровой пшеницы в экстремальных условиях / Н. Г. Ведров. -
Красноярск. : Изд-во Краснояр. гос. ун-та, 1984. - 240 с.
. Гешеле, Э. Э. Болезни зерновых
культур в Сибири / Э. Э. Гешеле. М. : Сельхозгиз, 1956. - 123 с.
. Горленко, М. В.
Сельскохозяйственная фитопатология / М. В. Горленко. - М. : Высшая школа, 1968.
- 434 с.
25. Горьковенко,
В.
С.
Гриб
Bipolaris sorokiniana (Saac.) Shoem. в полевом
севообороте / В. С. Горьковенко // Защита и карантин растений. - 2005 - № 8. -
С. 32-33.
. Гришечкина, С. Д. Фунгистическая
активность различных подвидов Bacillus
Thuringiensis / С. Д. Гришечкина
// Микология и фитопатология. - 2002. - Вып. 1. - С. 58-65.
27. Громовых,
Т.
И.
Trichoderma Harzianum Rifal Addr. Как фактор
повышения устойчивости томатов к возбудителям корневой гнили / Т. И. Громовых,
В. М. Гукасян, Т. И. Голованова // Микология и фитопатология. - 1990. - Т. 32.
- Вып. 2. - С. 73-78.
. Гукасян, В. М. Отношение непарного
шелкопряда к криссталлоносным микроорганизмам / В. М. Гукасян // Биология и
культивирования микроорганизмов : сб. науч. тр. / Ин-т леса и древесины СО АН
СССР, Краснояр. отделение Всесоюзного микробиологического общества АН СССР,
Ин-т физики СО АН СССР. - Красноярск, 1969. - С. 155-158.
. Гутина, В. Н. Николай
Александрович Красильников (1896-1973) / В. Н. Гутина. - М. : Наука, 1982. -
215 с.
. Добрецов, А. Н. Борьба с головней
и корневыми гнилями зерновых культур / А. Н. Добрецов. - Красноярск : Краснояр.
книжное изд-во, 1960. - 35 с.
. Дурынина, Е. П., и др. Почвенные
фитопатогенные грибы / Е. П. Дурынина, Л. Л. Великанов. - М. : Изд-во МГУ,
1984. - 107 с.
. Егоров, Н. С. Основы учения об
антибиотиках / Н. С. Егоров. - М. : Высшая школа, 1969. - 479 с.
. Егоров, Н. С. Руководство к
практическим занятиям по сельскохозяйственной микробиологии / Н. С. Егоров. -
М. : Изд-во МГУ, 1995. - 234 с.
. . Егорова, Л. Н. Почвенные грибы
Дальнего Востока: Гифомицеты / Л. Н. Егорова. - Ленинград : Наука, 1986. - 192
с.
. Емцев, В. Т. Микробиология / В. Т.
Емцев. - М. : Дрофа, 2005. - 445 с.
. Жизнь растений. В 6 т. Т. 1.
Бактерии и актиномицеты / Н. А. Красильников. - М. : Просвещение, 1974. - 474
с.
. Жизнь растений. В 6 т. Т. 2. Грибы
/ М. В. Горленко. - М. : Просвещение, 1976. - 479 с.
. Иващенко, В. Г. Экологический
мониторинг возбудителей фузариоза семян зерновых культур на северо-западе
России / В. Г. Иващенко, Н. П. Шипилова, И. Ю. Кирцидели // Микология и
фитопатология. - 1997. - Вып. 2. - С. 64-69.
. Игнатова, С. И., и др. Антагонисты
патогенных микроорганизмов филлосферы / С. И. Игнатова, С. Ф. Багирова //
Защита и карантин растений. - 1998. - № 2. - С. 62.
. Исмаилов, В. Я. Биологический
метод: прошлое, настоящее, будущее / В. Я. Исмаилов, В. Г. Коваленков, В. Д.
Надыкта // Защита и карантин растений. - 2002. - № 3. - С. 13-16.
. Калинина, К. В. Особенности
микробных сукцессий в почве в зависимости от уровня влажности / К. В. Калинина,
П. А. Кожевин, Д. Г. Звягинцев // Почвоведение. - 1997. - № 4. - С. 518-521.
. Калько, Г. В. Ингибирование
микробами-антагонистами фитопатогенного гриба Fusarium
Oxysporum в торфогрунте / Г.
В. Калько, Н. И. Воробьев, Т. М. Лагутина // Микология и фитопатология. - 2001.
- Вып. 2. - С. 66-75.
. Караджова, Л. В. Фузариозы полевых
культур / Л. В. Караджова. - Кишинев : Штиинца, 1989. - 255 с.
. Кипрушкина, Е. И. Биологическая
защита сельскохозяйственной // Вестник защиты растений. - 2003. - Вып . 3. - С
. 17-24.
. Коваль, С. Ф. Влияние корневой
гнили на чувствительность пшеницы к неблагоприятным абиотическим факторам / С.
Ф. Коваль, В. З. Рогинский // Сиб. Вестник с.-х. науки. - 1977. - Вып. 3. - С.
44-51.
. Козловская Н. В. Выделение и
идентификация культур рода Mycobacterium - антагонистов фитопатогенной
микрофлоры / Н. В. Козловская, И. О. Обгольцева, Е. П. Яковлева // Антибиотики
и химиотерапия. - 1998. - N6. - С. 20-23.
. Коробова, Л. Н. Приминение
бактофита: и прибавка урожая, и оздоровление почвы / Л. Н. Коробова, Т. В.
Гаврилец // Защита и карантин растений. - 2006. - № 4. - С. 47-48.
. Коротяев, А. И. Физиологическая
роль антибиотиков и механизм их антимикробного действия / А. И. Коротяев, А. А.
Астапов, Э. В. Карасева // Успехи микробиологии. - 1970. - Вып. 6. - С.
199-210.
. Коршунова, А. Ф. Вредная
микрофлора корневой системы злаков / А. Ф. Коршунова // Тр. ВНИИЗР. - 1972. -
Вып. 33. - С. 145-148.
. Коршунова, А. Ф. Основные и
вторичные возбудители корневых гнилей пшеницы / А. Ф. Коршунова // Бюлл.
СибНИИХим. - 1973. - Вып. 8. - С. 6-8.
. Коршунова, А. Ф. Корневые гнили
зерновых в Сибири / А. Ф. Коршунова. - Ленинград : Колос, 1974. - 125 с.
. Коршунова, А. Ф. Корневые гнили
яровой пшеницы / А. Ф. Коршунова, С. М. Тупеневич, Г. А. Краева. - Ленинград :
Колос, 1974. - 63 с.
. Коршунова, А. Ф. Защита пшеницы от
корневых гнилей / А. Ф. Коршунова, А. Е. Чумаков, Р. И. Щекочихина. - Ленинград
: Колос, 1976. - 184 с.
. Красильников, Н. А. О влиянии
микроорганизмов на рост растений / Н. А. Красильников // Микробиология. - 1940.
- Т. 9. - С. 412.
. Красильников, Н. А.
Актиномицеты-антагонисты и антибиотичесике вещества / Н. А. Красильников. - М.
: Изд-во АН СССР, 1950. - 303 с.
. Красильников, Н. А. О внутри- и
межвидовом антагонизме у микроорганизмов / Н. А. Красильников. - М. : Изд-во АН
СССР, 1951. - 77 с.
. Красильников, Н. А.
Микробы-антагонисты и антибиотические вещества в растениеводстве / Н. А.
Красильников. - М. : Изд-во АН СССР, 1953. - 49 с.
. Красильников, Н. А. Микробы,
стимулирующие рост растения / Н. А. Красильников // Вестник с.- х.н. - 1958. -
№7. - С. 52-62.
. Красильников, Н. А. Современное
состояние вопроса о применении антибиотиков и других метаболитов микробов в
растениеводстве / Н. А. Красильников // Применение антибиотиков в
растениеводстве: Тр. 1 Всессоюз. конф. по изучению и применению антибиотиков в
растениеводстве. - Ереван, 1961. - С. 7-19.
. Кузьмина, Л. Ю. Колонизация
ризосферы яровой пшеницы бактериями рода Bacillus
Cohn при бактеризации
семян / Л. Ю. Кузьмина, А. И. Мелентьев // Микробиология. - 2003. - №2. - С.
268-274.
. Кулдыбаев, М. М. Условия
биосинтеза антибиотиков некоторыми актиномицетами-антагонистами грибов рода Fusarium
/ М. М. Кулдыбаев, Г. Ш. Сейкетов // Антибиотики, витамины и стимуляторы
микробного происхождения : сб. науч. тр. / Ин-т микробиологии и вирусологии. -
Алма-ата, 1974. - С. 51-56.
. Ланкина, Е. П. Выделение почвенных
грибов-антагонистов и анализ их антибиотической активности в отношении
фитопатогенных грибов р. Fusarium
и р. Bipolaris
/ Е. П. Ланкина // Современные тенденции развития АПК в России : мат-лы V
Междунар. науч.-практ. конф. молодых ученых Сибирского федерального округа /
Краснояр. гос. аграр. ун-т. - Красноярск, 2007. - С. 166-170.
. Ланкина, Е. П. Выделение почвенных
грибов-антагонистов и анализ их антибиотической активности в отношении
фитопатогенных грибов р. Fusarium
и р. Bipolaris
/ Е. П. Ланкина // Студенческая наука - взгляд в будущее: мат-лы Всероссийской
студенческой научной конф. посвященной 55-летию ФГОУ ВПО «КрасГАУ» : состоялась
28.03.07. / Краснояр. гос. аграр. ун-т. - Красноярск, 2007.
. Ланкина, Е. П. Скрининг почвенных
бактерий-антагонистов к возбудителям гельминтоспориозной и фузариозной корневых
гнилей / Е. П. Ланкина, С. В. Драчева // Студенческая наука - взгляд в будущее:
мат-лы Всероссийской студенческой научной конф. посвященной 55-летию ФГОУ ВПО
«КрасГАУ» : состоялась 28.03.07. / Краснояр. гос. аграр. ун-т. - Красноярск,
2007.
. Лысак, Л. В. Микроорганизмы -
стимуляторы и ингибиторы роста растений и животных / Л. В. Лысак //
Микробиология. - 1990. - Т. 59. - Вып. 4. - С. 715.
. Мазунина, В. И. Образование
витаминов и стимулирующих веществ актиномицетами ризосферы кукурузы / В. И.
Мазунина // Антибиотики, витамины и стимуляторы микробного происхождения : сб.
науч. тр. / Ин-т микробиологии и вирусологии. - Алма-ата, 1974. - С. 134-137.
. Мазунина, В. И. Стимулирующее
действие культуральной жидкости актиномицета штамма 912 и витаминов группы В на
рост сельскохозяйственных растений / В. И. Мазунина // Антибиотики, витамины и
стимуляторы микробного происхождения : сб. науч. тр. / Ин-т микробиологии и
вирусологии. - Алма-ата, 1974. - С. 138-141.
. Мелентьев, А. И. Использование
микроорганизмов для защиты сельскохозяйственных растений от болезней / А. И.
Мелентьев, А. П. Кочемасова, Н. Ф. Галимзянова // Актуальные вопросы
биотехнологии. - Уфа, 1990. - С. 4-13.
. Мелентьев, А. И. Влияние
температуры и влажности почвы на колонизацию ризосферы пшеницы бактериями Bacillus
Cohn., антагонистами
фитопатогенов / А. И. Мелентьев, Л. Ю. Кузьмина, Н. Ф. Галимзянова // Микробиология.
- 2000. - № 3. - С. 426- 432.
. Микробиологическая защита
растений: Справочник / И. Т. Король. - М. Колос, 1993. - 79 с.
. Минаева, О. М. Антагонистическое
действие на фитопатогенные грибы и стимулирующее влияние на рост и развитие
формальдегидутилизирующих бактерий Pseudomonas
sp. B-6798 и их
применение: Автореферат дис. … канд. биол. наук / О. М. Минаева. - Томск, 2007.
- 23 с.
. Мишустин, Е. Н. Химизация
земледелия и задачи микробиологии / Е. Н. Мишустин // Успехи микробиологии. -
1971. - Вып. 7. - С. 186-195.
. Монастырский, О. А. Разработка
биопрепаратов для борьбы с токсигенными грибами / О. А. Монастырский // Защита
и карантин растений. - 2004. - № 9. - С. 26-28.
. Монастырский, О. А. Токсины
фитопатогенных грибов / О. А. Монастырский // Защита и карантин растений. -
1996. - № 3. - С. 12-14.
. Нахимовская, М. И. Антагонизм
между актиномицетами и почвенными бактериями / М. И. Нахимовская //
Микробиология. - 1937. - Т. 6. - С. 131.
. Нахимовская, М. И. Антагонизм у
бактерий / М. И. Нахимовская // Микробиология. - 1939. - Т. 8. - С. 1014.
. Нефелова, М. В. Спорообразование и
биосинтез антибиотиков полипептидов / М. В. Нефелова // Успехи микробиологии. -
1982. - Вып. 17. - С. 177-189.
. Никуленко, Т. Ф. Токсины
фитопатогенных грибов и их роль в развитии болезней растений / Т. Ф. Никуленко,
Д. И. Чкаников. - М. : Изд-во ВНИИТЭИ, 1987. - 52 с.
. Новикова, И. И. Испытание новых
биопрепаратов в борьбе с фузариозом колоса / И. И. Новикова; В. Г.Иващенко //
Микология и фитопатология. - 2001. - Т. 28. - Вып. 2. - С. 70-75.
. Новогрудский Д. М. Использование
микробов в борьбе с грибковыми заболеваниями культурных растений / Д. М.
Новогрудский. - АН СССР, 1936. - С. 277.
. Пересыпкин, В. Ф. Система
мероприятий против болезней, вредителей и сорняков // Проблемы защиты растений
от вредителей, болезней и сорняков / В. Ф. Пересыпкин, А. В. Воеводин, А. Е.
Чумаков. - М. : Колос, 1979. - С. 79-84.
. Полозова, И. А. Вредоносность
гельминтоспориозно - фузариозной корневой гнили зерновых культур в
Ленинградской облости / И. А. Полозова // Труды ЛСХИ. - Ленинград, 1981. - С.
53-55.
. Попкова, К. В. Общая фитопатология
/ К. В. Попкова. - М. : Агропромиздат, 1979. - С. 210.
. Потлайчук, В. И. Микрофлора семян
яровой пшеницы и риса в различных условиях выращивания / В. И. Потлайчук, А. Я.
Семенов // Бюл. ВНИИ защиты растений, 1977. - Вып. 40. - С. 40-44.
. Пузырь, А. П. Особенности строения
колоний Bacillus
subtilis 2335 / А. П.
Пузырь, О. А. Могильная, Т. Ю. Крылова // Микробиология. - 2000. - № 1. - С.
66-74.
. Рогинский, В. З. К вопросу о
физиологии яровой пшеницы, пораженной обыкновенной корневой гнилью / В. З.
Рогинский, Р. А. Башмаков // Сибирский вестник с.-х. науки. - 1974. - Вып. 3. -
С. 59-62.
. Рогинский, В. З. Физиология
поражения яровой пшеницы корневой гнилью / В. З. Рогинский, Е. Г. Пеккер, Р. А.
Башмаков // Сибирский вестник с.-х. науки. - 1974. - Вып. 6. - С. 25-32.
. Рогинский, В. З. О специфике
повреждения яровой пшеницы корневой гнилью в условиях континентального климата.
Повышение продуктивности и устойчивости зерновых культур / В. З. Рогинский, В.
А. Рогинская. - Алма-Ата : Наука, 1979. - С. 228-233.
. Рогинская, В. А. Влияние условий
культивирования на токсинообразование у возбудителя корневой гнили пшеницы
гриба Helminthosporium sativum P. K. et B. Микробные ассоциации и их
функционирование в почвах Западной Сибири / В. А. Рогинская. - Новосибирск :
Наука, 1979. - С. 243-250.
. Самсонова, А. С. Микробы против
микробов / А. С. Самсонова. - Минск : Наука и техника, 1985. - 70 с.
. Саттарова, Р. К. Бактерии-антагонисты
и протравители против гнили пщеницы / Р. К. Саттарова, Н. Т. Хакимова, Р. Н.
Маннанов // Защита и карантин растений. - 2005. - № 7. - С. 28.
. Сейкетов, Г. Ш. Грибы-антагонисты
из рода триходерма и их использование при некоторых заболеваниях картофеля в
Казахстане / Г. Ш. Сейкетов // Применение антибиотиков в растениеводстве. -
Ереван, 1961. - С. 147-152.
. Семенов, А. Я. Инфекция хлебных
злаков /А. Я. Семенов, Р. Н. Федорова. - М. : Колос, 1984. - 95 с.
. Семынина, Т. В. Биопрепараты и
регуляторы роста растений для обработки семян зерновых культур / Т. В. Семынина
// Защита и карантин растений. - 2006. - № 2. - С. 24-25.
. Смирнов, В. В. Бактерии рода Pseudomonas
/ В. В. Смирнов, Е. А. Киприанова. - Киев : Наукова думка, 1990. - 264 с.
. Смирнов, О. В. Многоцелевое
действие биопрепаратов / О. В. Смирнов // Защита и карантин растений. - 2006. -
№ 2. - С. 20.
. Сорокатая, Е. И.
Биотехнологические методы в селекции ярового ячменя на устойчивость к
возбудителям корневой гнили / Е. И. Сорокатая. - Красноярск : Краснояр. гос.
аграр. ун-т, 2003. - 70 с.
. Сурин, Н. А. Ячмень Восточной
Сибири / Н. А. Сурин. - Красноярск : Красноярское книжное изд-во, 1977. - 111
с.
. Сурин, Н. А. Селекция ячменя в
Сибири / Н. А. Сурин, Н. Е. Ляхова. - Новосибирск : РАСХН. Сиб. Отделение. НПО
«Енисей», 1993. - 292 с.
. Тепляков, Б. И. Патогенез
обыкновенной корневой гнили зерновых культур в зависимости от заселенности
почвы B.sorokiniana. Зональные системы защиты растений от вредителей и болезней
в Сибири. - Новосибирск : СибНИИЗХим, 1981. - С. 11-20.
. Торопова, А. Т. Влияние
температуры воздуха на интенсивность зараженности зерна яровой пшеницы Н. sativum
/ А. Т. Торопова // Тр. ин-та прикл. Зоологии и фитопатологии. - М., 1958. - С.
195-205.
. Тропова, А. Т. Влияние относительной
влажности воздуха на интенсивность заражения зерна яровой пшеницы / А. Т.
Тропова. - М. ВАСХНИЛ, 1976. - С. 55-65.
. Трошина, Н. Б. Цитологическое и
флуоресцентное исследование корневых гнилей пшеницы / Н. Б. Трошина, А. М.
Ямалеев // Микология и фитопатология. - 1990. - Т. 24. - Вып. 1. - С. 30-34.
. Тулемисова, К. А. Штамм Streptomyces
griseoruber 3-79 № 314
продуцент антибиотика для борьбы со слизистым бактериозом капусты / К. А.
Тулемисова, Е. Ф. Инга, Е. Т. Никитина. - Ин-т микробиологии и вирусологии АН
Каз. ССР, 1983. - 8 с.
. Тупеневич, С. М. Корневые гнили
яровой пшеницы / С. М. Тупеневич. - М. : Колос, 1974. - 64 с.
. Тютерев, С. Л. Проблема борьбы с
фузариозом колоса в СССР / С. Л. Тютерев // Научные основы химической защиты
сельскохозяйственных культур от болезней: Сб. науч. тр. ВИЗР. - Ленинград,
1991. - С. 63-66.
. Указатель возбудителей болезней
сельскохозяйственных растений (по зерновым культурам) / А. Е. Чумаков. -
Ленинград, 1971. - 100 с.
. Фадеев, Ю. Н. Фотохимическая
активность хлоропластов пшеницы при поражении гельминтоспориозной корневой
гнилью / Ю. Н. Фадеев, Г. А. Тарабрин, Е. Е. Быстрых // Доклады ВАСХНИЛ. -
1986. - Вып.10. - С. 10-12.
. Фадеев, Ю. Н. Получение препаратов
токсинов гриба Bipolaris sorokiniana - возбудителя гельминтоспориоза зерновых:
методические рекомендации. ВНИИ сельскохозяйственной биотехнологии. - М., 1990.
- 15 с.
. Хижняк, С. В. Основы систематики,
морфологии и экологии грибов / С. В. Хижняк, Е. И. Сорокатая. - Красноярск :
Изд-во Краснояр. гос. аграр. ун-т, 2004. - 111 с.
. Худяков, Я. П. Литическое действие
почвенных бактерий на паразитический гриб / Я. П. Худяков // Микробиология. -
1935. - Т. 4. - С. 193.
. Цугленок, Н. В. Система защиты
зерновых и зернобобовых культур от семенных инфекций / Н. В. Цугленок, Г. И.
Цугленок, А. П. Халанская. - Красноярск : Изд-во Краснояр. гос. аграр.
университета, 2003. - 243 с.
. Чйлахян, М. Х. Мелаболиты микробов
как стимуляторы роста и развития высших растений / М. Х. Чйлахян // Труды I-й
Всес. конф. по изучению и применению антибиотиков в растениеводстве. Изд-во АН
АрмССР. - Ереван, 1961. - С. 45-46.
. Чормонова, Н. Т. Поиск
антагонистов среди актиномицетов рода Actinomadura
/ Н. Т. Чормонова / Тезисы VI
съезда ВМО. - Рига, 1980. - С. 109.
. Чулкина, В. А. Корневые гнили
злаков в Сибири / В. А. Чулкина. - Новосибирск : Заподно-Сибирское кн. изд-во,
1973. - 107 с.
. Чулкина, В. А. Защита зерновых
культур от обыкновенной гнили / В. А. Чулкина. - М. : Россельхозиздат, 1979. -
72 с.
. Чулкина, В. А. Состояние и
преспективы исследований по селекции яровой пшеницы на устойчивость к
обыкновенной корневой гнили в Сибири. Интегрированная защита растений / В. А.
Чулкина, Э. Ф. Лангольф. - Новосибирск : СибНИИЗХим, 1983. - С. 3-26.
. Чулкина, В. А. Корневые гнили
хлебных злаков в Сибири / В. А. Чулкина. - Новосибирск : Наука, 1985. - 180 с.
. Чулкина, В. А. Корневые гнили / В.
А. Чулкина, Е. Ю. Торопова // Защита и карантин растений. - 2004. - № 2. - С.
16-17.
. Шевелев, А. С. Последний подвиг
Луи Пастера / А. С. Шевелев, Р. Ф. Николаева. - М. : Медицина, 1988. - 112 с.
. Шипилова, Н. П. Вредоносность
патогенного комплекса возбудителей фузариозов семян яровой пшеницы в различных
регионах страны / Н. П. Шипилова, С. Ф. Сидорова, Л. И. Филиппова //
Экологические аспекты вредоносности болезней зерновых культур: Сборник научных
трудов ВИЗР. - Ленинград, 1987. - С. 84-91.
. Штерншис, М. В. Биопрепараты на
основе микробных метаболитов / М. В. Штерншис // Защита и карантин растений. -
2002. - № 9. - С. 18-19.
. Штерншис, М. В. Биологическая
защита растений / М. В. Штерншис, Ф. С. Джалилов. - М. : КолосС, 2004. - 264 с.
. Штерншис, М. В. Роль и возможности
биологической защиты растений / М. В. Штерншис // Защита и карантин растений. -
2006. - № 6. - С. 14-16.
. Шумилина, Д. В. Микробный фактор 3
- база для создания новых биопрепаратов / Д. В. Шумилина, Т. М. Воинова, В. Г.
Джавахия // Защита и карантин растений. - 2006. - № 10. - С. 20-21.
. Щекочихина, Р. И. Роль токсинов
Helminthosporium sativum P.K.et B. в патогенезе корневой гнили пшеницы / Р. И.
Щекочихина // Микология и фитопатология. - 1975. - Т. 9. - Вып. 6. - С.
518-523.
. Щекочихина, Р. И. Биоэкологическое
обоснование зон вредоносности гельминтоспориозной корневой гнили пшеницы в
СССР: Автореферат дис. … канд. биол. наук / Р. И. Щекочихина. - Ленинград,
1978. - 22 с.
128. Abraham, E. P. Biogenesis
of antibiotic substensis / E. P. Abraham, G. R. Newton, S. C. Warren. - Prague,
1965. - P. 169.
. Bacon, C. W. Production of
fusaric acid by Fusarium species / C. W. Bacon, J. K. Porter, W. P. Norred, J.
F. Leslie //Applied and environmental microbiology. - 1996. - Vol. 62. - № 11.
- Р.
923-935.
. Bamberg, R. Bacteria
antibiotic Ustilago zeae / R. Bamberg // Phytopathology. - 1930. - V. 20. - P.
140.
. Benizri, E. Root colonization
by moculated plant growth-promoting rhizobacteria / E. Benizri, E. Baudon, A.
Guckert // Biocontrol science and technology. - 2001. - № 11. - Р.
557-574.
. Casinovi, C. G. Chemistry of
the Terpenoid phytotoxins. Phytotoxins in Plant Diseases / C. G. Casinovi. -
L.- N., 1972. - Р.
105-125.
. Cook, R. J. Lesion Type as a
Means of Detecting Resistance in Barley Leaves to the Spot Blotch
Helminthosporium / R. J. Cook, R. G. Timian // Phytopathology. - 1962. - V. 52.
- N. 10. - P. 1086-1089.
. Dixit, R. B. Effect of on the
production of antifungal substances by Streptomyces olivaceus and Aspergillus
versicolor / R. B. Dixit, J. S. Gupta // Geobios. - 1983. - V. 10. - N 4. - P.
189-191.
. D´Mello,
J. P. F. Fusarium mycotoxins: a review of global implications for animal
health, welfare and productivity / J. P. F. D´Mello, C. M. Placinta, A.
M. C. Macdonald // Animal feed science and tehnology.
- 1999. - V. 80. - P. 183-205.
. Duczek, L. J. Sporulation of
Cohliobus sativus on crown and anderground parts of spring cereals in relation
to wheat and host species, cultivars and phenology / L. J. Duczek // Canadian
J. of Plant Pathology. - 1990. - V. 12. - N. 3. - P. 273-278.
. Duffy, B. K. Combination of Trichoderma
koningii with fluorescent pseudomonads for control of take-all on wheat / B. K.
Duffy, A. Simon, D. M. Weller // Phytopathology. - 1996. - N. 86. - P. 188-194.
. Dutreq, A. Inhibition du
developpement d'embryons de froment en culture in vitro par les filtrats de
culture d'Helminthosporium sativum / A. Dutreq // Med. van de Fac. Land. Rijks.
- 1979. - V. 44. - N. 1. - P. 459-467.
. Georgakopoulos, D. G.
Biological control of cucumber and sugar beet damping-off caused by Pythium
ultimum with bacterial and fungal antagonists / D. G. Georgakopoulos // Journal
of applied microbiology. - 2002. - N. 92. - P. 1078-1086.
. Greig-Smith R. Contribution
to our knowledge of soil fertility / R. Greig-Smith // Proc. Linn-Soc. - 1918.
- V. 43. - P. 142.
. Hanchey, P. Histochemical
changes in oat cell walls after victorin treatment / P. Hanchey //
Phytopathology. - 1980. - V. 70. - N. 5. - P. 377.
. Hanchey, P. Ultrastructural
effects / In: Toxins in Plant Disease, ed R. D. Durbin. - Acad. Press, N. Y,
1981. - P. 449-475.
. Hodges, C. F. Pathogenicity
of soil-borne B.sorokiniana on seed and roots of 3 perenneal grasses / C. F.
Hodges, G. A. Watschike // Phytopathology. - 1975. - V. 65. - N. 4. - P.
398-400.
. Jacobsen, B. J. Biological
and cultural plant disease controls: alternatives and supplements to chemicals
in IPM systems / B. J. Jacobsen, A. Backman // Plant Disease. - 1993. - V. 77.
- N. 3. - P. 311-315.
. Janisiewicz, W. J. Ecological
diversity, niche overlap, and coexistence of antagonist used in developing
mixtures for biocontrol of postharvest diseases of apples / W. J. Janisiewicz
// Phytopathology. - 1996. - N. 86. - P. 473-479.
. Kissling, L. E. Biologische
Massnahmen zur Unterdruckung des Kartoffelschorfes / L. E. Kissling //
Kuhn-Arch. - 1933. - Bd. 38. - P. 184.
. Leeman, M. Suppression of
Fusarium wilt radish by co-inoculation of fluorescent Pseudomonas spp. and
root-colonizing fungi / M. Leeman, F. M. Den Ouden, J. A. Van Pelt // Plant
pathology. - 1996. - N. 102. - P. 21-31.
. Lieske I. Morphologie und
Biologie Der Strahlenpilze (Actinomyceten) / I. Lieske. - Leipzig : Gebruder
Birtraeger, 1921.
. Littrell, E. S. A key to
species of Helminthosporium reported on grasses in the Unated States / E. S.
Littrell // Plant Dis. Rep. - 1951. - V. 201. - P. 59-67.
. Marre, E. Mechanism of action
of fytotoxins affecting plasmalemma functions / E. Marre // Progress in
Phytochemistry. - 1980. - V. 6. - P. 253-284.
. Monaco, C. I. Incremento en
el crecimiento de las plantas inducido por Trichoderma harzianum ningii / C. I.
Monaco // Revista de la Facultad de Agronomia. - 1990. - V. 66/67. - P. 75-77.
. Nielsen, T. H. Viscosinamide,
a new depsipeptide with surfactant and antifungal properties produced by
Pseudomonas fluorescens DR 54 / T. H. Nielsen, C. Christophersen, U. Anthoni //
Journal of applied microbiology. - 2000. - N. 86. - P. 80-90.
. Norino, E. Antibiotic
substancec and processes for production thereat / E. Norino, S. Takashi, N.
Tomizo. - Meiji Seika Kaisha, Ltd. Patent USA, 1983. - 215 p.
. Pierson, E. A. Use of
fluorescent pseudomonads to suppers take-all and improve the growth of wheat /
E. A. Pierson, D. M. Weller // Phytopathology. - 1994. - N. 84. - P. 940-947.
. Placinta,
C. M. A review of world-wide contamination of cereal and animal feed with
Fusarium mycotoxins / C. M. Placinta, J. P. F. D´Mello, A. M. C.
Macdonald // Animal feed science and technology.
- 1999. - V. 78. - P. 21-37.
. Porter, Ch. Concerning the
characters of certain fungi as exhibited by their growth in the presence of other
fungi / Ch. Porter // Amer. J. Bot. - 1924. - V. 11. - P. 168.
. Pringle, R. B. The isolation
of the toxin of Helminthosporium victoriae / R. B. Pringle, A. C. Braun //
Phytopathology. - 1957. - V. 47. - N. 6. - P. 369-787.
. Pringle, R. B.. Isolation of
the host-specific toxin and a related substance with nonspecific toxicity from
Helminthosporium carbonum / R. B. Pringle, R. Scheffer // Phytopathology. -
1967. - V. 57. - N. 11. - P. 1169-1172.
. Pringle, R. B. Role of toxins
in etiology of root rot disease of wheat / R. B. Pringle // Canadian J. of
Botany. - 1977. - V. 55. - N. 13. - P. 1801-1806.
. Pringle, R. B. Role of toxins
in etiology of spot blotch disease of barley / R. B. Pringle // Canad. Plant
Dis. Surv. - 1979. - V. 59. - N. 4. - P. 74-79.
. Scheffer, R. P.
Host-selective toxins and their role in plant diseases / R. P. Scheffer, R. S.
Livingston // Science. - 1984. - V. 223. - N. 4631. - P. 17-21.
. Schisler, D. A. Effects of
antagonist cell concentration and two-strain mixtures on biological control of
Fusarium dry rot of potatoes / D. A. Schisler, P. J. Slinger, R. J. Bothast //
Phytopathology. - 1997. - N. 87. - P. 177-183.
. Sharos, D. D. Isolation of
new strain of Streptomyces albus from Agra soils / D. D. Sharos, S. K. Sinha //
Curr. Sci. (India). - 1982. - V. 51. - N. 6. - P. 297-298.
. Shoemaker, R. A. Nomenclature
of Drechslera and Bipolaris grass parasites segregated from Helminthosporium /
R. A. Shoemaker // Bot. Canada. - 1959. - V. 37. - N. 5. - P. 879-887.
. Tanvonen, R. Preliminare
expereriments into the use of Streptomyces spp. Isolated from peat in the
biological control peat culture / R. Tanvonen // Scient. Agr. Finland. - 1982.
- V. 54. - N. 5. - P. 357-369.
. Watanabe, T. Pictorial Atlas
of soil and seed Fungi. Morphologies of Cultured Fungi and Key to Species. -
Tokyo, 1994. - P. 175-178.
Приложение А
Влияние нативного культурального фильтрата
штаммов-антагонистов на прорастание конидий тест-культур
(обязательное)
Таблица А.1 - Влияние нативного культурального
фильтрата штаммов-антагонистов на прорастание конидий тест-культур
|
Тест
- культура
|
Контроль,
%
|
А-1,
%
|
А-1(1),
%
|
А-5,
%
|
А-2,
%
|
|
Всего
|
Пр.
|
Всего
|
Пр.
|
Всего
|
Пр.
|
Всего
|
Пр.
|
Всего
|
Пр.
|
|
Гриб р.
Bipolaris 1
|
110
|
63
|
141
|
4
|
207
|
65
|
106
|
12
|
107
|
0
|
|
TIG6 2
|
132
|
31
|
168
|
7
|
100
|
11
|
125
|
8
|
109
|
0
|
|
T13m 2
|
120
|
31
|
85
|
21
|
147
|
31
|
111
|
6
|
175
|
15
|
|
Z2-04 3
|
145
|
136
|
114
|
18
|
107
|
58
|
121
|
39
|
111
|
10
|
|
T2ес 2
|
141
|
115
|
167
|
27
|
143
|
25
|
151
|
6
|
132
|
0
|
Время прорастания 3,0 ч; температура + 26 ºС
Время прорастания 6,0 - 6,5 ч; температура + 26 ºС
Время прорастания 6,0 - 6,5 ч (температура 26
ºС)
+ 16,0 ч (температура + 4ºС)
Приложение Б
Анализ спектра действия изучаемых антагонистов
на тест-культуры по критерию хи-квадрат
(обязательное)
Таблица В.1 - Анализ спектра действия изучаемых
антагонистов на тест-культуры по критерию хи-квадрат (реальное распределение)
|
Штамм
|
TIG6
|
T13m
|
Z2-04
|
T2ec
|
Bip
|
Итого
|
|
А-1
|
17,9
|
95,7
|
16,8
|
19,9
|
48,9
|
199,2
|
|
А-1(1)
|
46,8
|
81,7
|
57,8
|
21,4
|
54,8
|
262,5
|
|
А-5
|
27,2
|
20,9
|
34,3
|
4,9
|
19,7
|
107
|
|
А-2
|
0
|
33,3
|
9,6
|
0
|
0
|
42,9
|
|
Итого
|
91,9
|
231,6
|
118,5
|
46,2
|
123,4
|
611,6
|
Таблица В.2 - Анализ спектра действия изучаемых
антагонистов на тест-культуры по критерию хи-квадрат (теоретическое
распределение)
|
Штамм
|
TIG6
|
T13m
|
Z2-04
|
T2ec
|
Bip
|
|
А
- 1
|
29,932112
|
38,59581
|
15,04748
|
40,19176
|
|
А
- 1(1)
|
39,443672
|
99,40320471
|
50,86045
|
19,82914
|
52,96354
|
|
А
- 5
|
16,077992
|
40,51863963
|
20,73169
|
8,082734
|
21,58895
|
|
А
- 2
|
6,4462230
|
16,24532374
|
8,31205
|
3,240647
|
8,655755
|
Хи-квадрат = 95,6399364351833
Число степеней свободы = 12
Хи-квадрат табличное = 21
Приложение В
Влияние различных разведений культурального
фильтрата штаммов-антагонистов на прорастание конидий гриба р. Bipolaris
(обязательное)
Таблица Б.1 - Влияние различных разведений
культурального фильтрата штаммов-антагонистов на прорастание конидий гриба р. Bipolaris1
|
Разведение
|
Контроль,
%
|
А-1,
%
|
А-1(1),
%
|
А-5,
%
|
А-2,
%
|
|
Всего
|
Пр.
|
Всего
|
Пр.
|
Всего
|
Пр.
|
Всего
|
Пр.
|
Всего
|
Пр.
|
|
1
: 1
|
110
|
76
|
120
|
17
|
91
|
60
|
131
|
8
|
103
|
34
|
|
1
: 3
|
110
|
76
|
131
|
54
|
-
|
-
|
118
|
18
|
121
|
59
|
|
1
: 7
|
110
|
76
|
126
|
49
|
-
|
-
|
105
|
38
|
63
|
44
|
Время прорастания 3,0 ч; температура + 26 ºС
Приложение Г
Двухвыборочный t-тест с одинаковыми дисперсиями
различия между изолятами по антагонистической активности
(обязательное)
Таблица Г.1 - Двухвыборочный t-тест с
одинаковыми дисперсиями различия между изолятами по антагонистической
активности в отношении гриба р. Bipolaris
|
|
Контроль
|
Т-2
|
|
|
Среднее
|
0,816901408
|
0,17307692
|
|
|
Дисперсия
|
0,151710262
|
0,1459276
|
|
|
Наблюдения
|
71
|
52
|
|
|
Объединенная
дисперсия
|
0,149272942
|
|
|
|
Гипотетическая
разность средних
|
0
|
|
|
|
Df
|
121
|
|
|
|
t-статистика
|
9,129673228
|
|
|
|
P(T<=t)
одностороннее
|
9,53009E-16
|
|
|
|
t
критическое одностороннее
|
1,657544999
|
|
|
|
P(T<=t)
двухстороннее
|
1,90602E-15
|
|
|
|
t
критическое двухстороннее
|
1,979765329
|
|
|
|
|
Контроль
|
Т-7
|
|
|
1
|
2
|
3
|
|
|
Среднее
|
0,816901408
|
0,5625
|
|
|
Дисперсия
|
0,151710262
|
0,251329787
|
|
|
Наблюдения
|
71
|
48
|
|
|
Объединенная
дисперсия
|
0,191728362
|
|
|
|
Гипотетическая
разность средних
|
0
|
|
|
|
Df
|
117
|
|
|
|
t-статистика
|
3,109228523
|
|
|
|
P(T<=t)
одностороннее
|
0,001177935
|
|
|
|
t
критическое одностороннее
|
1,657981556
|
|
|
|
P(T<=t)
двухстороннее
|
0,00235587
|
|
|
|
t
критическое двухстороннее
|
1,98044745
|
|
|
|
|
Контроль
|
Т-3
|
|
|
1
|
2
|
3
|
|
|
Среднее
|
0,816901408
|
0,56666667
|
|
|
Дисперсия
|
0,151710262
|
0,24971751
|
|
|
Наблюдения
|
71
|
60
|
|
|
Объединенная
дисперсия
|
0,196535284
|
|
|
|
Гипотетическая
разность средних
|
0
|
|
|
|
Df
|
129
|
|
|
|
t-статистика
|
3,218818524
|
|
|
|
P(T<=t)
одностороннее
|
0,000814166
|
|
|
|
t
критическое одностороннее
|
1,656751465
|
|
|
|
P(T<=t)
двухстороннее
|
0,001628331
|
|
|
|
t
критическое двухстороннее
|
1,978523869
|
|
|
|
|
Контроль
|
Т-4
|
|
|
Среднее
|
0,816901408
|
0,34
|
|
|
Дисперсия
|
0,151710262
|
0,228979592
|
|
|
Наблюдения
|
71
|
50
|
|
|
Объединенная
дисперсия
|
0,183527045
|
|
|
|
Гипотетическая
разность средних
|
0
|
|
|
|
Df
|
119
|
|
|
|
t-статистика
|
6,029760478
|
|
|
|
P(T<=t)
одностороннее
|
9,48919E-09
|
|
|
|
t
критическое одностороннее
|
1,65775873
|
|
|
|
P(T<=t)
двухстороннее
|
1,89784E-08
|
|
|
|
t
критическое двухстороннее
|
1,980097295
|
|
|
|
Контроль
|
Т-6
|
|
|
Среднее
|
0,816901408
|
0,655172414
|
|
|
Дисперсия
|
0,151710262
|
0,229885057
|
|
|
Наблюдения
|
71
|
58
|
|
|
Объединенная
дисперсия
|
0,186796587
|
|
|
|
Гипотетическая
разность средних
|
0
|
|
|
|
Df
|
127
|
|
|
|
t-статистика
|
2,114227581
|
|
|
|
P(T<=t)
одностороннее
|
0,018225484
|
|
|
|
t
критическое одностороннее
|
1,656940185
|
|
|
|
P(T<=t)
двухстороннее
|
0,036450968
|
|
|
|
t
критическое двухстороннее
|
1,978819455
|
|
|
|
|
Контроль
|
Т10
|
|
1
|
2
|
3
|
|
Среднее
|
0,816901408
|
0,58
|
|
Дисперсия
|
0,151710262
|
0,24857143
|
|
Наблюдения
|
71
|
50
|
|
Объединенная
дисперсия
|
0,191594272
|
|
|
Гипотетическая
разность средних
|
0
|
|
|
Df
|
119
|
|
|
t-статистика
|
2,931553836
|
|
|
P(T<=t)
одностороннее
|
0,002022758
|
|
|
t
критическое одностороннее
|
1,65775873
|
|
|
P(T<=t)
двухстороннее
|
0,004045516
|
|
|
t
критическое двухстороннее
|
1,980097295
|
|
|
|
Контроль
|
Т12
|
|
Среднее
|
0,816901408
|
0,62903226
|
|
Дисперсия
|
0,151710262
|
0,2371761
|
|
Наблюдения
|
71
|
62
|
|
Объединенная
дисперсия
|
0,19150733
|
|
|
Гипотетическая
разность средних
|
0
|
|
|
Df
|
131
|
|
|
t-статистика
|
2,46980104
|
|
|
P(T<=t)
одностороннее
|
0,007402474
|
|
|
t
критическое одностороннее
|
1,656567292
|
|
|
P(T<=t)
двухстороннее
|
0,014804949
|
|
|
t
критическое двухстороннее
|
1,978237378
|
|
|
|
Контроль
|
Т11
|
|
Среднее
|
0,816901408
|
0,23076923
|
|
Дисперсия
|
0,151710262
|
0,18099548
|
|
Наблюдения
|
71
|
52
|
|
Объединенная
дисперсия
|
0,164053616
|
|
|
Гипотетическая
разность средних
|
0
|
|
|
Df
|
121
|
|
|
t-статистика
|
7,928315986
|
|
|
P(T<=t)
одностороннее
|
6,20042E-13
|
|
|
t
критическое одностороннее
|
1,657544999
|
|
|
P(T<=t)
двухстороннее
|
1,24008E-12
|
|
|
t
критическое двухстороннее
|
1,979765329
|
|
|
Контроль
|
Д4
|
|
1
|
2
|
3
|
|
Среднее
|
0,816901408
|
0,01282051
|
|
Дисперсия
|
0,151710262
|
0,01282051
|
|
Наблюдения
|
71
|
78
|
|
Объединенная
дисперсия
|
0,078958488
|
|
|
Гипотетическая
разность средних
|
0
|
|
|
Df
|
147
|
|
|
t-статистика
|
17,44551009
|
|
|
P(T<=t)
одностороннее
|
6,19538E-38
|
|
|
t
критическое одностороннее
|
1,655284905
|
|
|
P(T<=t)
двухстороннее
|
1,23908E-37
|
|
|
|
Контроль
|
Д1
|
|
|
Среднее
|
0,816901408
|
0,581395349
|
|
|
Дисперсия
|
0,151710262
|
|
|
Наблюдения
|
71
|
43
|
|
|
Объединенная
дисперсия
|
0,188257452
|
|
|
|
Гипотетическая
разность средних
|
0
|
|
|
|
Df
|
112
|
|
|
|
t-статистика
|
2,808904506
|
|
|
|
P(T<=t)
одностороннее
|
0,002933561
|
|
|
|
t
критическое одностороннее
|
1,658572728
|
|
|
|
P(T<=t)
двухстороннее
|
0,005867121
|
|
|
|
t
критическое двухстороннее
|
1,981370588
|
|
|
|
|
Контроль
|
Д2
|
|
|
Среднее
|
0,816901408
|
0,02173913
|
|
|
Дисперсия
|
0,151710262
|
0,021500239
|
|
|
Наблюдения
|
71
|
92
|
|
|
Объединенная
дисперсия
|
0,078113292
|
|
|
|
Гипотетическая
разность средних
|
0
|
|
|
|
Df
|
161
|
|
|
|
t-статистика
|
18,01036788
|
|
|
|
P(T<=t)
одностороннее
|
1,00785E-40
|
|
|
|
t
критическое одностороннее
|
1,654373136
|
|
|
|
P(T<=t)
двухстороннее
|
2,0157E-40
|
|
|
|
t
критическое двухстороннее
|
1,974808583
|
|
|
|
Контроль
|
Д-26
|
|
1
|
2
|
3
|
|
Среднее
|
0,816901408
|
0,109589041
|
|
Дисперсия
|
0,151710262
|
0,098934551
|
|
Наблюдения
|
71
|
73
|
|
Объединенная
дисперсия
|
0,124950746
|
|
|
Гипотетическая
разность средних
|
0
|
|
|
Df
|
142
|
|
|
t-статистика
|
12,00469645
|
|
|
P(T<=t)
одностороннее
|
1,17038E-23
|
|
|
t
критическое одностороннее
|
1,655655524
|
|
|
P(T<=t)
двухстороннее
|
2,34076E-23
|
|
|
t
критическое двухстороннее
|
1,976809472
|
|
|
|
Контроль
|
Д14
|
|
|
Среднее
|
0,816901408
|
0,07216495
|
|
|
Дисперсия
|
0,151710262
|
0,06765464
|
|
|
Наблюдения
|
71
|
97
|
|
|
Объединенная
дисперсия
|
0,103099781
|
|
|
|
Гипотетическая
разность средних
|
0
|
|
|
|
Df
|
166
|
|
|
|
t-статистика
|
14,850263
|
|
|
|
P(T<=t)
одностороннее
|
1,38954E-32
|
|
|
|
t
критическое одностороннее
|
1,654084372
|
|
|
|
P(T<=t)
двухстороннее
|
2,77908E-32
|
|
|
|
t
критическое двухстороннее
|
1,974358383
|
|
|
|
|
Контроль
|
Д17
|
|
|
Среднее
|
0,816901408
|
0,6
|
|
|
Дисперсия
|
0,151710262
|
0,24489796
|
|
|
Наблюдения
|
71
|
50
|
|
|
Гипотетическая
разность средних
|
0
|
|
|
|
Df
|
119
|
|
|
|
t-статистика
|
2,694720635
|
|
|
|
P(T<=t)
одностороннее
|
0,004032061
|
|
|
|
t
критическое одностороннее
|
1,65775873
|
|
|
|
P(T<=t)
двухстороннее
|
0,008064122
|
|
|
|
t
критическое двухстороннее
|
1,980097295
|
|
|
|
|
Контроль
|
Д16
|
|
|
1
|
2
|
3
|
|
|
Среднее
|
0,816901408
|
0,35714286
|
|
|
Дисперсия
|
0,151710262
|
0,23291925
|
|
|
Наблюдения
|
71
|
70
|
|
|
Объединенная
дисперсия
|
0,192022639
|
|
|
|
Гипотетическая
разность средних
|
0
|
|
|
|
Df
|
139
|
|
|
|
t-статистика
|
6,229056014
|
|
|
|
P(T<=t)
одностороннее
|
2,61715E-09
|
|
|
|
t
критическое одностороннее
|
1,655889719
|
|
|
|
P(T<=t)
двухстороннее
|
5,23429E-09
|
|
|
|
t
критическое двухстороннее
|
1,977177817
|
|
|
|
Контроль
|
В-1
|
|
|
Среднее
|
0,816901408
|
0,25
|
|
|
Дисперсия
|
0,151710262
|
0,19067797
|
|
|
Наблюдения
|
71
|
60
|
|
|
Объединенная
дисперсия
|
0,1695327
|
|
|
|
Гипотетическая
разность средних
|
0
|
|
|
|
Df
|
129
|
|
|
|
t-статистика
|
7,851451427
|
|
|
|
P(T<=t)
одностороннее
|
6,94555E-13
|
|
|
|
t
критическое одностороннее
|
1,656751465
|
|
|
|
P(T<=t)
двухстороннее
|
1,38911E-12
|
|
|
|
t
критическое двухстороннее
|
1,978523869
|
|
|
|
|
Контроль
|
В11
|
|
|
Среднее
|
0,816901408
|
0,10989011
|
|
|
Дисперсия
|
0,151710262
|
0,098901099
|
|
|
Наблюдения
|
71
|
91
|
|
|
Объединенная
дисперсия
|
0,122005108
|
|
|
|
Гипотетическая
разность средних
|
0
|
|
|
|
Df
|
160
|
|
|
|
t-статистика
|
12,78290942
|
|
|
|
P(T<=t)
одностороннее
|
1,56288E-26
|
|
|
|
t
критическое одностороннее
|
1,654432253
|
|
|
|
P(T<=t)
двухстороннее
|
3,12576E-26
|
|
|
|
t
критическое двухстороннее
|
1,97490408
|
|
|
|
Контроль
|
В5
|
|
|
1
|
2
|
3
|
|
|
Среднее
|
0,816901408
|
0,32941176
|
|
|
Дисперсия
|
0,151710262
|
0,22352941
|
|
|
Наблюдения
|
71
|
85
|
|
|
Объединенная
дисперсия
|
0,190884343
|
|
|
|
Гипотетическая
разность средних
|
0
|
|
|
|
Df
|
154
|
|
|
|
t-статистика
|
6,939953774
|
|
|
|
P(T<=t)
одностороннее
|
5,12296E-11
|
|
|
|
t
критическое одностороннее
|
1,65480742
|
|
|
|
P(T<=t)
двухстороннее
|
1,02459E-10
|
|
|
|
t
критическое двухстороннее
|
1,975486157
|
|
|
|
|
Контроль
|
В10
|
|
|
Среднее
|
0,816901408
|
0
|
|
|
Дисперсия
|
0,151710262
|
0
|
|
|
Наблюдения
|
71
|
54
|
|
|
Объединенная
дисперсия
|
0,086339173
|
|
|
|
Гипотетическая
разность средних
|
0
|
|
|
|
Df
|
123
|
|
|
|
t-статистика
|
15,39702269
|
|
|
|
P(T<=t)
одностороннее
|
9,02691E-31
|
|
|
|
t
критическое одностороннее
|
1,657335815
|
|
|
|
P(T<=t)
двухстороннее
|
1,80538E-30
|
|
|
|
t
критическое двухстороннее
|
1,979437911
|
|
|
|
|
Контроль
|
В7
|
|
|
Среднее
|
0,816901408
|
0,32727273
|
|
|
Дисперсия
|
0,151710262
|
0,22424242
|
|
|
Наблюдения
|
71
|
55
|
|
|
Объединенная
дисперсия
|
0,183296849
|
|
|
|
Гипотетическая
разность средних
|
0
|
|
|
|
Df
|
124
|
|
|
|
t-статистика
|
6,366703092
|
|
|
|
P(T<=t)
одностороннее
|
1,70492E-09
|
|
|
|
t
критическое одностороннее
|
1,657235771
|
|
|
|
P(T<=t)
двухстороннее
|
3,40984E-09
|
|
|
|
t
критическое двухстороннее
|
1,97927875
|
|
|
|
|
Контроль
|
Ц-2
|
|
|
1
|
2
|
3
|
|
|
Среднее
|
0,816901408
|
0,13636364
|
|
|
Дисперсия
|
0,151710262
|
0,11958042
|
|
|
Наблюдения
|
71
|
66
|
|
|
Объединенная
дисперсия
|
0,136240338
|
|
|
|
Гипотетическая
разность средних
|
0
|
|
|
|
Df
|
135
|
|
|
|
t-статистика
|
10,78301571
|
|
|
|
P(T<=t)
одностороннее
|
3,06409E-20
|
|
|
|
t
критическое одностороннее
|
1,656219411
|
|
|
|
P(T<=t)
двухстороннее
|
6,12818E-20
|
|
|
|
t
критическое двухстороннее
|
1,977691682
|
|
|
|
|
Контроль
|
Ц7
|
|
|
Среднее
|
0,816901408
|
0,386363636
|
|
|
Дисперсия
|
0,151710262
|
0,239811912
|
|
|
Наблюдения
|
71
|
88
|
|
|
Объединенная
дисперсия
|
0,200530921
|
|
|
|
Гипотетическая
разность средних
|
0
|
157
|
|
|
|
t-статистика
|
6,026879837
|
|
|
|
P(T<=t)
одностороннее
|
5,74158E-09
|
|
|
|
t
критическое одностороннее
|
1,654616426
|
|
|
|
P(T<=t)
двухстороннее
|
1,14832E-08
|
|
|
|
t
критическое двухстороннее
|
1,975190571
|
|
|
|
|
Контроль
|
Ц5
|
|
|
Среднее
|
0,816901408
|
0,53409091
|
|
|
Дисперсия
|
0,151710262
|
0,25169801
|
|
|
Наблюдения
|
71
|
88
|
|
|
Объединенная
дисперсия
|
0,207117488
|
|
|
|
Гипотетическая
разность средних
|
0
|
|
|
|
Df
|
157
|
|
|
|
t-статистика
|
3,895463075
|
|
|
|
P(T<=t)
одностороннее
|
7,23611E-05
|
|
|
|
t
критическое одностороннее
|
1,654616426
|
|
|
|
P(T<=t)
двухстороннее
|
0,000144722
|
|
|
|
t
критическое двухстороннее
|
1,975190571
|
|
|
|
|
Контроль
|
Ц1
|
|
|
1
|
2
|
3
|
|
|
Среднее
|
0,816901408
|
0,00980392
|
|
|
Дисперсия
|
0,151710262
|
0,00980392
|
|
|
Наблюдения
|
71
|
102
|
|
|
Объединенная
дисперсия
|
0,067894236
|
|
|
|
Df
|
171
|
|
|
|
t-статистика
|
20,04083213
|
|
|
|
P(T<=t)
одностороннее
|
4,81226E-47
|
|
|
|
t
критическое одностороннее
|
1,653813797
|
|
|
|
P(T<=t)
двухстороннее
|
9,62452E-47
|
|
|
|
t
критическое двухстороннее
|
1,973935468
|
|
|
|
|
|
|
|
|
|
|
|
|
Таблица Г.2 - Двухвыборочный t-тест с
одинаковыми дисперсиями различия между изолятами по антагонистической
активности в отношении гриба р. Fusarium
(TIG6)
|
|
Контроль
|
Т-8
|
|
1
|
2
|
3
|
|
Среднее
|
0,805970149
|
0,545454545
|
|
Дисперсия
|
0,158751696
|
0,252525253
|
|
Наблюдения
|
67
|
55
|
|
df
|
120
|
|
|
t-статистика
|
3,19395495
|
|
|
P(T<=t)
одностороннее
|
0,000896414
|
|
|
t
критическое одностороннее
|
1,657649591
|
|
|
P(T<=t)
двухстороннее
|
0,001792829
|
|
|
t
критическое двухстороннее
|
1,979929038
|
|
|
|
Контроль
|
Т-3
|
|
Среднее
|
0,805970149
|
0,56
|
|
Дисперсия
|
0,158751696
|
0,251428571
|
|
Наблюдения
|
67
|
50
|
|
Гипотетическая
разность средних
|
0
|
|
|
Df
|
115
|
|
|
t-статистика
|
2,956079564
|
|
|
P(T<=t)
одностороннее
|
0,001890604
|
|
|
t
критическое одностороннее
|
1,658211204
|
|
|
P(T<=t)
двухстороннее
|
0,003781207
|
|
|
t
критическое двухстороннее
|
1,980806701
|
|
|
|
Контроль
|
Т-1
|
|
1
|
2
|
3
|
|
Среднее
|
0,805970149
|
0,02
|
|
Дисперсия
|
0,158751696
|
0,02
|
|
Наблюдения
|
67
|
50
|
|
Объединенная
дисперсия
|
0,099631408
|
|
|
Гипотетическая
разность средних
|
0
|
|
|
Df
|
115
|
|
|
t-статистика
|
13,32408487
|
|
|
P(T<=t)
одностороннее
|
2,2957E-25
|
|
|
t
критическое одностороннее
|
1,658211204
|
|
|
P(T<=t)
двухстороннее
|
4,59139E-25
|
|
|
t
критическое двухстороннее
|
1,980806701
|
|
|
Контроль
|
Т-2
|
|
Среднее
|
0,805970149
|
0,5
|
|
Дисперсия
|
0,158751696
|
0,254237288
|
|
Наблюдения
|
67
|
60
|
|
Объединенная
дисперсия
|
0,203820896
|
|
|
Гипотетическая
разность средних
|
0
|
|
|
Df
|
125
|
|
|
t-статистика
|
3,812991804
|
|
|
P(T<=t)
одностороннее
|
0,000107266
|
|
|
t
критическое одностороннее
|
1,657135726
|
|
|
P(T<=t)
двухстороннее
|
0,000214533
|
|
|
t
критическое двухстороннее
|
1,979124136
|
|
|
|
Контроль
|
Т-4
|
|
Среднее
|
0,805970149
|
0,961538462
|
|
Дисперсия
|
0,158751696
|
0,037707391
|
|
Наблюдения
|
67
|
52
|
|
Объединенная
дисперсия
|
0,105988794
|
|
|
Гипотетическая
разность средних
|
0
|
|
|
Df
|
117
|
|
|
t-статистика
|
-2,585572726
|
|
|
P(T<=t)
одностороннее
|
0,005474492
|
|
|
t
критическое одностороннее
|
1,657981556
|
|
|
P(T<=t)
двухстороннее
|
0,010948984
|
|
|
t
критическое двухстороннее
|
1,98044745
|
|
|
|
Контроль
|
Т-15
|
|
1
|
2
|
3
|
|
Среднее
|
0,805970149
|
0,490196078
|
|
Дисперсия
|
0,158751696
|
0,254901961
|
|
Наблюдения
|
67
|
51
|
|
Объединенная
дисперсия
|
0,200195776
|
|
|
Гипотетическая
разность средних
|
0
|
|
|
Df
|
116
|
|
|
t-статистика
|
3,797786068
|
|
|
P(T<=t)
одностороннее
|
0,000116976
|
|
|
t
критическое одностороннее
|
1,658095243
|
|
|
P(T<=t)
двухстороннее
|
0,000233952
|
|
|
t
критическое двухстороннее
|
1,980624802
|
|
|
|
Контроль
|
Т-16
|
|
Среднее
|
0,805970149
|
0,64516129
|
|
Дисперсия
|
0,158751696
|
0,232681121
|
|
Наблюдения
|
67
|
62
|
|
Объединенная
дисперсия
|
0,194261105
|
|
|
Гипотетическая
разность средних
|
0
|
|
|
Df
|
127
|
|
|
t-статистика
|
2,070405601
|
|
|
P(T<=t)
одностороннее
|
0,020220256
|
|
|
t
критическое одностороннее
|
1,656940185
|
|
|
P(T<=t)
двухстороннее
|
0,040440513
|
|
|
t
критическое двухстороннее
|
1,978819455
|
|
|
|
Контроль
|
Т9
|
|
Среднее
|
0,805970149
|
0,232142857
|
|
Дисперсия
|
0,158751696
|
0,181493506
|
|
Наблюдения
|
67
|
56
|
|
Объединенная
дисперсия
|
0,169088883
|
|
|
Гипотетическая
разность средних
|
0
|
|
|
Df
|
121
|
|
|
t-статистика
|
7,707304761
|
|
|
P(T<=t)
одностороннее
|
1,98954E-12
|
|
|
t
критическое одностороннее
|
1,657544999
|
|
|
P(T<=t)
двухстороннее
|
3,97907E-12
|
|
|
t
критическое двухстороннее
|
1,979765329
|
|
|
|
Контроль
|
Т12
|
|
1
|
2
|
3
|
|
Среднее
|
0,805970149
|
0,142857143
|
|
Дисперсия
|
0,158751696
|
0,12406015
|
|
Наблюдения
|
67
|
77
|
|
Объединенная
дисперсия
|
0,14018439
|
|
|
Гипотетическая
разность средних
|
0
|
|
|
df
|
142
|
|
|
t-статистика
|
10,60081453
|
|
|
P(T<=t)
одностороннее
|
5,26238E-20
|
|
|
t
критическое одностороннее
|
1,655655524
|
|
|
P(T<=t)
двухстороннее
|
1,05248E-19
|
|
|
t
критическое двухстороннее
|
1,976809472
|
|
|
|
Контроль
|
Д-24
|
|
Среднее
|
0,805970149
|
0,089552239
|
|
Дисперсия
|
0,158751696
|
0,082767978
|
|
Наблюдения
|
67
|
67
|
|
Объединенная
дисперсия
|
0,120759837
|
|
|
Гипотетическая
разность средних
|
0
|
|
|
Df
|
132
|
|
|
t-статистика
|
11,93239383
|
|
|
P(T<=t)
одностороннее
|
5,07811E-23
|
|
|
t
критическое одностороннее
|
1,656478616
|
1,01562E-22
|
|
|
t
критическое двухстороннее
|
1,978096407
|
|
|
|
Контроль
|
Д14
|
|
Среднее
|
0,805970149
|
0,197530864
|
|
Дисперсия
|
0,158751696
|
0,160493827
|
|
Наблюдения
|
67
|
81
|
|
Объединенная
дисперсия
|
0,159706288
|
|
|
Гипотетическая
разность средних
|
0
|
|
|
Df
|
146
|
|
|
t-статистика
|
9,219455916
|
|
|
P(T<=t)
одностороннее
|
1,5293E-16
|
|
|
t
критическое одностороннее
|
1,655357664
|
|
|
P(T<=t)
двухстороннее
|
3,0586E-16
|
|
|
t
критическое двухстороннее
|
1,976345629
|
|
|
|
Контроль
|
Д15
|
|
1
|
2
|
3
|
|
Среднее
|
0,805970149
|
0,053333333
|
|
Дисперсия
|
0,158751696
|
0,051171171
|
|
Наблюдения
|
67
|
75
|
|
Объединенная
дисперсия
|
0,101887704
|
|
|
Гипотетическая
разность средних
|
0
|
|
|
Df
|
140
|
|
|
t-статистика
|
14,02647141
|
|
|
P(T<=t)
одностороннее
|
9,11553E-29
|
|
|
t
критическое одностороннее
|
1,655810138
|
|
|
P(T<=t)
двухстороннее
|
1,82311E-28
|
|
|
t
критическое двухстороннее
|
1,977055035
|
|
|
|
Контроль
|
Д21
|
|
Среднее
|
0,805970149
|
0,52
|
|
Дисперсия
|
0,158751696
|
0,252972973
|
|
Наблюдения
|
67
|
75
|
|
Объединенная
дисперсия
|
0,208554371
|
|
|
Гипотетическая
разность средних
|
0
|
|
|
Df
|
140
|
|
|
t-статистика
|
3,725074086
|
|
|
P(T<=t)
одностороннее
|
0,000141173
|
|
|
t
критическое одностороннее
|
1,655810138
|
|
|
P(T<=t)
двухстороннее
|
0,000282347
|
|
|
t
критическое двухстороннее
|
1,977055035
|
|
|
|
Контроль
|
Д20
|
|
Среднее
|
0,805970149
|
0,274193548
|
|
Дисперсия
|
0,158751696
|
0,202273929
|
|
Наблюдения
|
67
|
62
|
|
Объединенная
дисперсия
|
0,179656076
|
|
|
Гипотетическая
разность средних
|
0
|
|
|
df
|
127
|
|
|
t-статистика
|
7,119453537
|
|
|
P(T<=t)
одностороннее
|
3,55573E-11
|
|
|
t
критическое одностороннее
|
1,656940185
|
|
|
P(T<=t)
двухстороннее
|
7,11147E-11
|
|
|
t
критическое двухстороннее
|
1,978819455
|
|
|
|
Контроль
|
Д17
|
|
1
|
2
|
3
|
|
Среднее
|
0,805970149
|
0,96
|
|
Дисперсия
|
0,158751696
|
0,039183673
|
|
Наблюдения
|
67
|
50
|
|
Объединенная
дисперсия
|
0,107805321
|
|
|
Гипотетическая
разность средних
|
0
|
|
|
Df
|
115
|
|
|
t-статистика
|
-2,510234351
|
|
|
P(T<=t)
одностороннее
|
0,006727791
|
|
|
t
критическое одностороннее
|
1,658211204
|
|
|
P(T<=t)
двухстороннее
|
0,013455583
|
|
|
t
критическое двухстороннее
|
1,980806701
|
|
|
|
Контроль
|
Д16
|
|
Среднее
|
0,805970149
|
0,016666667
|
|
Дисперсия
|
0,158751696
|
0,016666667
|
|
Наблюдения
|
67
|
60
|
|
Объединенная
дисперсия
|
0,091687562
|
|
|
Гипотетическая
разность средних
|
0
|
|
|
Df
|
125
|
|
|
t-статистика
|
14,66560461
|
|
|
P(T<=t)
одностороннее
|
3,0351E-29
|
|
|
t
критическое одностороннее
|
1,657135726
|
|
|
P(T<=t)
двухстороннее
|
6,07019E-29
|
|
|
t
критическое двухстороннее
|
1,979124136
|
|
|
|
Контроль
|
Д23
|
|
Среднее
|
0,805970149
|
0,42
|
|
Дисперсия
|
0,158751696
|
0,248571429
|
|
Наблюдения
|
67
|
50
|
|
Объединенная
дисперсия
|
0,197022713
|
|
|
Гипотетическая
разность средних
|
0
|
|
|
Df
|
115
|
|
|
t-статистика
|
4,652914193
|
|
|
P(T<=t)
одностороннее
|
4,41009E-06
|
|
|
t
критическое одностороннее
|
1,658211204
|
|
|
P(T<=t)
двухстороннее
|
8,82019E-06
|
|
|
t
критическое двухстороннее
|
1,980806701
|
|
|
|
Контроль
|
Д12
|
|
1
|
2
|
3
|
|
Среднее
|
0,805970149
|
0,112676056
|
|
Дисперсия
|
0,158751696
|
0,101408451
|
|
Наблюдения
|
67
|
71
|
|
Объединенная
дисперсия
|
0,12923679
|
|
|
Гипотетическая
разность средних
|
0
|
|
|
Df
|
136
|
|
|
t-статистика
|
11,3227378
|
|
|
P(T<=t)
одностороннее
|
1,19071E-21
|
|
|
t
критическое одностороннее
|
1,656135282
|
|
|
P(T<=t)
двухстороннее
|
2,38142E-21
|
|
|
t
критическое двухстороннее
|
1,977559805
|
|
|
|
Контроль
|
Д16
|
|
Среднее
|
0,805970149
|
0,657142857
|
|
Дисперсия
|
0,158751696
|
0,228571429
|
|
Наблюдения
|
67
|
70
|
|
Объединенная
дисперсия
|
0,194437337
|
|
|
Гипотетическая
разность средних
|
0
|
|
|
Df
|
135
|
|
|
t-статистика
|
1,974780751
|
|
|
P(T<=t)
одностороннее
|
0,025166723
|
|
|
t
критическое одностороннее
|
1,656219411
|
|
|
P(T<=t)
двухстороннее
|
0,050333445
|
|
|
|
Контроль
|
В3
|
|
Среднее
|
0,805970149
|
0,94
|
|
Дисперсия
|
0,158751696
|
0,05755102
|
|
Наблюдения
|
67
|
50
|
|
Объединенная
дисперсия
|
0,115631408
|
|
|
Гипотетическая
разность средних
|
0
|
|
|
Df
|
115
|
|
|
t-статистика
|
-2,109080223
|
|
|
P(T<=t)
одностороннее
|
0,018553734
|
|
|
t
критическое одностороннее
|
1,658211204
|
|
|
P(T<=t)
двухстороннее
|
0,037107468
|
|
|
t
критическое двухстороннее
|
1,980806701
|
|
|
|
Контроль
|
В2
|
|
1
|
2
|
3
|
|
Среднее
|
0,805970149
|
0,307692308
|
|
Дисперсия
|
0,158751696
|
0,216346154
|
|
Наблюдения
|
67
|
65
|
|
Объединенная
дисперсия
|
0,187105891
|
|
|
Гипотетическая
разность средних
|
0
|
|
|
Df
|
130
|
|
|
t-статистика
|
6,616601183
|
|
|
P(T<=t)
одностороннее
|
4,36128E-10
|
|
|
t
критическое одностороннее
|
1,656658242
|
|
|
P(T<=t)
двухстороннее
|
8,72256E-10
|
|
|
t
критическое двухстороннее
|
1,97837835
|
|
|
|
Контроль
|
В4
|
|
Среднее
|
0,805970149
|
0,144578313
|
|
Дисперсия
|
0,158751696
|
0,125183661
|
|
Наблюдения
|
67
|
83
|
|
Объединенная
дисперсия
|
0,14015319
|
|
|
Гипотетическая
разность средних
|
0
|
|
|
df
|
148
|
|
|
t-статистика
|
10,75692532
|
|
|
P(T<=t)
одностороннее
|
1,33695E-20
|
|
|
t
критическое одностороннее
|
1,655214419
|
|
|
P(T<=t)
двухстороннее
|
2,67391E-20
|
|
|
t
критическое двухстороннее
|
1,976122803
|
|
|
|
В7
|
|
Среднее
|
0,805970149
|
0,337662338
|
|
Дисперсия
|
0,158751696
|
0,2265892
|
|
Наблюдения
|
67
|
77
|
|
Объединенная
дисперсия
|
0,195059093
|
|
|
Гипотетическая
разность средних
|
0
|
|
|
Df
|
142
|
|
|
t-статистика
|
6,346727033
|
|
|
P(T<=t)
одностороннее
|
1,3855E-09
|
|
|
t
критическое одностороннее
|
1,655655524
|
|
|
P(T<=t)
двухстороннее
|
2,77101E-09
|
|
|
t
критическое двухстороннее
|
1,976809472
|
|
|
|
Контроль
|
В6
|
|
1
|
2
|
3
|
|
Среднее
|
0,805970149
|
0,442307692
|
|
Дисперсия
|
0,158751696
|
0,251508296
|
|
Наблюдения
|
67
|
52
|
|
Объединенная
дисперсия
|
0,19918406
|
|
|
Гипотетическая
разность средних
|
0
|
|
|
Df
|
117
|
|
|
t-статистика
|
4,408966214
|
|
|
P(T<=t)
одностороннее
|
1,15946E-05
|
|
|
t
критическое одностороннее
|
1,657981556
|
|
|
P(T<=t)
двухстороннее
|
2,31891E-05
|
|
|
t
критическое двухстороннее
|
1,98044745
|
|
|
|
Контроль
|
В9
|
|
Среднее
|
0,805970149
|
0,4875
|
|
Дисперсия
|
0,158751696
|
0,253006329
|
|
Наблюдения
|
67
|
80
|
|
Объединенная
дисперсия
|
0,21010422
|
|
|
Гипотетическая
разность средних
|
0
|
|
|
Df
|
145
|
|
|
t-статистика
|
4,195416394
|
|
|
P(T<=t)
одностороннее
|
2,36192E-05
|
|
|
t
критическое одностороннее
|
1,655430424
|
|
|
P(T<=t)
двухстороннее
|
4,72384E-05
|
|
|
t
критическое двухстороннее
|
1,976459316
|
|
|
|
Контроль
|
В12
|
|
Среднее
|
0,805970149
|
0,646153846
|
|
Дисперсия
|
0,158751696
|
0,232211538
|
|
Наблюдения
|
67
|
65
|
|
Объединенная
дисперсия
|
0,194916542
|
|
|
Гипотетическая
разность средних
|
0
|
|
|
Df
|
130
|
|
|
t-статистика
|
2,079236287
|
|
|
P(T<=t)
одностороннее
|
0,01978052
|
|
|
t
критическое одностороннее
|
1,656658242
|
|
|
P(T<=t)
двухстороннее
|
0,03956104
|
|
|
t
критическое двухстороннее
|
1,97837835
|
|
|
|
Контроль
|
Ц-3
|
|
1
|
2
|
3
|
|
Среднее
|
0,805970149
|
0,517241379
|
|
Дисперсия
|
0,158751696
|
0,254083485
|
|
Наблюдения
|
67
|
58
|
|
Объединенная
дисперсия
|
0,202929842
|
|
|
Гипотетическая
разность средних
|
0
|
|
|
Df
|
123
|
|
|
t-статистика
|
3,573662161
|
|
|
P(T<=t)
одностороннее
|
0,000251871
|
|
|
t
критическое одностороннее
|
1,657335815
|
|
|
P(T<=t)
двухстороннее
|
0,000503742
|
|
|
t
критическое двухстороннее
|
1,979437911
|
|
|
|
Контроль
|
Ц-2
|
|
Среднее
|
0,805970149
|
0,576923077
|
|
Дисперсия
|
0,158751696
|
0,248868778
|
|
Наблюдения
|
67
|
52
|
|
Объединенная
дисперсия
|
0,198033501
|
|
|
Гипотетическая
разность средних
|
0
|
|
|
Df
|
117
|
|
|
t-статистика
|
2,7849731
|
|
|
P(T<=t)
одностороннее
|
0,003122927
|
|
|
t
критическое одностороннее
|
1,657981556
|
|
|
P(T<=t)
двухстороннее
|
0,006245854
|
|
|
t
критическое двухстороннее
|
1,98044745
|
|
|
|
Контроль
|
Ц7
|
|
Среднее
|
0,805970149
|
0,4
|
|
Дисперсия
|
0,158751696
|
0,244897959
|
|
Наблюдения
|
67
|
50
|
|
Объединенная
дисперсия
|
0,195457495
|
|
|
Гипотетическая
разность средних
|
0
|
|
|
Df
|
115
|
|
|
t-статистика
|
4,913572965
|
|
|
P(T<=t)
одностороннее
|
1,49563E-06
|
|
|
t
критическое одностороннее
|
1,658211204
|
|
|
P(T<=t)
двухстороннее
|
2,99126E-06
|
|
|
t
критическое двухстороннее
|
1,980806701
|
|
|
|
Контроль
|
Ц4
|
|
1
|
2
|
3
|
|
Среднее
|
0,805970149
|
0,216666667
|
|
Дисперсия
|
0,158751696
|
0,17259887
|
|
Наблюдения
|
67
|
60
|
|
Объединенная
дисперсия
|
0,165287562
|
|
|
Гипотетическая
разность средних
|
0
|
|
|
df
|
125
|
|
|
t-статистика
|
8,155114941
|
|
|
P(T<=t)
одностороннее
|
1,56866E-13
|
|
|
t
критическое одностороннее
|
1,657135726
|
|
|
P(T<=t)
двухстороннее
|
3,13732E-13
|
|
|
t
критическое двухстороннее
|
1,979124136
|
|
|
|
Контроль
|
Ц1
|
|
Среднее
|
0,805970149
|
0,476923077
|
|
Дисперсия
|
0,158751696
|
0,253365385
|
|
Наблюдения
|
67
|
65
|
|
Объединенная
дисперсия
|
0,205330743
|
|
|
Гипотетическая
разность средних
|
0
|
|
|
df
|
130
|
|
|
t-статистика
|
4,170980467
|
|
|
P(T<=t)
одностороннее
|
2,75298E-05
|
|
|
t
критическое одностороннее
|
1,656658242
|
|
|
P(T<=t)
двухстороннее
|
5,50596E-05
|
|
|
t
критическое двухстороннее
|
1,97837835
|
|
|
|
Контроль
|
Ц8
|
|
Среднее
|
0,805970149
|
0
|
|
Дисперсия
|
0,158751696
|
0
|
|
Наблюдения
|
67
|
50
|
|
Объединенная
дисперсия
|
0,091109669
|
|
|
Гипотетическая
разность средних
|
0
|
|
|
Df
|
115
|
|
|
t-статистика
|
14,2878274
|
|
|
P(T<=t)
одностороннее
|
1,49838E-27
|
|
|
t
критическое одностороннее
|
1,658211204
|
|
|
P(T<=t)
двухстороннее
|
2,99677E-27
|
|
|
t
критическое двухстороннее
|
1,980806701
|
|
|
|
|
|
|
Таблица Г.3 - Двухвыборочный t-тест с
одинаковыми дисперсиями различия между изолятами по антагонистической
активности в отношении гриба р. Fusarium
(Т2ес)
|
|
Контроль
|
Т-8
|
|
1
|
2
|
3
|
|
Среднее
|
0,946428571
|
0,764705882
|
|
Дисперсия
|
0,051623377
|
0,18261633
|
|
Наблюдения
|
56
|
68
|
|
Объединенная
дисперсия
|
0,12356213
|
|
|
Df
|
122
|
|
|
t-статистика
|
2,864864523
|
|
|
P(T<=t)
одностороннее
|
0,002456955
|
|
|
t
критическое одностороннее
|
1,657440407
|
|
|
P(T<=t)
двухстороннее
|
0,00491391
|
|
|
t
критическое двухстороннее
|
1,97960162
|
|
|
|
Контроль
|
Т-6
|
|
Среднее
|
0,946428571
|
0,561403509
|
|
Дисперсия
|
0,051623377
|
0,250626566
|
|
Наблюдения
|
56
|
57
|
|
Объединенная
дисперсия
|
0,152021382
|
|
|
Гипотетическая
разность средних
|
0
|
|
|
Df
|
111
|
|
|
t-статистика
|
5,248423619
|
|
|
P(T<=t)
одностороннее
|
3,72121E-07
|
|
|
t
критическое одностороннее
|
1,658697784
|
|
|
P(T<=t)
двухстороннее
|
7,44243E-07
|
|
|
t
критическое двухстороннее
|
1,981566129
|
|
|
|
Контроль
|
Т-3
|
|
Среднее
|
0,946428571
|
|
Дисперсия
|
0,051623377
|
0,209276018
|
|
Наблюдения
|
56
|
52
|
|
Объединенная
дисперсия
|
0,127475119
|
|
|
df
|
106
|
|
|
t-статистика
|
9,569191113
|
|
|
P(T<=t)
одностороннее
|
2,61664E-16
|
|
|
t
критическое одностороннее
|
1,659354893
|
|
|
P(T<=t)
двухстороннее
|
5,23328E-16
|
|
|
t
критическое двухстороннее
|
1,982598405
|
|
|
|
Контроль
|
Т-1
|
|
1
|
2
|
3
|
|
Среднее
|
0,946428571
|
0
|
|
Дисперсия
|
0,051623377
|
0
|
|
Наблюдения
|
56
|
57
|
|
Объединенная
дисперсия
|
0,025579151
|
|
|
Гипотетическая
разность средних
|
0
|
|
|
Df
|
111
|
|
|
t-статистика
|
31,45118426
|
|
|
P(T<=t)
одностороннее
|
2,06152E-57
|
|
|
t
критическое одностороннее
|
1,658697784
|
|
|
P(T<=t)
двухстороннее
|
4,12304E-57
|
|
|
t
критическое двухстороннее
|
1,981566129
|
|
|
|
Контроль
|
Т-2
|
|
Среднее
|
0,946428571
|
0,672413793
|
|
Дисперсия
|
0,051623377
|
0,224137931
|
|
Наблюдения
|
56
|
58
|
|
Объединенная
дисперсия
|
0,139420962
|
|
|
Гипотетическая
разность средних
|
0
|
|
|
Df
|
112
|
|
|
t-статистика
|
3,917107881
|
|
|
P(T<=t)
одностороннее
|
7,72547E-05
|
|
|
t
критическое одностороннее
|
1,658572728
|
|
|
P(T<=t)
двухстороннее
|
0,000154509
|
|
|
t
критическое двухстороннее
|
1,981370588
|
|
|
|
Контроль
|
Т-4
|
|
Среднее
|
0,946428571
|
0
|
|
Дисперсия
|
0,051623377
|
0
|
|
Наблюдения
|
56
|
51
|
|
Объединенная
дисперсия
|
0,027040816
|
|
|
Гипотетическая
разность средних
|
0
|
|
|
Df
|
105
|
|
|
t-статистика
|
29,73480921
|
|
|
P(T<=t)
одностороннее
|
2,97947E-53
|
|
|
t
критическое одностороннее
|
1,659495865
|
|
|
P(T<=t)
двухстороннее
|
5,95894E-53
|
|
|
t
критическое двухстороннее
|
1,982816684
|
|
|
|
Контроль
|
Т-15
|
|
1
|
2
|
3
|
|
Среднее
|
0,946428571
|
0,5
|
|
Дисперсия
|
0,051623377
|
0,254237288
|
|
Наблюдения
|
56
|
60
|
|
Объединенная
дисперсия
|
0,156484962
|
|
|
Гипотетическая
разность средних
|
0
|
|
|
Df
|
114
|
|
|
t-статистика
|
6,073741731
|
|
|
P(T<=t)
одностороннее
|
8,44031E-09
|
|
|
t
критическое одностороннее
|
1,658329438
|
|
|
P(T<=t)
двухстороннее
|
1,68806E-08
|
|
|
t
критическое двухстороннее
|
1,980993147
|
|
|
|
Контроль
|
Т10
|
|
Среднее
|
0,946428571
|
0
|
|
Дисперсия
|
0,051623377
|
0
|
|
Наблюдения
|
56
|
70
|
|
Объединенная
дисперсия
|
0,022897465
|
|
|
Гипотетическая
разность средних
|
0
|
|
|
Df
|
124
|
|
|
t-статистика
|
34,88605792
|
|
|
P(T<=t)
одностороннее
|
2,91647E-66
|
|
|
t
критическое одностороннее
|
1,657235771
|
|
|
P(T<=t)
двухстороннее
|
5,83295E-66
|
|
|
t
критическое двухстороннее
|
1,97927875
|
|
|
|
Контроль
|
Т9
|
|
Среднее
|
0,946428571
|
0
|
|
Дисперсия
|
0,051623377
|
0
|
|
Наблюдения
|
56
|
68
|
|
Объединенная
дисперсия
|
0,023272834
|
|
|
Гипотетическая
разность средних
|
0
|
|
|
Df
|
122
|
|
|
t-статистика
|
34,37960135
|
|
|
P(T<=t)
одностороннее
|
6,52681E-65
|
|
|
t
критическое одностороннее
|
1,657440407
|
|
|
P(T<=t)
двухстороннее
|
1,30536E-64
|
|
|
t
критическое двухстороннее
|
1,97960162
|
|
|
|
Контроль
|
Т11
|
|
1
|
2
|
3
|
|
Среднее
|
0,946428571
|
0,6
|
|
Дисперсия
|
0,051623377
|
0,244897959
|
|
Наблюдения
|
56
|
50
|
|
Объединенная
дисперсия
|
0,14268544
|
|
|
Гипотетическая
разность средних
|
0
|
|
|
Df
|
104
|
|
|
t-статистика
|
4,713569958
|
|
|
P(T<=t)
одностороннее
|
3,78954E-06
|
|
|
t
критическое одностороннее
|
1,659636837
|
|
|
P(T<=t)
двухстороннее
|
7,57907E-06
|
|
|
t
критическое двухстороннее
|
1,983034963
|
|
|
|
Контроль
|
Д2
|
|
Среднее
|
0,946428571
|
0,5
|
|
Дисперсия
|
0,051623377
|
0,255102041
|
|
Наблюдения
|
56
|
50
|
|
Объединенная
дисперсия
|
0,147493132
|
|
|
Гипотетическая
разность средних
|
0
|
|
|
Df
|
104
|
|
|
t-статистика
|
5,974370694
|
|
|
P(T<=t)
одностороннее
|
1,63326E-08
|
|
|
t
критическое одностороннее
|
1,659636837
|
|
|
P(T<=t)
двухстороннее
|
3,26652E-08
|
|
|
t
критическое двухстороннее
|
1,983034963
|
|
|
|
Контроль
|
Д-26
|
|
Среднее
|
0,946428571
|
0,538461538
|
|
Дисперсия
|
0,051623377
|
0,252403846
|
|
Наблюдения
|
56
|
65
|
|
Объединенная
дисперсия
|
0,15960615
|
|
|
Гипотетическая
разность средних
|
0
|
|
|
Df
|
119
|
|
|
t-статистика
|
5,600905763
|
|
|
P(T<=t)
одностороннее
|
6,97872E-08
|
|
|
t
критическое одностороннее
|
1,65775873
|
|
|
P(T<=t)
двухстороннее
|
1,39574E-07
|
|
|
t
критическое двухстороннее
|
1,980097295
|
|
|
|
Контроль
|
Д-24
|
|
|
1
|
2
|
3
|
|
|
Среднее
|
0,946428571
|
0,071428571
|
|
|
Дисперсия
|
0,051623377
|
0,067287785
|
|
|
Наблюдения
|
56
|
70
|
|
|
Объединенная
дисперсия
|
0,060339862
|
|
|
|
Гипотетическая
разность средних
|
0
|
|
|
|
Df
|
124
|
|
|
|
t-статистика
|
19,86843494
|
|
|
|
P(T<=t)
одностороннее
|
1,19141E-40
|
|
|
|
t
критическое одностороннее
|
1,657235771
|
|
|
|
P(T<=t)
двухстороннее
|
2,38283E-40
|
|
|
|
t
критическое двухстороннее
|
1,97927875
|
|
|
|
|
Контроль
|
Д14
|
|
|
Среднее
|
0,946428571
|
0,514705882
|
|
|
Дисперсия
|
0,051623377
|
0,253511853
|
|
|
Наблюдения
|
56
|
68
|
|
|
Объединенная
дисперсия
|
0,162496556
|
|
|
|
Гипотетическая
разность средних
|
0
|
|
|
|
df
|
122
|
|
|
|
t-статистика
|
5,93499586
|
|
|
|
P(T<=t)
одностороннее
|
1,41435E-08
|
|
|
|
t
критическое одностороннее
|
1,657440407
|
|
|
|
P(T<=t)
двухстороннее
|
2,8287E-08
|
|
|
|
t
критическое двухстороннее
|
1,97960162
|
|
|
|
|
Контроль
|
Д15
|
|
|
Среднее
|
0,946428571
|
0,7
|
|
|
Дисперсия
|
0,051623377
|
0,214285714
|
|
|
Наблюдения
|
50
|
|
|
Объединенная
дисперсия
|
0,128262363
|
|
|
|
Гипотетическая
разность средних
|
0
|
|
|
|
df
|
104
|
|
|
|
t-статистика
|
3,53645002
|
|
|
|
P(T<=t)
одностороннее
|
0,000303609
|
|
|
|
t
критическое одностороннее
|
1,659636837
|
|
|
|
P(T<=t)
двухстороннее
|
0,000607218
|
|
|
|
t
критическое двухстороннее
|
1,983034963
|
|
|
|
|
Контроль
|
Д19
|
|
|
1
|
2
|
3
|
|
|
Среднее
|
0,946428571
|
0,06
|
|
|
Дисперсия
|
0,051623377
|
0,05755102
|
|
|
Наблюдения
|
56
|
50
|
|
|
Объединенная
дисперсия
|
0,054416209
|
|
|
|
Гипотетическая
разность средних
|
0
|
|
|
|
df
|
104
|
|
|
|
t-статистика
|
19,53015492
|
|
|
|
P(T<=t)
одностороннее
|
7,07762E-37
|
|
|
|
t
критическое одностороннее
|
1,659636837
|
|
|
|
P(T<=t)
двухстороннее
|
1,41552E-36
|
|
|
|
t
критическое двухстороннее
|
1,983034963
|
|
|
|
|
Контроль
|
Д21
|
|
|
Среднее
|
0,946428571
|
0,743589744
|
|
|
Дисперсия
|
0,051623377
|
0,193140193
|
|
|
Наблюдения
|
56
|
78
|
|
|
Объединенная
дисперсия
|
0,134174853
|
|
|
|
Гипотетическая
разность средних
|
0
|
|
|
|
Df
|
132
|
|
|
|
t-статистика
|
3,161581953
|
|
|
|
P(T<=t)
одностороннее
|
0,000973405
|
|
|
|
t
критическое одностороннее
|
1,656478616
|
|
|
|
P(T<=t)
двухстороннее
|
0,00194681
|
|
|
|
t
критическое двухстороннее
|
1,978096407
|
|
|
|
|
Контроль
|
Д20
|
|
|
Среднее
|
0,946428571
|
0,119402985
|
|
|
Дисперсия
|
0,051623377
|
0,106739032
|
|
|
Наблюдения
|
56
|
67
|
|
|
Объединенная
дисперсия
|
0,081686461
|
|
|
|
Гипотетическая
разность средних
|
0
|
|
|
|
Df
|
121
|
|
|
|
t-статистика
|
15,98169225
|
|
|
|
P(T<=t)
одностороннее
|
6,63552E-32
|
|
|
|
t
критическое одностороннее
|
1,657544999
|
|
|
|
P(T<=t)
двухстороннее
|
1,3271E-31
|
|
|
|
t
критическое двухстороннее
|
1,979765329
|
|
|
|
|
Контроль
|
Д17
|
|
1
|
2
|
3
|
|
Среднее
|
0,946428571
|
0,107142857
|
|
Дисперсия
|
0,051623377
|
0,097402597
|
|
Наблюдения
|
56
|
56
|
|
Объединенная
дисперсия
|
0,074512987
|
|
|
Гипотетическая
разность средних
|
0
|
|
|
Df
|
110
|
|
|
t-статистика
|
16,26944956
|
|
|
P(T<=t)
одностороннее
|
2,38457E-31
|
|
|
t
критическое одностороннее
|
1,658822839
|
|
|
P(T<=t)
двухстороннее
|
4,76914E-31
|
|
|
t
критическое двухстороннее
|
1,981766218
|
|
|
|
Контроль
|
Д16
|
|
Среднее
|
0,946428571
|
0,5
|
|
Дисперсия
|
0,051623377
|
0,255102041
|
|
Наблюдения
|
56
|
50
|
|
Объединенная
дисперсия
|
0,147493132
|
|
|
Гипотетическая
разность средних
|
0
|
|
|
Df
|
104
|
|
|
t-статистика
|
5,974370694
|
|
|
P(T<=t)
одностороннее
|
1,63326E-08
|
|
|
t
критическое одностороннее
|
1,659636837
|
|
|
P(T<=t)
двухстороннее
|
3,26652E-08
|
|
|
t
критическое двухстороннее
|
1,983034963
|
|
|
|
Контроль
|
Д23
|
|
Среднее
|
0,946428571
|
0,096774194
|
|
Дисперсия
|
0,051623377
|
0,088841883
|
|
Наблюдения
|
56
|
62
|
|
Объединенная
дисперсия
|
0,071195177
|
|
|
Гипотетическая
разность средних
|
0
|
|
|
Df
|
116
|
|
|
t-статистика
|
17,27292417
|
|
|
P(T<=t)
одностороннее
|
3,70395E-34
|
|
|
t
критическое одностороннее
|
1,658095243
|
|
|
P(T<=t)
двухстороннее
|
7,4079E-34
|
|
|
t
критическое двухстороннее
|
1,980624802
|
|
|
|
Контроль
|
Д12
|
|
1
|
2
|
3
|
|
Среднее
|
0,946428571
|
0,529411765
|
|
Дисперсия
|
0,051623377
|
0,254117647
|
|
Наблюдения
|
56
|
51
|
|
Объединенная
дисперсия
|
0,14804922
|
|
|
Гипотетическая
разность средних
|
0
|
|
|
Df
|
105
|
|
|
t-статистика
|
5,599351223
|
|
|
P(T<=t)
одностороннее
|
8,67722E-08
|
|
|
t
критическое одностороннее
|
1,659495865
|
|
|
P(T<=t)
двухстороннее
|
1,73544E-07
|
|
|
t
критическое двухстороннее
|
1,982816684
|
|
|
|
Контроль
|
Д16
|
|
Среднее
|
0,946428571
|
0,5
|
|
Дисперсия
|
0,051623377
|
0,255102041
|
|
Наблюдения
|
56
|
50
|
|
Объединенная
дисперсия
|
0,147493132
|
|
|
Гипотетическая
разность средних
|
0
|
|
|
Df
|
104
|
|
|
t-статистика
|
5,974370694
|
|
|
P(T<=t)
одностороннее
|
1,63326E-08
|
|
|
t
критическое одностороннее
|
1,659636837
|
|
|
P(T<=t)
двухстороннее
|
3,26652E-08
|
|
|
t
критическое двухстороннее
|
1,983034963
|
|
|
|
Контроль
|
В-1
|
|
Среднее
|
0,946428571
|
0,8
|
|
Дисперсия
|
0,051623377
|
0,163265306
|
|
Наблюдения
|
56
|
50
|
|
Объединенная
дисперсия
|
0,104223901
|
|
|
Гипотетическая
разность средних
|
0
|
|
|
df
|
104
|
|
|
t-статистика
|
2,331139407
|
|
|
P(T<=t)
одностороннее
|
0,01083742
|
|
|
t
критическое одностороннее
|
1,659636837
|
|
|
P(T<=t)
двухстороннее
|
0,021674841
|
|
|
t
критическое двухстороннее
|
1,983034963
|
|
|
|
Контроль
|
В8
|
|
|
1
|
2
|
3
|
|
|
Среднее
|
0,946428571
|
0,083333333
|
|
|
Дисперсия
|
0,051623377
|
0,077464789
|
|
|
Наблюдения
|
56
|
72
|
|
|
Объединенная
дисперсия
|
0,066184807
|
|
|
|
Гипотетическая
разность средних
|
0
|
|
|
|
df
|
126
|
|
|
|
t-статистика
|
18,82932897
|
|
|
|
P(T<=t)
одностороннее
|
9,74705E-39
|
|
|
|
t
критическое одностороннее
|
1,657035682
|
|
|
|
P(T<=t)
двухстороннее
|
1,94941E-38
|
|
|
|
t
критическое двухстороннее
|
1,978969522
|
|
|
|
|
Контроль
|
В2
|
|
|
Среднее
|
0,946428571
|
0,25
|
|
|
Дисперсия
|
0,051623377
|
0,190677966
|
|
|
Наблюдения
|
56
|
60
|
|
|
Объединенная
дисперсия
|
0,123590226
|
|
|
|
Гипотетическая
разность средних
|
0
|
|
|
|
Df
|
114
|
|
|
|
t-статистика
|
10,66166817
|
|
|
|
P(T<=t)
одностороннее
|
3,94162E-19
|
|
|
|
t
критическое одностороннее
|
1,658329438
|
|
|
|
P(T<=t)
двухстороннее
|
7,88323E-19
|
|
|
|
t
критическое двухстороннее
|
1,980993147
|
|
|
|
|
Контроль
|
В11
|
|
|
Среднее
|
0,946428571
|
0,114754098
|
|
|
Дисперсия
|
0,051623377
|
0,103278689
|
|
|
Наблюдения
|
56
|
61
|
|
|
Объединенная
дисперсия
|
|
|
|
Гипотетическая
разность средних
|
0
|
|
|
|
Df
|
115
|
|
|
|
t-статистика
|
16,03171605
|
|
|
|
P(T<=t)
одностороннее
|
2,14344E-31
|
|
|
|
t
критическое одностороннее
|
1,658211204
|
|
|
|
P(T<=t)
двухстороннее
|
4,28687E-31
|
|
|
|
t
критическое двухстороннее
|
1,980806701
|
|
|
|
|
Контроль
|
В4
|
|
|
1
|
2
|
3
|
|
|
Среднее
|
0,946428571
|
0,339622642
|
|
|
Дисперсия
|
0,051623377
|
0,228592163
|
|
|
Наблюдения
|
56
|
53
|
|
|
Объединенная
дисперсия
|
0,137626899
|
|
|
|
Гипотетическая
разность средних
|
0
|
|
|
|
Df
|
107
|
|
|
|
t-статистика
|
8,535261938
|
|
|
|
P(T<=t)
одностороннее
|
5,12868E-14
|
|
|
|
t
критическое одностороннее
|
1,659218469
|
|
|
|
P(T<=t)
двухстороннее
|
1,02574E-13
|
|
|
|
t
критическое двухстороннее
|
1,982384674
|
|
|
|
|
Контроль
|
В5
|
|
|
Среднее
|
0,946428571
|
0,64
|
|
|
Дисперсия
|
0,051623377
|
0,235102041
|
|
|
Наблюдения
|
56
|
50
|
|
|
Объединенная
дисперсия
|
0,138070055
|
|
|
|
Гипотетическая
разность средних
|
0
|
|
|
|
df
|
104
|
|
|
|
t-статистика
|
4,238435619
|
|
|
|
P(T<=t)
одностороннее
|
2,44187E-05
|
|
|
|
t
критическое одностороннее
|
1,659636837
|
|
|
|
P(T<=t)
двухстороннее
|
4,88375E-05
|
|
|
|
|
Контроль
|
В10
|
|
|
Среднее
|
0,946428571
|
0,194805195
|
|
|
Дисперсия
|
0,051623377
|
0,158920027
|
|
|
Наблюдения
|
56
|
77
|
|
|
Объединенная
дисперсия
|
0,113871815
|
|
|
|
Гипотетическая
разность средних
|
0
|
|
|
|
df
|
131
|
|
|
|
t-статистика
|
12,68252458
|
|
|
|
P(T<=t)
одностороннее
|
7,61823E-25
|
|
|
|
t
критическое одностороннее
|
1,656567292
|
|
|
|
P(T<=t)
двухстороннее
|
1,52365E-24
|
|
|
|
t
критическое двухстороннее
|
1,978237378
|
|
|
|
|
Контроль
|
В7
|
|
|
1
|
2
|
3
|
|
|
Среднее
|
0,946428571
|
0,2
|
|
|
Дисперсия
|
0,051623377
|
0,163265306
|
|
|
Наблюдения
|
56
|
50
|
|
|
Объединенная
дисперсия
|
0,104223901
|
|
|
|
Гипотетическая
разность средних
|
0
|
|
|
|
Df
|
104
|
|
|
|
t-статистика
|
11,88312527
|
|
|
|
P(T<=t)
одностороннее
|
2,17816E-21
|
|
|
|
t
критическое одностороннее
|
1,659636837
|
|
|
|
P(T<=t)
двухстороннее
|
4,35632E-21
|
|
|
|
t
критическое двухстороннее
|
1,983034963
|
|
|
|
|
Контроль
|
В6
|
|
|
Среднее
|
0,946428571
|
0,545454545
|
|
|
Дисперсия
|
0,051623377
|
0,252525253
|
|
|
Наблюдения
|
56
|
55
|
|
|
Объединенная
дисперсия
|
0,151152746
|
|
|
|
Гипотетическая
разность средних
|
0
|
|
|
|
Df
|
109
|
|
|
|
t-статистика
|
5,432779626
|
|
|
|
P(T<=t)
одностороннее
|
1,70472E-07
|
|
|
|
t
критическое одностороннее
|
1,658954716
|
|
|
|
P(T<=t)
двухстороннее
|
3,40944E-07
|
|
|
|
t
критическое двухстороннее
|
1,981966307
|
|
|
|
|
Контроль
|
В9
|
|
|
Среднее
|
0,946428571
|
0,169230769
|
|
|
Дисперсия
|
0,051623377
|
0,142788462
|
|
|
Наблюдения
|
56
|
65
|
|
|
Объединенная
дисперсия
|
0,100653338
|
|
|
|
Гипотетическая
разность средних
|
0
|
|
|
|
Df
|
119
|
|
|
|
t-статистика
|
13,43616965
|
|
|
|
P(T<=t)
одностороннее
|
6,55575E-26
|
|
|
|
t
критическое одностороннее
|
1,65775873
|
|
|
|
P(T<=t)
двухстороннее
|
1,31115E-25
|
|
|
|
t
критическое двухстороннее
|
1,980097295
|
|
|
|
|
Контроль
|
В12
|
|
|
1
|
2
|
3
|
|
|
Среднее
|
0,946428571
|
0,636363636
|
|
|
Дисперсия
|
0,051623377
|
0,235690236
|
|
|
Наблюдения
|
56
|
55
|
|
|
Объединенная
дисперсия
|
0,142812463
|
|
|
|
Гипотетическая
разность средних
|
0
|
|
|
|
Df
|
109
|
|
|
|
t-статистика
|
4,321987134
|
|
|
|
P(T<=t)
одностороннее
|
1,71499E-05
|
|
|
|
t
критическое одностороннее
|
1,658954716
|
|
|
|
P(T<=t)
двухстороннее
|
3,42998E-05
|
|
|
|
t
критическое двухстороннее
|
1,981966307
|
|
|
|
|
Контроль
|
Ц-3
|
|
|
Среднее
|
0,946428571
|
0,816666667
|
|
|
Дисперсия
|
0,051623377
|
0,152259887
|
|
|
Наблюдения
|
56
|
60
|
|
|
Объединенная
дисперсия
|
0,103707185
|
|
|
|
Гипотетическая
разность средних
|
0
|
|
|
|
df
|
114
|
|
|
|
t-статистика
|
2,168619875
|
|
|
|
P(T<=t)
одностороннее
|
0,016094579
|
|
|
|
t
критическое одностороннее
|
1,658329438
|
|
|
|
P(T<=t)
двухстороннее
|
0,032189158
|
|
|
|
t
критическое двухстороннее
|
1,980993147
|
|
|
|
|
Контроль
|
Ц6
|
|
|
Среднее
|
0,946428571
|
0,051724138
|
|
|
Дисперсия
|
0,051623377
|
0,049909256
|
|
|
Наблюдения
|
56
|
58
|
|
|
Объединенная
дисперсия
|
0,050751012
|
|
|
|
Гипотетическая
разность средних
|
0
|
|
|
|
Df
|
112
|
|
|
|
t-статистика
|
21,1988754
|
|
|
|
P(T<=t)
одностороннее
|
2,63024E-41
|
|
|
|
t
критическое одностороннее
|
1,658572728
|
|
|
|
P(T<=t)
двухстороннее
|
5,26047E-41
|
|
|
|
t
критическое двухстороннее
|
1,981370588
|
|
|
|
|
Контроль
|
Ц5
|
|
|
1
|
2
|
3
|
|
|
Среднее
|
0,946428571
|
0,036363636
|
|
|
Дисперсия
|
0,051623377
|
0,035690236
|
|
|
Наблюдения
|
56
|
55
|
|
|
Объединенная
дисперсия
|
0,043729894
|
|
|
|
Гипотетическая
разность средних
|
0
|
|
|
|
Df
|
109
|
|
|
|
t-статистика
|
22,9243504
|
|
|
|
P(T<=t)
одностороннее
|
8,46403E-44
|
|
|
|
t
критическое одностороннее
|
1,658954716
|
|
|
|
P(T<=t)
двухстороннее
|
1,69281E-43
|
|
|
|
t
критическое двухстороннее
|
1,981966307
|
|
|
|
|
Контроль
|
Ц4
|
|
|
Среднее
|
0,946428571
|
0,6
|
|
|
Дисперсия
|
0,051623377
|
0,244897959
|
|
|
Наблюдения
|
56
|
50
|
|
|
Объединенная
дисперсия
|
0,14268544
|
|
|
|
Гипотетическая
разность средних
|
0
|
|
|
|
Df
|
104
|
|
|
|
t-статистика
|
4,713569958
|
|
|
|
P(T<=t)
одностороннее
|
3,78954E-06
|
|
|
|
t
критическое одностороннее
|
1,659636837
|
|
|
|
P(T<=t)
двухстороннее
|
7,57907E-06
|
|
|
|
t
критическое двухстороннее
|
1,983034963
|
|
|
|
|
Контроль
|
Ц1
|
|
|
Среднее
|
0,946428571
|
0,5
|
|
|
Дисперсия
|
0,051623377
|
0,255102041
|
|
|
Наблюдения
|
56
|
50
|
|
|
Объединенная
дисперсия
|
0,147493132
|
|
|
|
Гипотетическая
разность средних
|
0
|
|
|
|
df
|
104
|
5,974370694
|
|
|
|
P(T<=t)
одностороннее
|
1,63326E-08
|
|
|
|
t
критическое одностороннее
|
1,659636837
|
|
|
|
P(T<=t)
двухстороннее
|
3,26652E-08
|
|
|
|
t
критическое двухстороннее
|
1,983034963
|
|
|
|
|
Контроль
|
Ц8
|
|
|
1
|
2
|
3
|
|
|
Среднее
|
0,946428571
|
0,230769231
|
|
|
Дисперсия
|
0,051623377
|
0,180995475
|
|
|
Наблюдения
|
56
|
52
|
|
|
Объединенная
дисперсия
|
0,113868443
|
|
|
|
t-статистика
|
11,01256439
|
|
|
|
P(T<=t)
одностороннее
|
1,45877E-19
|
|
|
|
t
критическое одностороннее
|
1,659354893
|
|
|
|
P(T<=t)
двухстороннее
|
2,91754E-19
|
|
|
|
t
критическое двухстороннее
|
1,982598405
|
|
|
|
|
|
|
|
|
|
|
|
|
|
|
Таблица Г.4 - Двухвыборочный t-тест с
одинаковыми дисперсиями различия между изолятами по антагонистической
активности в отношении гриба р. Fusarium
(Y7ес)
|
|
Контроль
|
Т-7
|
|
1
|
2
|
3
|
|
Среднее
|
0,866666667
|
0,521126761
|
|
Дисперсия
|
0,117514124
|
0,253118712
|
|
Наблюдения
|
60
|
71
|
|
Объединенная
дисперсия
|
0,191098009
|
|
|
Гипотетическая
разность средних
|
0
|
|
|
t-статистика
|
4,507536802
|
|
|
P(T<=t)
одностороннее
|
7,27322E-06
|
|
|
t
критическое одностороннее
|
1,656751465
|
|
|
P(T<=t)
двухстороннее
|
1,45464E-05
|
|
|
t
критическое двухстороннее
|
1,978523869
|
|
|
|
Контроль
|
Т-8
|
|
Среднее
|
0,866666667
|
0,338235294
|
|
Дисперсия
|
0,117514124
|
0,227172959
|
|
Наблюдения
|
60
|
68
|
|
Объединенная
дисперсия
|
0,175824774
|
|
|
Гипотетическая
разность средних
|
0
|
|
|
t-статистика
|
7,114979544
|
|
|
P(T<=t)
одностороннее
|
3,73693E-11
|
|
|
t
критическое одностороннее
|
1,657035682
|
|
|
P(T<=t)
двухстороннее
|
7,47387E-11
|
|
|
t
критическое двухстороннее
|
1,978969522
|
|
|
|
Контроль
|
Т-6
|
|
1
|
2
|
3
|
|
Среднее
|
0,866666667
|
0,171052632
|
|
Дисперсия
|
0,117514124
|
0,143684211
|
|
Наблюдения
|
60
|
76
|
|
Гипотетическая
разность средних
|
0
|
|
|
Df
|
134
|
|
|
t-статистика
|
11,07971844
|
|
|
P(T<=t)
одностороннее
|
5,90246E-21
|
|
|
t
критическое одностороннее
|
1,656303539
|
|
|
P(T<=t)
двухстороннее
|
1,18049E-20
|
|
|
t
критическое двухстороннее
|
1,977823558
|
|
|
|
Контроль
|
Т-3
|
|
Среднее
|
0,866666667
|
0,050847458
|
|
Дисперсия
|
0,117514124
|
0,049094097
|
|
Наблюдения
|
60
|
59
|
|
Объединенная
дисперсия
|
0,083596504
|
|
|
Гипотетическая
разность средних
|
0
|
|
|
Df
|
117
|
|
|
t-статистика
|
15,38962436
|
|
|
P(T<=t)
одностороннее
|
3,42696E-30
|
|
|
t
критическое одностороннее
|
1,657981556
|
|
|
P(T<=t)
двухстороннее
|
6,85392E-30
|
|
|
t
критическое двухстороннее
|
1,98044745
|
|
|
|
Контроль
|
Т-1
|
|
Среднее
|
0,866666667
|
0,055555556
|
|
Дисперсия
|
0,117514124
|
0,053459119
|
|
Наблюдения
|
60
|
54
|
|
Объединенная
дисперсия
|
0,087202381
|
|
|
Гипотетическая
разность средних
|
0
|
|
|
Df
|
112
|
|
|
t-статистика
|
14,64320892
|
|
|
P(T<=t)
одностороннее
|
4,45721E-28
|
|
|
t
критическое одностороннее
|
1,658572728
|
|
|
P(T<=t)
двухстороннее
|
8,91442E-28
|
|
|
t
критическое двухстороннее
|
1,981370588
|
|
|
|
Контроль
|
Т-2
|
|
1
|
2
|
3
|
|
Среднее
|
0,866666667
|
0,5
|
|
Дисперсия
|
0,117514124
|
0,254237288
|
|
Наблюдения
|
60
|
60
|
|
Объединенная
дисперсия
|
0,185875706
|
|
|
Гипотетическая
разность средних
|
0
|
|
|
Df
|
118
|
|
|
t-статистика
|
4,658228005
|
|
|
P(T<=t)
одностороннее
|
4,21874E-06
|
|
|
t
критическое одностороннее
|
1,657870143
|
|
|
P(T<=t)
двухстороннее
|
8,43747E-06
|
|
|
t
критическое двухстороннее
|
1,980270099
|
|
|
|
Контроль
|
Т-4
|
|
Среднее
|
0,866666667
|
0,277777778
|
|
Дисперсия
|
0,117514124
|
0,204402516
|
|
Наблюдения
|
60
|
54
|
|
Объединенная
дисперсия
|
0,158630952
|
|
|
Гипотетическая
разность средних
|
0
|
|
|
Df
|
112
|
|
|
t-статистика
|
7,882418222
|
|
|
P(T<=t)
одностороннее
|
1,14664E-12
|
|
|
t
критическое одностороннее
|
1,658572728
|
|
|
P(T<=t)
двухстороннее
|
2,29329E-12
|
|
|
t
критическое двухстороннее
|
1,981370588
|
|
|
|
Контроль
|
Т-15
|
|
Среднее
|
0,866666667
|
0,06779661
|
|
Дисперсия
|
0,117514124
|
0,064289889
|
|
Наблюдения
|
60
|
59
|
|
Объединенная
дисперсия
|
0,091129461
|
|
|
Гипотетическая
разность средних
|
0
|
|
|
Df
|
117
|
|
|
t-статистика
|
14,43360758
|
|
|
P(T<=t)
одностороннее
|
4,77131E-28
|
|
|
t
критическое одностороннее
|
1,657981556
|
|
|
P(T<=t)
двухстороннее
|
9,54262E-28
|
|
|
t
критическое двухстороннее
|
1,98044745
|
|
|
|
Контроль
|
Т9
|
|
1
|
2
|
3
|
|
Среднее
|
0,866666667
|
0
|
|
Дисперсия
|
0,117514124
|
0
|
|
Наблюдения
|
60
|
79
|
|
Объединенная
дисперсия
|
0,050608273
|
|
|
Гипотетическая
разность средних
|
0
|
|
|
df
|
137
|
|
|
t-статистика
|
22,49692225
|
|
|
P(T<=t)
одностороннее
|
3,80789E-48
|
|
|
t
критическое одностороннее
|
1,656053428
|
|
|
P(T<=t)
двухстороннее
|
7,61577E-48
|
|
|
t
критическое двухстороннее
|
1,977432476
|
|
|
|
Контроль
|
Т11
|
|
Среднее
|
0,866666667
|
0,703703704
|
|
Дисперсия
|
0,117514124
|
0,212438854
|
|
Наблюдения
|
60
|
54
|
|
Объединенная
дисперсия
|
0,162433862
|
|
|
Гипотетическая
разность средних
|
0
|
|
|
df
|
112
|
|
|
t-статистика
|
2,155612563
|
|
|
P(T<=t)
одностороннее
|
0,016627044
|
|
|
t
критическое одностороннее
|
1,658572728
|
|
|
P(T<=t)
двухстороннее
|
0,033254088
|
|
|
t
критическое двухстороннее
|
1,981370588
|
|
|
|
Контроль
|
Т12
|
|
Среднее
|
0,866666667
|
0,626865672
|
|
Дисперсия
|
0,117514124
|
0,237449118
|
|
Наблюдения
|
60
|
67
|
|
Объединенная
дисперсия
|
0,180839801
|
|
|
Гипотетическая
разность средних
|
0
|
|
|
Df
|
125
|
|
|
t-статистика
|
3,172598661
|
|
|
P(T<=t)
одностороннее
|
0,000950756
|
|
|
t
критическое одностороннее
|
1,657135726
|
|
|
P(T<=t)
двухстороннее
|
0,001901512
|
|
|
t
критическое двухстороннее
|
|
|
|
Контроль
|
Д1
|
|
1
|
2
|
3
|
|
Среднее
|
0,866666667
|
0,293333333
|
|
Дисперсия
|
0,117514124
|
0,21009009
|
|
Наблюдения
|
60
|
75
|
|
Объединенная
дисперсия
|
0,169022556
|
|
|
Гипотетическая
разность средних
|
0
|
|
|
df
|
133
|
|
|
t-статистика
|
8,051452439
|
|
|
P(T<=t)
одностороннее
|
2,02942E-13
|
|
|
t
критическое одностороннее
|
1,656389941
|
|
|
P(T<=t)
двухстороннее
|
4,05884E-13
|
|
|
t
критическое двухстороннее
|
1,977959982
|
|
|
|
Контроль
|
Д2
|
|
Среднее
|
0,866666667
|
0,672413793
|
|
Дисперсия
|
0,117514124
|
0,224137931
|
|
Наблюдения
|
60
|
58
|
|
Объединенная
дисперсия
|
0,169906857
|
|
|
Гипотетическая
разность средних
|
0
|
|
|
df
|
116
|
|
|
t-статистика
|
2,559237657
|
|
|
P(T<=t)
одностороннее
|
0,005888318
|
|
|
t
критическое одностороннее
|
1,658095243
|
|
|
P(T<=t)
двухстороннее
|
0,011776636
|
|
|
t
критическое двухстороннее
|
1,980624802
|
|
|
|
Контроль
|
Д-24
|
|
Среднее
|
0,866666667
|
0,660377358
|
|
Дисперсия
|
0,117514124
|
0,228592163
|
|
Наблюдения
|
60
|
53
|
|
Объединенная
дисперсия
|
0,169550683
|
|
|
Гипотетическая
разность средних
|
0
|
|
|
Df
|
111
|
|
|
t-статистика
|
2,65767142
|
|
|
P(T<=t)
одностороннее
|
0,004514768
|
|
|
t
критическое одностороннее
|
1,658697784
|
|
|
P(T<=t)
двухстороннее
|
0,009029536
|
|
|
t
критическое двухстороннее
|
1,981566129
|
|
|
|
Контроль
|
Д14
|
|
1
|
2
|
3
|
|
Среднее
|
0,866666667
|
0,363636364
|
|
Дисперсия
|
0,117514124
|
0,235690236
|
|
Наблюдения
|
60
|
55
|
|
Объединенная
дисперсия
|
0,173987664
|
|
|
Гипотетическая
разность средних
|
0
|
|
|
Df
|
113
|
|
|
t-статистика
|
6,460155457
|
|
|
P(T<=t)
одностороннее
|
1,36668E-09
|
|
|
t
критическое одностороннее
|
1,658449946
|
|
|
P(T<=t)
двухстороннее
|
2,73335E-09
|
|
|
t
критическое двухстороннее
|
1,981179594
|
|
|
|
Контроль
|
Д15
|
|
Среднее
|
0,866666667
|
0,5
|
|
Дисперсия
|
0,117514124
|
0,253521127
|
|
Наблюдения
|
60
|
72
|
|
Объединенная
дисперсия
|
0,191794872
|
|
|
Гипотетическая
разность средних
|
0
|
|
|
Df
|
130
|
|
|
t-статистика
|
4,78969482
|
|
|
P(T<=t)
одностороннее
|
2,24023E-06
|
|
|
t
критическое одностороннее
|
1,656658242
|
|
|
P(T<=t)
двухстороннее
|
4,48047E-06
|
|
|
t
критическое двухстороннее
|
1,97837835
|
|
|
|
Контроль
|
Д15
|
|
Среднее
|
0,866666667
|
0,5
|
|
Дисперсия
|
0,117514124
|
0,253521127
|
|
Наблюдения
|
60
|
72
|
|
Объединенная
дисперсия
|
0,191794872
|
|
|
Гипотетическая
разность средних
|
0
|
|
|
Df
|
130
|
|
|
t-статистика
|
4,78969482
|
|
|
P(T<=t)
одностороннее
|
2,24023E-06
|
|
|
t
критическое одностороннее
|
1,656658242
|
|
|
P(T<=t)
двухстороннее
|
4,48047E-06
|
|
|
t
критическое двухстороннее
|
1,97837835
|
|
|
|
Контроль
|
Д18
|
|
1
|
2
|
3
|
|
Среднее
|
0,866666667
|
0,444444444
|
|
Дисперсия
|
0,117514124
|
0,251572327
|
|
Наблюдения
|
60
|
54
|
|
Объединенная
дисперсия
|
0,180952381
|
|
|
Гипотетическая
разность средних
|
0
|
|
|
df
|
112
|
|
|
t-статистика
|
5,291502622
|
|
|
P(T<=t)
одностороннее
|
3,04613E-07
|
|
|
t
критическое одностороннее
|
1,658572728
|
|
|
P(T<=t)
двухстороннее
|
6,09226E-07
|
|
|
t
критическое двухстороннее
|
1,981370588
|
|
|
|
Контроль
|
Д21
|
|
Среднее
|
0,866666667
|
0,64
|
|
Дисперсия
|
0,117514124
|
0,235102041
|
|
Наблюдения
|
60
|
50
|
|
Объединенная
дисперсия
|
0,170864198
|
|
|
Гипотетическая
разность средних
|
0
|
|
|
df
|
108
|
|
|
t-статистика
|
2,863692665
|
|
|
P(T<=t)
одностороннее
|
0,002515846
|
|
|
t
критическое одностороннее
|
1,659086593
|
|
|
P(T<=t)
двухстороннее
|
0,005031692
|
|
|
t
критическое двухстороннее
|
1,982170943
|
|
|
|
Контроль
|
Д17
|
|
Среднее
|
0,866666667
|
0,480769231
|
|
Дисперсия
|
0,117514124
|
0,254524887
|
|
Наблюдения
|
60
|
52
|
|
Объединенная
дисперсия
|
0,181037296
|
|
|
Гипотетическая
разность средних
|
0
|
|
|
Df
|
110
|
|
|
t-статистика
|
4,7869198
|
|
|
P(T<=t)
одностороннее
|
2,65511E-06
|
|
|
t
критическое одностороннее
|
1,658822839
|
|
|
P(T<=t)
двухстороннее
|
5,31023E-06
|
|
|
t
критическое двухстороннее
|
1,981766218
|
|
|
|
Контроль
|
Д16
|
|
1
|
2
|
3
|
|
Среднее
|
0,866666667
|
0,4375
|
|
Дисперсия
|
0,117514124
|
0,249208861
|
|
Наблюдения
|
60
|
80
|
|
Объединенная
дисперсия
|
0,192904589
|
|
|
Гипотетическая
разность средних
|
0
|
|
|
df
|
138
|
|
|
t-статистика
|
5,721518464
|
|
|
P(T<=t)
одностороннее
|
3,14683E-08
|
|
|
t
критическое одностороннее
|
1,655971573
|
|
|
P(T<=t)
двухстороннее
|
6,29366E-08
|
|
|
t
критическое двухстороннее
|
1,977305146
|
|
|
|
Контроль
|
Д23
|
|
Среднее
|
0,866666667
|
0,6
|
|
Дисперсия
|
0,117514124
|
0,244897959
|
|
Наблюдения
|
60
|
50
|
|
Объединенная
дисперсия
|
0,175308642
|
|
|
Гипотетическая
разность средних
|
0
|
|
|
df
|
108
|
|
|
t-статистика
|
3,326069764
|
|
|
P(T<=t)
одностороннее
|
0,000602116
|
|
|
t
критическое одностороннее
|
1,659086593
|
|
|
P(T<=t)
двухстороннее
|
0,001204232
|
|
|
t
критическое двухстороннее
|
1,982170943
|
|
|
|
Контроль
|
Д16
|
|
Среднее
|
0,866666667
|
0,528301887
|
|
Дисперсия
|
0,117514124
|
0,253991292
|
|
Наблюдения
|
60
|
53
|
|
Объединенная
дисперсия
|
0,181449374
|
|
|
Гипотетическая
разность средних
|
0
|
|
|
Df
|
111
|
|
|
t-статистика
|
4,213876009
|
|
|
P(T<=t)
одностороннее
|
2,56601E-05
|
|
|
t
критическое одностороннее
|
1,658697784
|
|
|
P(T<=t)
двухстороннее
|
5,13202E-05
|
|
|
t
критическое двухстороннее
|
1,981566129
|
|
|
|
Контроль
|
|
1
|
2
|
3
|
|
Среднее
|
0,866666667
|
0,366666667
|
|
Дисперсия
|
0,117514124
|
0,236158192
|
|
Наблюдения
|
60
|
60
|
|
Объединенная
дисперсия
|
0,176836158
|
|
|
Гипотетическая
разность средних
|
0
|
|
|
Df
|
118
|
|
|
t-статистика
|
6,512460409
|
|
|
P(T<=t)
одностороннее
|
9,44957E-10
|
|
|
t
критическое одностороннее
|
1,657870143
|
|
|
P(T<=t)
двухстороннее
|
1,88991E-09
|
|
|
t
критическое двухстороннее
|
1,980270099
|
|
|
|
Контроль
|
В8
|
|
Среднее
|
0,866666667
|
0,213483146
|
|
Дисперсия
|
0,117514124
|
0,169816139
|
|
Наблюдения
|
60
|
89
|
|
Объединенная
дисперсия
|
0,148824174
|
|
|
Гипотетическая
разность средних
|
0
|
|
|
df
|
147
|
|
|
t-статистика
|
10,13621872
|
|
|
P(T<=t)
одностороннее
|
6,12888E-19
|
|
|
t
критическое одностороннее
|
1,655284905
|
|
|
P(T<=t)
двухстороннее
|
1,22578E-18
|
|
|
t
критическое двухстороннее
|
1,976231943
|
|
|
|
Контроль
|
В3
|
|
Среднее
|
0,866666667
|
0,652173913
|
|
Дисперсия
|
0,117514124
|
0,230179028
|
|
Наблюдения
|
60
|
69
|
|
Объединенная
дисперсия
|
0,17783864
|
|
|
Гипотетическая
разность средних
|
0
|
|
|
df
|
127
|
|
|
t-статистика
|
2,881408786
|
|
|
P(T<=t)
одностороннее
|
0,002324735
|
|
|
t
критическое одностороннее
|
1,656940185
|
|
|
P(T<=t)
двухстороннее
|
0,00464947
|
|
|
t
критическое двухстороннее
|
1,978819455
|
|
|
|
Контроль
|
В2
|
|
1
|
2
|
3
|
|
Среднее
|
0,866666667
|
0,309090909
|
|
Дисперсия
|
0,117514124
|
0,217508418
|
|
Наблюдения
|
60
|
55
|
|
Объединенная
дисперсия
|
0,165299008
|
|
|
Гипотетическая
разность средних
|
0
|
|
|
Df
|
113
|
|
|
t-статистика
|
7,346437862
|
|
|
P(T<=t)
одностороннее
|
1,7018E-11
|
|
|
t
критическое одностороннее
|
1,658449946
|
|
|
P(T<=t)
двухстороннее
|
3,4036E-11
|
|
|
t
критическое двухстороннее
|
1,981179594
|
|
|
|
Контроль
|
В11
|
|
Среднее
|
0,866666667
|
0,362068966
|
|
Дисперсия
|
0,117514124
|
0,235027223
|
|
Наблюдения
|
60
|
58
|
|
Объединенная
дисперсия
|
0,17525763
|
|
|
Гипотетическая
разность средних
|
0
|
|
|
Df
|
116
|
|
|
t-статистика
|
6,54568978
|
|
|
P(T<=t)
одностороннее
|
8,40913E-10
|
|
|
t
критическое одностороннее
|
1,658095243
|
|
|
P(T<=t)
двухстороннее
|
1,68183E-09
|
|
|
t
критическое двухстороннее
|
1,980624802
|
|
|
|
Контроль
|
В4
|
|
Среднее
|
0,866666667
|
0,256410256
|
|
Дисперсия
|
0,117514124
|
0,193140193
|
|
Наблюдения
|
60
|
78
|
|
Объединенная
дисперсия
|
0,160331825
|
|
|
Гипотетическая
разность средних
|
0
|
|
|
Df
|
136
|
|
|
t-статистика
|
8,875357701
|
|
|
P(T<=t)
одностороннее
|
1,78664E-15
|
|
|
t
критическое одностороннее
|
1,656135282
|
|
|
P(T<=t)
двухстороннее
|
3,57329E-15
|
|
|
t
критическое двухстороннее
|
1,977559805
|
|
|
|
Контроль
|
В10
|
|
1
|
2
|
3
|
|
Среднее
|
0,866666667
|
0,690909091
|
|
Дисперсия
|
0,117514124
|
0,217508418
|
|
Наблюдения
|
60
|
55
|
|
Объединенная
дисперсия
|
0,165299008
|
|
|
Гипотетическая
разность средних
|
0
|
|
|
df
|
113
|
|
|
t-статистика
|
2,315724978
|
|
|
P(T<=t)
одностороннее
|
0,011188803
|
|
|
t
критическое одностороннее
|
1,658449946
|
|
|
P(T<=t)
двухстороннее
|
0,022377605
|
|
|
t
критическое двухстороннее
|
1,981179594
|
|
|
|
Контроль
|
В12
|
|
Среднее
|
0,866666667
|
0,672413793
|
|
Дисперсия
|
0,117514124
|
0,224137931
|
|
Наблюдения
|
60
|
58
|
|
Объединенная
дисперсия
|
0,169906857
|
|
|
Гипотетическая
разность средних
|
0
|
|
|
Df
|
116
|
|
|
t-статистика
|
2,559237657
|
|
|
P(T<=t)
одностороннее
|
0,005888318
|
|
|
t
критическое одностороннее
|
1,658095243
|
|
|
P(T<=t)
двухстороннее
|
0,011776636
|
|
|
t
критическое двухстороннее
|
1,980624802
|
|
|
|
Контроль
|
Ц-3
|
|
Среднее
|
0,866666667
|
0,5
|
|
Дисперсия
|
0,117514124
|
0,255102041
|
|
Наблюдения
|
60
|
50
|
|
Объединенная
дисперсия
|
0,179938272
|
|
|
Гипотетическая
разность средних
|
0
|
|
|
Df
|
108
|
|
|
t-статистика
|
4,514128763
|
|
|
P(T<=t)
одностороннее
|
8,1373E-06
|
|
|
t
критическое одностороннее
|
1,659086593
|
|
|
P(T<=t)
двухстороннее
|
1,62746E-05
|
|
|
t
критическое двухстороннее
|
1,982170943
|
|
|
|
Контроль
|
Ц-2
|
|
1
|
2
|
3
|
|
Среднее
|
0,866666667
|
0,457627119
|
|
Дисперсия
|
0,117514124
|
0,252483928
|
|
Наблюдения
|
60
|
59
|
|
Объединенная
дисперсия
|
0,184422232
|
|
|
Гипотетическая
разность средних
|
0
|
|
|
Df
|
117
|
|
|
t-статистика
|
5,19501509
|
|
|
P(T<=t)
одностороннее
|
4,38138E-07
|
|
|
t
критическое одностороннее
|
1,657981556
|
|
|
P(T<=t)
двухстороннее
|
8,76276E-07
|
|
|
t
критическое двухстороннее
|
1,98044745
|
|
|
|
Контроль
|
Ц6
|
|
Среднее
|
0,866666667
|
0,626865672
|
|
Дисперсия
|
0,117514124
|
0,237449118
|
|
Наблюдения
|
60
|
67
|
|
Объединенная
дисперсия
|
0,180839801
|
|
|
Гипотетическая
разность средних
|
0
|
|
|
df
|
125
|
|
|
t-статистика
|
3,172598661
|
|
|
P(T<=t)
одностороннее
|
0,000950756
|
|
|
t
критическое одностороннее
|
1,657135726
|
|
|
P(T<=t)
двухстороннее
|
0,001901512
|
|
|
t
критическое двухстороннее
|
1,979124136
|
|
|
|
Контроль
|
Ц7
|
|
Среднее
|
0,866666667
|
0,38
|
|
Дисперсия
|
0,117514124
|
0,240408163
|
|
Наблюдения
|
60
|
50
|
|
Объединенная
дисперсия
|
0,173271605
|
|
|
Гипотетическая
разность средних
|
0
|
|
|
df
|
108
|
|
|
t-статистика
|
6,105653959
|
|
|
P(T<=t)
одностороннее
|
8,19804E-09
|
|
|
t
критическое одностороннее
|
1,659086593
|
|
|
P(T<=t)
двухстороннее
|
1,63961E-08
|
|
|
t
критическое двухстороннее
|
1,982170943
|
|
|
Контроль
|
Ц5
|
|
1
|
2
|
3
|
0,866666667
|
0,06779661
|
|
Дисперсия
|
0,117514124
|
0,064289889
|
|
Наблюдения
|
60
|
59
|
|
Объединенная
дисперсия
|
0,091129461
|
|
|
Гипотетическая
разность средних
|
0
|
|
|
df
|
117
|
|
|
t-статистика
|
14,43360758
|
|
|
P(T<=t)
одностороннее
|
4,77131E-28
|
|
|
t
критическое одностороннее
|
1,657981556
|
|
|
P(T<=t)
двухстороннее
|
9,54262E-28
|
|
|
t
критическое двухстороннее
|
1,98044745
|
|
|
Контроль
|
Ц4
|
|
Среднее
|
0,866666667
|
0
|
|
Дисперсия
|
0,117514124
|
0
|
|
Наблюдения
|
60
|
55
|
|
Объединенная
дисперсия
|
0,061356932
|
|
|
Гипотетическая
разность средних
|
0
|
|
|
Df
|
113
|
|
|
t-статистика
|
18,74253475
|
|
|
P(T<=t)
одностороннее
|
9,08849E-37
|
|
|
t
критическое одностороннее
|
1,658449946
|
|
|
P(T<=t)
двухстороннее
|
1,8177E-36
|
|
|
t
критическое двухстороннее
|
1,981179594
|
|
|
Контроль
|
Ц1
|
|
Среднее
|
0,866666667
|
0,7
|
|
Дисперсия
|
0,117514124
|
0,214285714
|
|
Наблюдения
|
60
|
50
|
|
Объединенная
дисперсия
|
0,161419753
|
|
|
Гипотетическая
разность средних
|
0
|
|
|
Df
|
108
|
|
|
t-статистика
|
2,166380287
|
|
|
P(T<=t)
одностороннее
|
0,016240314
|
|
|
t
критическое одностороннее
|
1,659086593
|
|
|
P(T<=t)
двухстороннее
|
0,032480628
|
|
|
t
критическое двухстороннее
|
1,982170943
|
|
|
|
Контроль
|
Ц8
|
|
1
|
2
|
3
|
|
Среднее
|
0,866666667
|
0,327272727
|
|
Дисперсия
|
0,117514124
|
0,224242424
|
|
Наблюдения
|
60
|
55
|
|
Объединенная
дисперсия
|
0,168517029
|
|
|
Гипотетическая
разность средних
|
0
|
|
|
Df
|
113
|
|
|
t-статистика
|
7,038696116
|
|
|
P(T<=t)
одностороннее
|
7,98657E-11
|
|
|
t
критическое одностороннее
|
1,658449946
|
|
|
P(T<=t)
двухстороннее
|
1,59731E-10
|
|
|
t
критическое двухстороннее
|
1,981179594
|
|
|
|
|
|
|
|